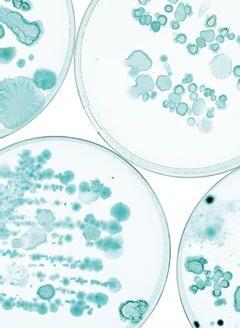
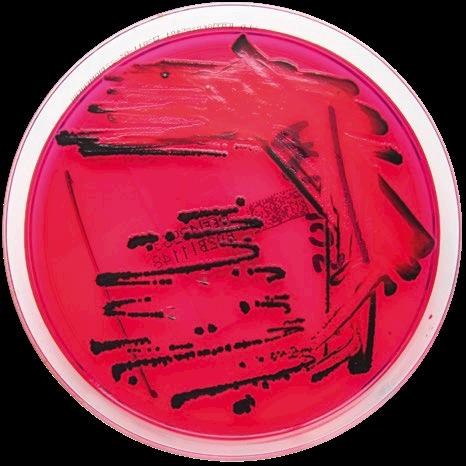
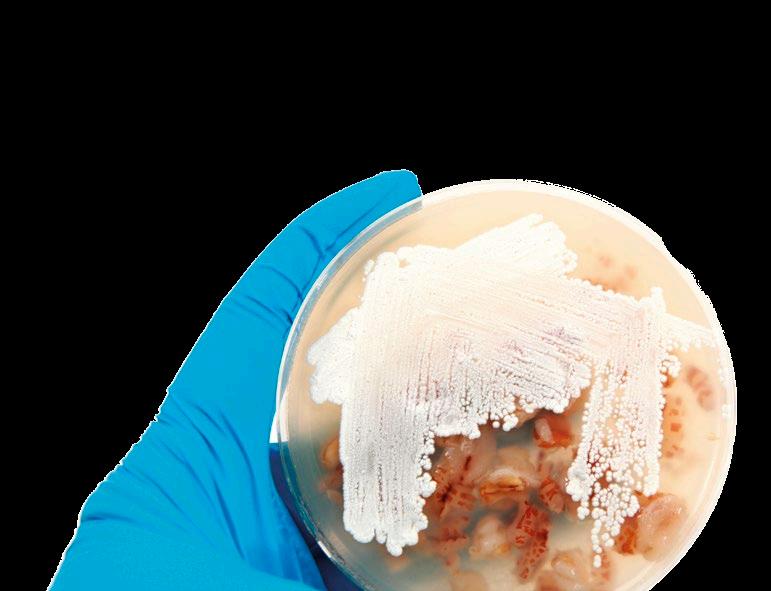

SÍNDROME DE INFLAMACIÓN Y NECROSIS PORCINA p. 6 Nº4 | Abril 2022

































TOLFEDOL 40 mg/ml Ácido Tolfenámico LA SOLUCIÓN DURADERA TOLFEDOL 40 mg/ml Ácido Tolfenámico LA SOLUCIÓN DURADERA Antiinflamatorio Antipirético Analgésico +INFO 300 mg/ml Paracetamol 30% ® SOLUCIÓN PARA ADMINISTRACIÓN EN AGUA DE BEBIDA La edad ya NO importa. El tiempo de espera SÍ.
+INFO
Sinfiebre Sinúlceras Sindolor
6/18
SÍNDROME DE INFLAMACIÓN Y NECROSIS PORCINA
Gerald Reiner
Dto. de Ciencias Clínicas Veterinarias, Clínica de Porcino, Universidad Justus-Liebig
20/35
MICOTOXINAS - ¿CÓMO AFECTAN AL SISTEMA INMUNITARIO PORCINO?
Panagiotis Tassis
Profesor Adjunto de Medicina y Reproducción Porcina, Clínica de Animales de Granja, Facultad de Medicina Veterinaria, Universidad Aristóteles de Tesalónica, Grecia
36/44
SALMONELOSIS PORCINA: LA INFECCIÓN EN LECHONES, ¿EL ESLABÓN OLVIDADO PARA SU CONTROL?
Raúl C. Mainar Jaime, María Bernad Roche y Alejandro Casanova Higes
Dpto. de Patología Animal, Facultad de Veterinaria, Instituto Agroalimentario de Aragón-IA2 (Universidad de Zaragoza-CITA), Zaragoza, España
46/58
USO RACIONAL DE ANTIMICROBIANOS EN PORCINO: ANTIMICROBIANOS QUE ACTÚAN INHIBIENDO LA SÍNTESIS DE PROTEÍNAS – PARTE I
Juan A. Gilabert, Sonia Rubio, Mª Dolores San Andrés y Manuel I. San Andrés
Sección Dptal. de Farmacología y Toxicología, Facultad de Veterinaria, Universidad Complutense de Madrid
61/65
EFECTO DE LA VACUNACIÓN INTRADÉRMICA SOBRE EL BIENESTAR DE LOS LECHONES
RESPUESTAS CONDUCTUALES DE LECHONES DE 26 DÍAS A LA VACUNACIÓN: COMPARACIÓN DE LA VÍA IM Y LA ID
A. Nalovic1, L. Daluzeau2, L. Eon2, T. Pinier2, S. Chouet2, D. Duivon2, Minervini S. 3, Scollo A.4,5, Bortoletto G. 3 , Romano G.4, Galli M.C. 5 y Gottardo F. 5
1Selas Epidalis
2MSD Santé Animale
3MSD Animal Health

4Swivet Research snc.
5Department of Animal Medicine, Production and Health, University of Padova. EVALUACIÓN CONDUCTUAL E INDICADORES DE ESTRÉS EN LECHONES DE TRES SEMANAS DE EDAD TRAS LA VACUNACIÓN INTRADÉRMICA O INTRAMUSCULAR
Minervini S.1, Scollo A. 2,3, Bortoletto G.1, Romano G. 2, Galli M.C. 3, Gottardo F. 3
1MSD Animal Health.
2Swivet Research snc.
3Department of Animal Medicine, Production and Health, University of Padova.
1 SUMARIO NO 4
66/72
74/84
NUEVAS HERRAMIENTAS DE DIAGNÓSTICO LABORATORIAL
Sofía Lázaro Gaspar y Gema Chacón Pérez Exopol S.L.
MÉTODO DE MUESTREO SENCILLO Y SEGURO PARA MONITORIZAR EL VIRUS DE LA PESTE PORCINA AFRICANA

Aleksandra Kosowska, Jose A. Barasona, Sandra Barroso-Arévalo, Belén Rivera, Lucas Domínguez y Jose M. Sánchez-Vizcaíno
Centro de Vigilancia Sanitaria VISAVET y Departamento de Sanidad Animal de la Facultad de Veterinaria, Universidad Complutense de Madrid
85/89
PCV-2: UN PEQUEÑO VIRUS - UNA GRAN AMENAZA
Florencia Correa Fiz Investigadora del Programa de Sanidad Animal del IRTA-CReSA
90/99
100/104
DETECCIÓN Y DIVERSIDAD GENÉTICA DE CORONAVIRUS PORCINOS IMPLICADOS EN BROTES DE DIARREA EN ESPAÑA
Héctor Puente, Héctor Argüello, Óscar Mencía-Ares, Manuel Gómez-García, Lucía Pérez-Pérez, Clara Vega, Pedro Rubio y Ana Carvajal
Departamento de Sanidad Animal, Universidad de León, España
BENEFICIOS PRODUCTIVOS Y RENTABILIDAD DE LA VACUNACIÓN ORAL DE LECHONES PARA HACER FRENTE A LA DPD CAUSADA POR E. COLI
Frédéric Vangroenweghe Elanco Benelux, Bélgica
Agradecemos a nuestros anunciantes por hacer posible la publicación de esta revista: Ceva, Elanco, Fatro, MSD Animal Health, Qualivet, S.P. Veterinaria, Syva, Tashia, Vetia, Vetoquinol y Zoetis.
Nº 4 | Abril 2022 2
PORCINO.INFO/PORCISAPIENS/
Hazlo fácil
Los protocolos de inseminación

requieren gran cantidad de recursos y esfuerzo y pueden ser una fuente importante de estrés en la granja. La inseminación es crucial, aunque es sólo una parte de tu trabajo. Relájate, ahorra tiempo y trabajo y reduce tu estrés gracias a la simplicidad de un protocolo de inseminación única a tiempo fijo (IAU-TF).
Ahorra tiempo y trabajo Reduce tu estrés Cronograma conocido
Simplemente fácil
FICHA TÉCNICA: OVUGEL 0,1 MG/ML GEL VAGINAL PARA CERDAS PARA LA REPRODUCCIÓN. Composición: Un ml contiene: Sustancia activa: Triptorelina (como acetato de triptorelina) 0,1 mg; Excipientes: Parahidroxibenzoato de metilo, sal de sodio 0,9 mg, Parahidroxibenzoato de propilo, sal de sodio 0,1 mg. Para la lista completa de excipientes, véase la sección 6.1. de la Ficha Técnica. Indicaciones de uso: Para la sincronización de la ovulación en cerdas destetadas a fin de permitir una única inseminación artificial en un momento determinado. Contraindicaciones: No usar en casos de hipersensibilidad a la sustancia activa o a algún excipiente. No usar durante la gestación ni la lactancia. No usar en cerdas con anomalías evidentes en el aparato reproductor. Precauciones especiales de uso. Advertencias especiales para cada especie de destino. La eficacia de OvuGel no se ha demostrado en cerdas jóvenes (cerdas nulíparas), por lo que no se recomienda el uso del medicamento veterinario en estos animales. La respuesta de las cerdas a los protocolos de sincronización puede verse influida por el estado fisiológico en el momento del tratamiento. Las respuestas al tratamiento no son uniformes ni entre las distintas piaras ni entre los individuos de una misma piara. Precauciones especiales para su uso en animales: El producto no debe utilizarse en cerdas con anomalías en el aparato reproductivo, infertilidad o trastornos médicos en general. Se realizó un estudio de seguridad de la reproducción en cerdas después de la administración de 3 veces la dosis recomendada de OvuGel, que no mostró ningún efecto en el rendimiento de la reproducción ni en los lechones. Sin embargo, no se ha demostrado la seguridad del tratamiento en cerdas en los ciclos reproductivos posteriores. No se pueden excluir los posibles efectos a largo plazo de la aparición de quistes. Precauciones específicas que debe tomar la persona que administre el medicamento veterinario a los animales: El producto puede causar irritación de los ojos. Las personas con hipersensibilidad conocida a los análogos de la GnRH o cualquiera de los excipientes (incluidos los parabenos) deben evitar todo contacto con el medicamento veterinario. Usar un equipo de protección personal consistente en un mono y guantes al manipular el medicamento veterinario. No comer, beber ni fumar al manipular el medicamento veterinario. Evitar el contacto directo con la piel o los ojos, lavarse las manos tras la manipulación del medicamento veterinario. En caso de contacto accidental con los ojos, enjuagar bien y buscar atención médica inmediatamente. En caso de contacto accidental con la piel, lavar las zonas contaminadas con agua y jabón. La triptorelina puede afectar a los ciclos reproductivos de las mujeres y se desconocen los efectos de la exposición accidental en mujeres embarazadas; por consiguiente, se recomienda que las mujeres embarazadas no manipulen el medicamento veterinario y que las mujeres fértiles lo hagan con precaución. Uso durante la gestación, la lactancia o la puesta. Gestación y lactancia: No ha quedado demostrada la seguridad del medicamento veterinario durante la gestación ni la lactancia. No usar durante la gestación ni la lactancia. Tiempo de espera: Carne: Cero días. Titular de la autorización de comercialización Vetoquinol S.A. Número de la autorización de comercialización: EU/2/20/260/001. USO VETERINARIO. MEDICAMENTO SUJETO A PRESCRIPCIÓN VETERINARIA. BAJO CONTROL O SUPERVISIÓN DEL VETERINARIO. Información del medicamento en: https://cimavet.aemps.es/cimavet


GA680-2
DESDE EL PRIMER DÍA DE VIDA
CONTROL DE PRRS DE ÚLTIMA GENERACIÓN

PROTEGE LECHONES, REPOSICIÓN Y CERDAS


Suvaxyn® PRRS MLV liofilizado y disolvente para suspensión inyectable para porcino. Composición: Cada dosis (2 ml) contiene: Virus PRRS vivo modificado, cepa 96V198: 102,2 – 105,2 DICC50*. ** Dosis infectiva en cultivo celular 50%. Indicaciones: Para la inmunización activa de cerdos clínicamente sanos a partir de 1 día de edad en un ambiente contaminado por el virus del síndrome respiratorio y reproductivo porcino (PRRS), para reducir la viremia y la excreción nasal causada por la infección con cepas europeas del virus PRRS (genotipo 1). Establecimiento de la inmunidad: 21 días después de la vacunación. Duración de la inmunidad: 26 semanas después de la vacunación. Cerdos de engorde: Además, la vacunación de lechones seronegativos de 1 día de edad demostró una reducción significativa de las lesiones pulmonares frente al desafío administrado 26 semanas después de la vacunación. La vacunación de lechones seronegativos de 2 semanas de edad demostró una reducción significativa de las lesiones pulmonares y excreción oral frente al desafío administrado a los 28 días y 16 semanas después de la vacunación. Cerdas nulíparas y adultas: Además, la vacunación antes de la gestación en cerdas nulíparas y adultas clínicamente sanas, tanto previamente expuestas al virus PRRS (es decir, bien inmunizadas frente al virus PRRS mediante vacunación, o expuestas al virus PRRS por infección de campo) como no expuestas anteriormente, demostró una reducción de la infección transplacentaria causada por el virus PRRS durante el último tercio de la gestación y reducción del impacto negativo asociado al rendimiento reproductivo (reducción de la incidencia de mortinatos, de la viremia de los lechones al nacimiento y al destete, de las lesiones pulmonares y de la carga viral en los pulmones de los lechones al destete). Contraindicaciones: No usar en explotaciones donde el virus PRRS europeo no haya sido detectado por métodos de diagnóstico fiables. No usar en verracos donantes de semen, puesto que el virus PRRS puede ser excretado en el semen. No usar durante la segunda mitad de la gestación en cerdas nulíparas y adultas gestantes si no han estado expuestas previamente al virus PRRS porque la cepa vacunal puede atravesar la placenta. La administración de la vacuna a cerdas nulíparas y adultas gestantes que no han estado previamente expuestas al virus PRRS durante la segunda mitad de la gestación puede afectar a su rendimiento reproductivo. Advertencias especiales para cada especie de destino: Vacunar únicamente animales sanos. Precauciones especiales para su uso en animales: Deben tomarse precauciones para evitar la introducción de la cepa vacunal en un área en la que no esté presente el virus PRRS. Los animales vacunados pueden excretar la cepa vacunal durante más de 16 semanas después de la vacunación. La cepa vacunal puede propagarse a cerdos en contacto. La vía de propagación más común es el contacto directo, pero no puede excluirse la propagación a través de objetos contaminados o por vía aérea. Deben adoptarse precauciones especiales para evitar la propagación de la cepa vacunal a animales no vacunados (p.ej.: cerdas nulíparas y adultas gestantes no expuestas previamente al virus PRRS en la segunda mitad de la gestación) que deben permanecer libres del virus PRRS. Se recomienda vacunar a todos los cerdos de una explotación a partir de la edad mínima recomendada. Los animales que no hayan tenido contacto con el virus PRRS, introducidos en la explotación (p.ej., cerdas nulíparas de reposición de lotes negativos para el virus PRRS) deben ser vacunados antes de la gestación. Puede utilizarse en cerdas nulíparas y en cerdas adultas antes de la cubrición no expuestas con anterioridad al virus PRRS o en la primera mitad de la gestación. Puede utilizarse en cerdas nulíparas y adultas expuestas con anterioridad al virus PRRS en la segunda mitad de la gestación. No ha quedado demostrada la seguridad de la vacuna durante la lactancia. Conservación: Conservar y transportar refrigerado (entre 2 °C y 8 °C). El disolvente puede ser conservado fuera de la nevera entre 15 °C – 25 ºC. No congelar. Proteger de la luz. Período de validez después de su reconstitución: uso inmediato. Eliminación: Todo medicamento veterinario no utilizado o los residuos derivados del mismo deberán eliminarse de conformidad con las normativas locales. Tiempo de espera: Cero días. Titular: Zoetis Belgium SA. Nº Registro: EU/2/17/215/001–003. Medicamento sujeto a prescripción veterinaria.


ESTABLECIMIENTO INMUNIDAD ahora también en cerdas
Los profesionales veterinarios han reivindicado incontables veces su derecho a ser reconocidos como lo que son, “Personal Sanitario”, y que sean incluidos en el Sistema Nacional de Salud.
A pesar de la enorme importancia que tiene la veterinaria para la Salud Pública y la Seguridad Alimentaria, sigue estando infravalorada por gran parte de la sociedad. Y es que, mientras que todo funciona correctamente, pocos se acuerdan del papel esencial que tienen los profesionales veterinarios como barrera de contención sanitaria, especialmente frente a las enfermedades zoonóticas que amenazan continuamente a nuestra salud.
No en vano, el concepto “One Health” no es algo nuevo en veterinaria, está arraigado en nuestras mentes desde el primer contacto con la carrera, está en nuestro ADN...

Es la base sobre la que se sustentan todas las acciones que llevan a cabo los profesionales veterinarios en sus respectivos ámbitos de actuación, desde la clínica diaria, pasando por la higiene e inspección de los alimentos, e incluso en el campo de la investigación, donde las contribuciones de la veterinaria han sido, y siguen siendo, determinantes para el avance de la ciencia.
Hemos hablado incontables veces sobre cómo la ciencia ha contribuido al avance del sector porcino, pero sería más apropiado hablar de la relación sinérgica entre la investigación científica, la profesión veterinaria y el sector porcino.
Es cierto que la ciencia ha marcado de forma indeleble el rumbo de la porcicultura moderna, pero la contribución de las Ciencias Veterinarias (especialmente en el ámbito de la especie porcina) al avance de otros campos de la investigación ajenos a la veterinaria es considerable.
Quizá el ejemplo más reconocido históricamente de la contribución de un veterinario al avance científico es el de Daniel E. Salmon que describió la primera Salmonella, una bacteria que aún hoy en día supone un verdadero quebradero de cabeza para la Salud Humana y Animal. Además, sus estudios condujeron al desarrollo de las denominadas “vacunas muertas” que, más adelante, sentarían las bases para la producción de vacunas frente a enfermedades devastadoras como el cólera o el tifus.
Volviendo a la actualidad, vemos que la especie porcina, más allá de aportar una fuente valiosísima de proteína de alta calidad y biodisponibilidad, puede ayudar a mejorar la Salud Humana de formas sorprendentes.
EDITORIAL
SIN VETERINARIA NO HAY FUTURO
porciS apiens
Como modelo biomédico, el cerdo está cada vez más presente en los estudios relacionados con la Salud Humana debido a su similitud fisiológica y anatómica con el ser humano. De hecho, la secuenciación del genoma del cerdo supuso un enorme avance para la Medicina Humana, ya que ha permitido ahondar en las mutaciones causantes de enfermedades como la enfermedad de Alzheimer, la diabetes e, incluso, la dislexia.
Una línea de investigación especialmente prometedora es la de los xenotrasplantes. El camino no está exento de obstáculos, siendo necesario que los órganos superen las barreras fisiológicas e inmunológicas (rechazo hiperagudo, agudo humoral y adaptativo, disfunción de la coagulación, rechazo crónico, inducción de tolerancia y riesgo de infección) que separan a ambas especies.
No obstante, en los últimos años hemos podido ver que cada vez estamos más cerca de poder obtener y trasplantar, con seguridad, órganos de cerdos en personas.
El caso más reciente, el trasplante de un corazón de cerdo a un paciente sin esperanza médica que sobrevivió durante 2 meses, ha supuesto un hito médico que llena de esperanza a miles de personas que anhelan la oportunidad de empezar una nueva vida con salud.
Solo el tiempo dirá si la producción porcina pasará de ser solo una fuente de alimento a un medio para salvar vidas. Lo que sí sabemos es que los veterinarios y el sector porcino estarán siempre dispuestos a contribuir en lo que puedan al avance de la ciencia por el bien de la humanidad.

EDITOR
GRUPO DE COMUNICACIÓN AGRINEWS S.L.
DISEÑO GRÁFICO & WEB
Marie Pelletier
Enrique Núñez Ayllón
Sergio Rodríguez
PUBLICIDAD
Laura Muñoz
+34 629 42 25 52 laura@mediatarsis.com
Luis Carrasco +34 605 09 05 13 lc@agrinews.es
REDACCIÓN
Daniela Morales
Osmayra Cabrera F.X. Mora
ADMINISTRACIÓN
Mercè Soler
Barcelona
España
Tel: +34 93 115 44 15 info@agrinews.es
www.porcino.info
www.porcino.info/porcisapiens/
Precio de suscripción anual:
España 45 €
Extranjero 120 €
ISSN (Revista impresa) 2696-8142
ISSN (Revista digital) 2696-8151
DIRIGIDA A VETERINARIOS DE PORCINO
Depósito Legal PorciSapiens B 7620-2021
Revista Cuatrimestral
5
SÍNDROME DE INFLAMACIÓN Y NECROSIS PORCINA
Descarga el PDF
S E
Gerald Reiner
Dto. de Ciencias Clínicas Veterinarias, Clínica de Porcino, Universidad Justus-Liebig
EEl Síndrome de Inflamación y Necrosis Porcina (SINS, del inglés Swine Inflammation and Necrosis Syndrome) se caracteriza por la presencia de signos clínicos de inflamación y necrosis en varios tejidos acrales (partes distales de las extremidades o salientes del cuerpo). Se ha descrito en lechones neonatos y destetados, así como en cerdos en fase de engorde.

Revisamos el estado actual de los conocimientos sobre el SINS, estableciendo una hipótesis sobre los mecanismos de desarrollo del síndrome y los posibles puntos de partida para afrontar esta patología.

PATOLOGÍA Nº 4 | Abril 2022 Síndrome de inflamación y necrosis porcina 6
EL PROBLEMA BÁSICO
La inflamación y la pérdida de la integridad de la cola pueden afectar gravemente al bienestar de los cerdos1,2, siendo una causa común de este fenómeno la caudofagia3,4. Existen numerosos factores que pueden actuar como desencadenantes de este comportamiento, entre ellos5:
Una actividad insuficiente y/o el aburrimiento debido a la falta de enriquecimiento ambiental.
La falta de satisfacción de los comportamientos naturales.
El estrés.
La mala calidad del aire, el exceso de luz solar y las temperaturas demasiado elevadas.
La mala calidad del pienso y el agua.
Los reagrupamientos.
Una densidad de alojamiento excesiva.
Una estructura inadecuada de los corrales.
Los enfrentamientos entre animales.
La imposibilidad de que todos los animales se alimenten al mismo tiempo.
Las enfermedades.
La desnutrición
La sangre como incentivo.
Los factores genéticos relativos a la agresividad y el umbral de tolerancia a la frustración de los animales también desempeñan un papel.
LA NATURALEZA CLARAMENTE MULTIFACTORIAL DE LA CAUDOFAGIA NO PUEDE ABORDARSE CENTRÁNDOSE EN COMPONENTES INDIVIDIALES⁶
Incluso con la mejora continua y costosa de los factores relacionados con el alojamiento y manejo mencionados, se producen daños en la cola en el 25-70% de los animales, con variaciones a nivel regional. Incluso en las condiciones extensivas al aire libre en Suiza, se han observado prevalencias del 14-20%⁷.
El interés particular por las lesiones de la cola surge no solo por su impacto directo en el bienestar de los animales, sino también porque el raboteo se sigue utilizando como principal medida preventiva contra las lesiones de la cola en la mayoría de los países.
Sin embargo, el corte de la cola provoca dolor, sufrimiento y daños sin resolver las causas subyacentes⁸.
A pesar de la creciente demanda de prohibición del corte de colas en la UE (Directiva 2008/120/ CE de la UE), las observaciones de campo y los estudios científicos han demostrado que, en la práctica, la abolición del raboteo en las condiciones actuales puede aumentar seriamente la prevalencia de las lesiones en la cola9
LEER Directiva
2008/120/CE de la UE
El principal aspecto a considerar con respecto al origen de las lesiones de la cola sigue siendo la caudofagia, pero cada vez más estudios y la experiencia práctica muestran claramente que la inflamación y la necrosis también pueden ocurrir sin la participación de otros cerdos10-18 , pudiendo afectar al 50% de las camadas y hasta el 75% de los lechones11
S
GENÉTICA 7
Por otro lado, no solo se ve afectada la cola, sino que también pueden verse afectadas otras partes del cuerpo, especialmente las orejas, los pezones, las pezuñas (rodetes coronarios, superficies plantares y talones), el ombligo, la vulva y la cara (Figura 1)13-18. En la mayoría de los lechones, los síntomas aparecen en varias partes del cuerpo al mismo tiempo.
La aparición simultánea en regiones corporales tan diferentes14,16, la evidencia de que estas lesiones pueden iniciarse antes del nacimiento cuando las mordeduras y los estímulos mecánicos (por ejemplo, desde el suelo) pueden excluirse definitivamente17 y la evidencia histopatológica de una reacción inflamatoria asociada a los vasos en las partes del cuerpo afectadas motivaron la adopción del término “Síndrome de Inflamación y Necrosis Porcina” (SINS)14
La importancia de considerar este nuevo síndrome radica en la constatación de que las lesiones de la cola no son únicamente consecuencia de la agresividad y el aburrimiento y, por tanto, no pueden controlarse únicamente a través del enriquecimiento ambiental.
FIGURA 1
Algunos signos típicos del SINS: A: Cara, 0 = sana, 1= inflamación y pérdida de cerdas (SINS); B: Orejas, 0 = sanas, 1 = fisuras, pérdida de cerdas (SINS); C: Cola, 0 = sana, 1 = pérdida de cerdas, inflamación, enrojecimiento, exudación y fisuras (SINS); D: Talones, 0 = sanos, 1 = inflamación, sangrado (SINS; E: Rodetes coronarios con signos de inflamación (Fotos cedidas por Mirjam Lechner).
Más bien, se observa una asociación compleja de una amplia gama de síntomas inflamatorios y de necrosis acompañado de un metabolismo comprometido de los animales. Se pueden detectar influencias genéticas significativas del verraco y de la cerda en la susceptibilidad de la descendencia en todo el genoma del cerdo que podrían ayudar en la selección en contra del síndrome.

PATOLOGÍA Nº 4 | Abril 2022 Síndrome de inflamación y necrosis porcina 8
Esto lleva a sospechar que el SINS es un efecto secundario de décadas de selección genética intensiva y extremadamente exitosa a favor de la carnosidad, el crecimiento y la fertilidad sobre la base de rasgos externos (relación carne:grasa, ganancia diaria y número de lechones), sin tener en cuenta el cambio en la regulación genética que esto inevitablemente conlleva.

El objetivo de esta revisión es resumir los conocimientos actuales sobre el SINS, establecer una hipótesis sobre los mecanismos de desarrollo del síndrome y, a partir de ahí, presentar los puntos de partida para abordar la enfermedad. Se puede encontrar una visión detallada en (Reiner, Kuehling, Loewenstein, Lechner & Becker, 2021) 19 .
DEFINIENDO EL SÍNDROME DE INFLAMACIÓN Y NECROSIS PORCINA
El SINS se caracteriza por la presencia de signos clínicos de inflamación y necrosis en varios tejidos acrales. Se ha descrito en lechones neonatos y destetados, así como en cerdos en fase de engorde13-17. Los primeros signos son:
La pérdida de cerdas en la base de la cola y en las orejas.
El enrojecimiento de los talones.
La inflamación de la base de la cola, la cola y los pezones.
La inflamación de los rodetes coronarios.
LA INFLAMACIÓN COMO CAUSA DE LA PÉRDIDA
DE CERDAS SE HA PODIDO COMPROBAR
HISTOPATOLÓGICAMENTE
Estos signos más leves del SINS pueden pasar desapercibidos, pero tienen un gran potencial de diagnóstico porque se pueden adoptar medidas correctivas antes de que se produzcan daños más graves como la hemorragia, la exudación y la necrosis.
GENÉTICA 9
LOS
LOS SIGNOS DEL SINS PUEDEN DETECTARSE AL NACIMIENTO 16
SIGNOS DEL SINS PUEDEN DETECTARSE AL NACIMIENTO16
En los lechones recién nacidos se han encontrado evidencias histopatológicas de inflamación endógena que tardan, al menos, 4-7 días en desarrollarse. Además, entre el 30% y el 80% de los recién nacidos presentan pérdida de cerdas, así como enrojecimiento e hinchazón en la base de la cola, los pezones, la pared de las pezuñas, los rodetes coronarios y los talones.
Los síntomas aumentan en cuanto a prevalencia y gravedad desde la lactación hasta el destete, momento en el que muchos animales se ven afectados por fenómenos de exudación y necrosis. En la fase de engorde, los síntomas vuelven a disminuir o se ven acentuados por las condiciones ambientales.
Existe una clara conexión con los problemas de producción, por ejemplo, las condiciones desfavorables del suelo, que se vuelven más importantes con la edad de los animales.
Tomando como ejemplo los talones y las pezuñas, cuanto más gravemente afectados estén los tejidos por el SINS, más sensiblemente reaccionarán a las condiciones desfavorables del suelo, y viceversa.
Las orejas se ven especialmente afectadas cuando la termorregulación de los animales no funciona correctamente debido a una falta de capacidad de refrigeración.

Ello conduce a que la circulación sanguínea de las orejas sea más intensa para favorecer la refrigeración y, por ende, tienen un aporte sanguíneo más fuerte. Esto explica la marcada variación de los síntomas en las distintas granjas y por qué no todas las partes del cuerpo se ven afectadas al mismo tiempo18
En una cohorte de 646 lechones, el 40% estaba afectado en al menos 5 de las 7 partes del cuerpo estudiadas:
Base de la cola
Punta de la cola
Cara
Orejas
Pezones
Ombligo
Pezuñas
Los signos del SINS son relativamente fáciles de diagnosticar clínicamente si se limpian previamente las zonas afectadas de los animales, aunque se necesita algo de experiencia a la hora de puntuar las lesiones.
Las partes del cuerpo se fotografían para permitir la evaluación con una alta repetibilidad de los resultados y un bajo estrés en los lechones16,17 En la Figura 1 se muestran algunos ejemplos de signos de SINS.
PATOLOGÍA Nº 4 | Abril 2022 Síndrome de inflamación y necrosis porcina 10
EL SINS ES UNA ENFERMEDAD ENDÓGENA
Tres observaciones clave apoyan la hipótesis de que el SINS es principalmente un trastorno endógeno, aunque puede ser modificado por tecnopatías y otros factores de estrés mecánico. Estas observaciones son:
La aparición simultánea en partes del cuerpo tan diversas como la cola, los pezones y las pezuñas14,16,17
La evidencia de que el SINS puede aparecer antes del nacimiento16
La evidencia de que la inflamación originada en los vasos sanguíneos puede estar presente antes del nacimiento en lechones con la epidermis aún intacta, cuando se excluyen los mordiscos y la irritación mecánica (por ejemplo, asociado a un suelo inadecuado)15,16
Los signos clínicos de inflamación en la cola, las pezuñas y las orejas se han confirmado histopatológicamente, documentándose fenómenos de vasculitis, trombosis, proliferación de la íntima, edema e hiperemia con la epidermis intacta15.
En una granja convencional, entre el 40% y el 80% de los lechones recién nacidos presentaban hemorragias en la pared de las pezuñas, inflamación del rodete coronario, enrojecimiento de los talones, pérdida de cerdas y enrojecimiento de la cola y las orejas16
La inflamación se caracterizó por la presencia de granulocitos, macrófagos y linfocitos, lo que indica un inicio de la inflamación al menos 4 días antes del nacimiento.
Penny et al.10 ya sospechaban que la inflamación y la necrosis son el resultado de alteraciones circulatorias desencadenadas por la vasoconstricción y agravadas por otras circunstancias. Esta hipótesis fue confirmada por los hallazgos mencionados de vasculitis, proliferación de la íntima y formación de trombos en la zona de la base de la cola inflamada, signos directamente relacionados con las lesiones clínicas16

LA ALTERACIÓN CIRCULATORIA RESULTANTE PUEDE CONFIRMARSE CLÍNICAMENTE MEDIANTE TERMOGRAFÍA INFRARROJA13
La inflamación de la punta de la cola (al margen de los eventos de caudofagia) siempre se ve acompañada de cambios en la base de la cola, mientras que los lechones con la base de la cola intacta nunca muestran signos en la punta de la cola15,16
UNA PROPORCIÓN CONSIDERABLE DE LECHONES NEONATOS PUEDE VERSE AFECTADA UNA PROPORCIÓN CONSIDERABLE DE LECHONES NEONATOS PUEDE VERSE AFECTADA
GENÉTICA 11
HIPÓTESIS Y FUNDAMENTOS DE LA PATOGÉNESIS DEL SINS
Basándose en los hallazgos histopatológicos y en los datos de la termografía infrarroja, Reiner et al.15 , Ringseis et al.18 y otros propusieron que el SINS debe originarse en procesos inflamatorios locales asociados a los vasos sanguíneos.
Las endotoxinas (LPS) y otros productos de degradación bacteriana (MAMPs, del inglés Microbiome Associated Molecular Patterns) podrían desempeñar un papel decisivo20-23. Si estos componentes microbianos pasan a la circulación sanguínea, son reconocidos por las propias defensas del organismo y combatidos a través de las vías inflamatorias (resumen en la Figura 219).
Con el fin de atraer gran cantidad de factores defensivos y células inflamatorias hacia el tejido supuestamente infectado por bacterias, los capilares sanguíneos se dilatan y se vuelven permeables. Esto hace que la presión sanguínea descienda, la sangre se detenga y se active la coagulación. De este modo, se reduce o incluso se interrumpe el suministro de sangre a los tejidos irrigados. El resultado final es la destrucción de estos tejidos por necrosis Todos estos cambios inflamatorios en los vasos sanguíneos, incluida su obstrucción con trombos, se han demostrado histopatológicamente en los cerdos afectados por el SINS16.
FIGURA2
Hipótesis de la patogénesis del SINS (adaptado de Reiner et al., 202119). La atención se centra en los MAMPs (flecha roja). El suministro de agua, la termorregulación y la calidad de los alimentos y el agua subóptimos, junto con las micotoxinas, las enfermedades infecciosas, la mala ventilación y otros factores estresantes (recuadros blancos), aumentan la afluencia de MAMPs (incluidos los LPS) a los lugares de proliferación excesiva de la microbiota intestinal e incrementan la permeabilidad de la barrera intestinal, el hígado y el sistema circulatorio (recuadros verdes). Esto desencadena respuestas inflamatorias en el intestino, el hígado, los endotelios y el SNC (recuadros grises). Las consecuencias pueden ser múltiples. Entre otras (recuadros azules), se pueden producir mordeduras de cola, reducción del rendimiento, Síndrome de Disgalaxia Postparto en cerdas, cambios metabólicos y SINS. SNC: sistema nervioso central; DON: deoxinivalenol; IL: interleucinas; LPS: lipopolisacáridos; PG: prostaglandinas; TNF: factor de necrosis tumoral; SDP: Síndrome de Disgalaxia Postparto.

PATOLOGÍA Nº 4 | Abril 2022 Síndrome de inflamación y necrosis porcina 12
Bebederos de chupete, bloqueos, altura…
Suelo de slat de cemento
Suelo de slat de plástico
↓Perfusión intestinal
Suministro de agua subóptimo
Estreñimiento/ Coprostasis
Calidad del pienso
· ↑ Proteína
· ↑ Almidón
· ↓ Fibra
Entorno favorable para la microbiota Producción excesiva de MAMPs
Calidad del agua subóptima (ej.: Biofilm, LPS) Calor Estrés Alteración de la termorregulación
↓Perfusión & ↓ O2
Barrera intestinal: “Intestino Permeable”
Micotoxinas (ej.: DON)
Factores estresantes generales Sobrecarga de Activación y Detoxificación en el hígado
Nervio vago
Activación de receptores, TNFα, IL, prostaglandinas (PG)
Comportamiento de enfermedad
Inapetencia Catabolismo Fiebre
Activación de macrófagos, TNFα, IL, prostaglandinas (PG)
Circulación MAMPs
Cambio metabólico (proteínas de fase aguda)
Inflamación (catabolismo y alteración de la coagulación)
Enfermedades infecciosas (pulmones, intestino, vejiga)
Mala ventilación (amoniaco, CO2, polvo, LPS)
Caudofagia
↓Rendimiento SDP
Endotelios de partes distales del cuerpo (cola, orejas, pezones, pezuñas, etc.)
Activación de macrófagos, TNFα, IL, prostaglandinas (PG) e Inflamación:
· Vasculitis
· Trombosis
· Proliferación de la íntima
· Edema, hiperemia
SINS
· Pérdida de cerdas
· Inflamación/ hinchazón y enrojecimiento
· Exudación y necrosis
· Hemorragias
SNC
GENÉTICA 13
¿DE DÓNDE PROCEDEN LOS PRODUCTOS DE DEGRADACIÓN BACTERIANA?
El intestino es una fuente importante de MAMPs24, pero en condiciones fisiológicas, las endotoxinas pasan del tracto intestinal al hígado, donde son inactivadas. Sin embargo, si se producen demasiados productos microbianos de este tipo en el intestino o si la barrera hematointestinal está sobrecargada, puede haber una fuga excesiva de estos productos. Además, si el hígado ya no es capaz de detoxificarlos, pasan a la circulación sistémica, desencadenando las inflamaciones descritas.
La disbiosis de la microbiota y el deterioro de la barrera intestinal también se asocian a una serie de inflamaciones crónicas y enfermedades sistémicas en humanos, y la implicación patogénica de las endotoxinas está bien descrita31,32
AGUA, ALIMENTO & TERMORREGULACIÓN ESTRÉS POR CALOR
AGUA, ALIMENTO & TERMORREGULACIÓN ESTRÉS POR CALOR
La producción excesiva de MAMPs se puede ver exacerbada por un suministro de agua subóptimo o por la incapacidad para la termorregulación.
Ambos procesos conducen a una relativa falta de agua, lo que se intenta compensar con una reducción del flujo sanguíneo intestinal, conduciendo a un espesamiento del quimo (coprostasis) y una multiplicación descontrolada de las bacterias
La alimentación con demasiada proteína y almidón, y con muy poca fibra bruta, también favorece la proliferación bacteriana excesiva y la producción de MAMPs, ya que el entorno intestinal y la microbiota cambian.

La acumulación de calor en condiciones de una termorregulación alterada y la reducción del flujo sanguíneo intestinal conducen simultáneamente a una sobrecarga de la barrera hematointestinal dando lugar a lo que se conoce como "intestino permeable", permitiendo el paso de demasiados MAMPs.
EN LOS CERDOS, LOS DAÑOS EN LA BARRERA INTESTINAL CONDUCEN
DIRECTAMENTE A UNA MAYOR TRANSLOCACIÓN
DE LPS 25
La barrera hematointestinal de los cerdos es especialmente susceptible al estrés por calor26-28, observándose una reducción de la perfusión intestinal con una relativa deficiencia de agua y un aumento de las necesidades de agua para la termorregulación27,28, especialmente en condiciones en las que falla la refrigeración en naves con suelos secos de hormigón o plástico.

MICOTOXINAS
MICOTOXINAS
Las micotoxinas (DON y sustancias similares) alteran la barrera intestinal de los cerdos, aumentan la absorción de LPS y provocan inflamación intestinal y hepática29-30
En este sentido, las micotoxinas y los LPS pueden actuar sinérgicamente, favoreciendo su absorción mutua.
PATOLOGÍA Nº 4 | Abril 2022 Síndrome de inflamación y necrosis porcina 14
INFLAMACIÓN HEPÁTICA
INFLAMACIÓN HEPÁTICA
El hígado actúa como barrera fundamental para el organismo, degradando los MAMPs (LPS y otros) y evitando que entren en la circulación sistémica donde en cantidades elevadas provocarían la muerte por shock .
Sin embargo, cuando se produce una proliferación microbiana excesiva en el intestino o cuando hay una alteración de la barrera intestinal (“leaky gut” ), el hígado tiene que procesar altas concentraciones de MAMPs que no puede eliminar por completo, lo que provoca inflamación hepática y deterioro de su función orgánica33
EN CONSECUENCIA, EL HÍGADO PASA DE UN METABOLISMO ANABÓLICO A UN METABOLISMO
INFLAMATORIO Y DE FASE AGUDA
Las primeras evidencias que apuntaban a la inducción de procesos inflamatorios en el hígado de lechones con SINS y a los cambios en el metabolismo fueron aportadas por Ringseis et al.18 y Löwenstein et al.34
Encontraron un mayor nivel de proteínas de fase aguda en los lechones con SINS. Entre ellos, el TNF-α , un mediador clave de la inflamación, estaba elevado en el tejido hepático de los lechones con SINS18
Un resumen detallado de cómo la inflamación ocurre como consecuencia de problemas asociados a las bacterias intestinales, a la barrera intestinal, al entorno de alojamiento y a la higiene, a la activación inmunitaria, a las micotoxinas, al estrés psicológico, al estado nutricional y a la composición de los piensos puede encontrarse en Nordgreen et al.35 .
LEER ARTÍCULO: Nordgreen, J.; Edwards, S.A.; Boyle, L.A.; Bolhuis, J.E.; Veit, C.; Sayyari, A.; Marin, D.E.; Dimitrov, I.; Janczak, A.M.; Valros, A. A proposed role for proinflammatory cytokines in damaging behavior in pigs. Front. Vet. Sci. 2020, 7, 646.
ALTERACIÓN DEL COMPORTAMIENTO
ALTERACIÓN DEL COMPORTAMIENTO
Los procesos inflamatorios locales no permanecen ocultos al sistema nervioso central. Éste reacciona cambiando a un metabolismo catabólico, observándose una falta de apetito y un comportamiento de enfermedad con el objetivo de ahorrar energía para la defensa del organismo y privar de nutrientes a las bacterias intestinales.
SE HA DEMOSTRADO QUE EL COMPORTAMIENTO DE ENFERMEDAD, DESENCADENADO POR
MAMPs COMO EL LPS, LLEVA A LA CAUDOFAGIA 35
GENÉTICA 15
INFLUENCIA DE LA GENÉTICA
IMPACTO DEL VERRACO IMPACTO DEL VERRACO
Durante años, los ganaderos han observado una asociación entre la presencia de SINS en sus lechones y determinados verracos.
Para esclarecer científicamente las posibles correlaciones, se han estudiado verracos cuya descendencia resultaba ser más susceptible al SINS y verracos cuya descendencia resultaba ser especialmente resistente, inseminando a cerdas individuales con semen mixto de ambos perfiles de verracos. De este modo, los lechones nacían en la misma camada, eliminándose en gran medida los efectos ambientales no sistemáticos.
Hasta ahora se han examinado un total de 4 verracos Duroc y 15 verracos Pietrain de 8 empresas de genética17 y obteniéndose aproximadamente 650 lechones a partir de 39 cerdas de genética homogénea. Los resultados fueron sorprendentes:
La descendencia de los verracos Duroc apenas mostraba síntomas de SINS (proporciones acumuladas de inflamación y necrosis: 43%) y estaba significativamente menos afectada que la descendencia de los verracos Pietrain (proporciones acumuladas de inflamación y necrosis: 165%).
Dentro de la raza Pietrain, pudieron identificarse verracos con una progenie especialmente susceptible (proporciones acumuladas de inflamación y necrosis: 200%) y verracos cuya progenie presentaba grados de SINS similares (proporciones acumuladas de inflamación y necrosis: 62%) a los de la progenie Duroc. La asignación de los verracos no fue aleatoria sino altamente repetible. Los grados más altos de SINS con exudación y necrosis sólo se observaron en la descendencia de los verracos Pietrain de calidad media (4,4%) y baja (20,1%), pero no en la descendencia de los verracos Duroc ni en los descendientes de los mejores verracos Pietrain.
Los resultados muestran claramente que había verracos con una distribución favorable y desfavorable para el desarrollo del SINS en la descendencia en las distintas explotaciones analizadas. Se puede suponer que la expresión del SINS está significativamente influenciada por el manejo y la alimentación y que las diferencias absolutas entre los verracos son más débiles o más fuertes en condiciones más o menos favorables.
Por supuesto, no se pueden esperar diferencias genéticas entre todos los verracos, cerdas o líneas genéticas. Sin embargo, los resultados concluyentes del estudio fueron la clara diferenciación entre los verracos Duroc y Pietrain y la pronunciada variación dentro de los verracos Pietrain incluidos en el estudio. Estos resultados están siendo tomados en serio por numerosas empresas de genética en varios países.
La conclusión de estos estudios es que los verracos pueden seleccionarse de forma fiable basándose en los resultados de desarrollo del SINS en su progenie.
DETERMINADA
ESTOS RESULTADOS CONFIRMAN LA EXISTENCIA DE EFECTOS GENÉTICOS SIGNIFICATIVOS SOBRE LA PROBABILIDAD DE APARICIÓN DE SINS EN UNA GANADERÍA
PATOLOGÍA Nº 4 | Abril 2022 Síndrome de inflamación y necrosis porcina 16
IMPACTO DE LA CERDA IMPACTO DE LA CERDA
La genética de la cerda también puede desempeñar un papel importante en el desarrollo del SINS de su progenie.
En un ensayo con más de 20.000 cerdos de diferentes edades, se demostró que una de las cuatro líneas de cerdas utilizadas estaba dos veces más predispuesta a desarrollar SINS que las otras tres14
Esto era cierto, tanto para las alteraciones en la cola como en las orejas (las demás partes del cuerpo no se puntuaron debido al elevado número de animales).
Al mismo tiempo, en la descendencia de esta línea de cerdas se observó una incidencia significativamente más baja de caudofagia que en las otras tres líneas. 1 2
Estas evidencias son un claro indicio de la naturaleza sindrómica del SINS y de que la caudofagia y el SINS son fundamentalmente dos problemas diferentes, aunque puedan aparecer simultáneamente.
OPORTUNIDADES PARA MEJORAR EL SINS A TRAVÉS DE LAS CONDICIONES AMBIENTALES
En general, se considera que mejorar el suministro de agua y fibra bruta tiene un impacto positivo en la salud intestinal y en la mejora del bienestar de los cerdos³. Por ello, en un estudio a gran escala15, se evaluó:
Si el SINS puede mejorarse dando un buen aporte de fibra bruta y ofreciendo agua higienizada (=mejoras zootécnicas).
Si la proporción de lechones con SINS puede reducirse en cerdas sin lesiones en la piel, pezones y pezuñas en comparación con otras cerdas (=calidad de la cerda).
ES
Las mejoras zootécnicas se llevaron a cabo en todas las etapas, desde las cerdas reproductoras hasta los cerdos de engorde. La prevalencia del SINS mejoró significativamente en todas las edades.
En los lechones lactantes, lechones destetados y cerdos de engorde, la mejora de las condiciones de manejo se tradujo en una reducción del SINS en un 40%, 60% y 80%, respectivamente.
La calidad de la cerda también resultó tener un efecto significativo en la incidencia del SINS desde los lechones hasta el engorde.
El efecto más llamativo estuvo relacionado con la coprostasis de la cerda que se produjo exclusivamente en condiciones de alojamiento estándar, sin mejorar el suministro de agua y fibra, y con mayor frecuencia en cerdas con peor calidad de piel, pezuñas y pezones.
PIEL INTACTA ES FUNDAMENTAL PARA COMBATIR EL SINS15
EVIDENTE QUE EL SUMINISTRO DE FIBRA, AGUA HIGIENIZADA PROCEDENTE DE BEBEDEROS ADECUADOS Y CERDAS CON PEZUÑAS Y PEZONES SANOS, Y
GENÉTICA 17
CONCLUSIONES
Para controlar las lesiones de la cola y mejorar el bienestar de los animales, fijarse sólo en el comportamiento de caudofagia es insuficiente. Ahora sabemos que las lesiones de la cola ocurren en un grado considerable, incluso sin la intervención de otros cerdos.
Además, la inflamación y la necrosis observadas afectan hasta el 75% de los lechones, encontrándose en numerosas partes del cuerpo y pudiendo estar ya presentes antes del nacimiento cuando aún no es posible la lesión mecánica, por lo que se atribuyen a causas endógenas asociadas a los vasos sanguíneos. La inflamación y la necrosis están documentadas histopatológicamente, denominándose con el término "Síndrome de Inflamación y Necrosis Porcina" (SINS).
EL SINS ES UNA PATOLOGÍA MULTIFACTORIAL QUE AFECTA A
LOS CERDOS
Numerosos factores están relacionados con el desarrollo del SINS, como las instalaciones, la alimentación y el manejo, una termorregulación y un suministro de agua inadecuados, una alimentación con exceso de proteína y almidón y escaso aporte de fibra bruta y la contaminación por micotoxinas, entre otros. Son como 40 cajas apiladas unas encima de otras. ¡Retirar una sola es inútil, la pila seguirá cayendo!
El control del SINS, al igual que ocurre con la caudofagia, debe tener en cuenta muchos factores al mismo tiempo. Estos factores incluyen la genética del verraco y de la cerda, dado que ambos tienen una gran influencia en la incidencia del SINS en su descendencia. No basta con mejorar las condiciones ambientales si la genética no es la adecuada, y la mejor genética será ineficaz en un contexto de alojamiento, alimentación y manejo inadecuados.
BIBLIOGRAFÍA
1. EFSA Panel on Animal Health and Welfare (AHAW). Statement on the use of animal ‐based measures to assess the welfare of animals. EFSA J. 2012, 10, 2767.
2. EFSA Panel on Animal Health and Welfare (AHAW). Scientific Opinion concerning a multifactorial approach on the use of animal and non ‐animal ‐based measures to assess the welfare of pigs. EFSA J. 2014, 12, 3702.
3.Nannoni, E.; Sardi, L.; Vitali, M.; Trevisi, E.; Ferrari, A.; Barone, F.; Bacci, M.L.; Barbieri, S.; Martelli, G. Effects of different enrichment devices on some welfare indicators of post ‐weaned undocked piglets. Appl. Anim. Behav. Sci. 2016, 184, 25–34.
4. Thodberg, K.; Herskin, M.S.; Jensen, T.; Jensen, K.H. The effect of docking length on the risk of tail biting, tail directed behaviour, aggression and activity level of growing pigs kept under commercial conditions. Animal 2018, 12, 2609–2618.
5. Kallio, P.A.; Janczak, A.M.; Valros, A.E.; Edwards, S.A.; Heinonen, M. Case control study on environmental, nutritional and management ‐based risk factors for tai l‐biting in long ‐tailed pigs. Anim. Welf. 2018, 27, 21–34, doi:10.7120/09627286.27.1.021.
6. Breuer, K.; Sutcliffe, M.E.M.; Mercer, J.T.; Rance, K.A.; Beattie, V.E.; Sneddon, I.A.; Edwards, S.A. The effect of breed on the development of adverse social behaviours in pigs. Appl. Anim. Behav. Sci. 2003, 84, 59–74, doi:10.1016/ S0168 ‐1591(03)00147‐3.
7. Walker, P.; Bilkei, G. Tail ‐biting in outdoor pig production. Vet. J. 2006, 171, 367–369.
8. EFSA. Scientific opinion of the Panel on Animal Health and Welfare on a request from Commission on the risks associated with tail biting in pigs and possible means to reduce the need for tail docking considering the different housing and husbandry systems. EFSA J. 2007, 161, 1–13.
9. Valros, A.; Ahlstrom, S.; Rintala, H.; Hakkinen, T.; Saloniemi, H. The prevalence of tail damage in slaughter pigs in Finland and associations to carcass condemnations. Acta Agric. Scand. Sect. A Anim. Sci. 2004, 54, 213–219, doi:10.1080/09064700510009234.
10. Penny, R.H.C.; Edwards, M.J.; Mulley, R. Clinical observations of necrosis of skin of suckling piglets. Aust. Vet. J. 1971, 47, 529–537.
11. Blowey, R.; Done, S.H. Tail necrosis in pigs. Pig, J. 2003, 51, 155–163.
12. Santi, M.; Gheller, N.B.; Mores, T.J.; Marques, B.M.; Gonçalves, M.A.; Gava, D.; Zlotowski, P.; Driemeier, D.; Barcellos, D.E. Tail Necrosis in Piglets—Case Report. Available online: http://hdl.handle.net/11299/155093 (accessed on 15 November 2018).
13. Reiner, G.; Lechner, M. Inflammation and necrosis syndrome (SINS) in swine. CAB Rev. 2019, 14, 1–8.
14. Reiner, G.; Lechner, M.; Eisenack, A.; Kallenbach, K.; Rau, K.; Müller, S.; Fink‐ Gremmels, J. Prevalence of an inflammation and necrosis syndrome in suckling piglets. Animal 2019, 13, 2007–2017.
15. Reiner, G.; Kuehling, J.; Lechner, M.; Schrade, H.J.; Saltzmann, J.; Muelling, C.; Daenicke, S.; Loewenstein, F. Inflammation and Necrosis Syndrome is influenced by husbandry and quality of sow in suckling piglets, weaners and fattening pigs. Porc. Health Manag. 2020, 6, 32.
16. Kuehling, J.; Loewenstein, F.; Wenisch, S.; Kressin, M.; Herden, C.; Lechner, M.; Reiner, G. An in ‐ depth diagnostic exploration of an inflammation and necrosis syndrome in a population of newborn piglets. Animal 2021, 15, 100078.
17. Kuehling, J.; Eisenhofer, K.; Lechner, M.; Becker, S.; Willems, H.; Reiner, G. The effects of boar on susceptibility to swine inflammation and necrosis syndrome in piglets. Porc. Health Manag. 2021, 7, 15.
18. Ringseis, R.; Gessner, D.; Löwenstein, F.; Kuehling, J.; Becker, S.; Willems, H.; Lechner, M.; Eder, K.; Reiner, G. Swine inflammation and necrosis syndrome is associated with plasma metabolites and liver transcriptome in affected piglets. Animals 2021, 11, 772, doi:10.3390/ani11030772.
19. Reiner, G.; Kuehling, J.; Loewenstein, F.; Lechner, M.; Becker, S. Swine Inflammation and Necrosis Syndrome (SINS). Animals 2021, 11, 1670.
20. Schrauwen, E.; Thoonen, H.; Hoorens, J.; Houvenaghel, A. Pathophysiological effects of endotoxin infusion in young piglets. Br. Vet. J. 1986, 142, 364–370.
21. Jadamus, A.; Schneider, D. Long ‐term effect of fusariotoxins on the reproduction performance of sows testing the effectiveness of detoxifying feed additives 700. Feed Mag. 2002, 10, 396–405.
22. Busch, M.E.; Jensen, I.M.; Korsgaard, J. Development and consequences of ear necrosis in a weaner herd and two growingfinishing herds. In Proceedings of the 21st International Pig Veterinary Society Congress, Vancouver, BC, Canada, 18–21 July 2010; p. 45.
23. Guillou, D.; Demey, V.; Chacheyras ‐Durand, F.; Le Treut, Y. Mise en evidence du transfer des endotoxines de la truie vers sa portée dans le context du syndrome de dysgalactie post ‐partum. J. Rech. Porc. 2013, 45, 269–270.
24. Van Limbergen, T.; Devreese, M.; Croubels, S.; Broekaert, N.; Michiels, A.; DeSaeger, S.; Maes, D. Role of mycotoxins in herds with and without problems with tail necrosis in neonatal pigs. Vet. Rec.
2017, 181, 539.
25. Sanz Fernandez, M.V.; Stoakes, S.K.; Abuajamieh, M.; Seibert, J.T.; Johnson, J.S.; Horst, E.A.; Rhoads, R.P.; Baumgard, L.H. Heat stress increases insulin sensitivity in pigs. Physiol. Reprod. 2015, 3, e1247.
26. Pearce, S.C.; Mani, V.; Boddicker, R.L.; Johnson, J.S.; Weber, T.E.; Ross, J.W.; Baumgard, L.H.; Gabler, N.K. Heat stress reduces barrier function and alters intestinal metabolism in growing pigs. J. Anim. Sci. 2012, 90, 257–259.
27. Pearce, C.S.; Mani, V.; Boddicker, R.L.; Johnson, J.S.; Weber, T.E.; Ross, J.W.; Rhoads, R.P.; Baumgard, L.H.; Gabler, N.K. Heat stress reduces intestinal barrier integrity and favors intestinal glucose transport in growing pigs. PLoS ONE 2013, 8, e70215.
28. Pearce, S.C.; Sanz ‐Fernandez, M.V.; Hollis, J.H.; Baumgard, L.H.; Gabler, N.K. Short ‐term exposure to heat stress attenuates appetite and intestinal integrity in growing pigs. J. Anim. Sci. 2014, 92, 5444–5454.
29. Alizadeh, A.; Braber, S.; Akbari, P.; Kraneveld, A.; Garssen, J.; Fink‐ Gremmels, J. Deoxynivalenol and its modified forms: Are there major differences? Toxins 2016, 8, 334.
30. 54. Pierron, A.; Alassane ‐Kpembi, I.; Oswald, I.P. Impact of two mycotoxins deoxynivalenol and fumonisin on pig intestinal health. Porc. Health Manag. 2016, 2, 21.
31. Brandl, K.; Schnabl, B. Is intestinal inflammation linking dysbiosis to gut barrier dysfunction during liver disease? Expert Rev. Gastroenterol. Hepatol. 2015, 9, 1069–1076.
32. Carotti, S.; Guarino, M.P.L.; Vespasiani ‐ Gentilucci, U.; Morini, S. Starring role of toll ‐like receptor ‐4 activation in the gut ‐liver axis. World, J. Gastrointest. Pathophysiol. 2015, 6, 99–109.
33. Medzhitov, R. Toll ‐like receptors and innate immunity. Nat. Rev. Immunol. 2001, 1, 135–145.
34. Loewenstein, F.; Becker, S.; Kuehling, J.; Schrade, H.; Lechner, M.; Ringseis, R.; Eder, K.; Moritz, A.; Reiner, G. Inflammation and necrosis syndrome is associated with alterations in blood and metabolism in pigs. BMC Vet Res 18, 50 (2022). https://doi. org/10.1186/s12917-021-03107-1
35. Nordgreen, J.; Edwards, S.A.; Boyle, L.A.; Bolhuis, J.E.; Veit, C.; Sayyari, A.; Marin, D.E.; Dimitrov, I.; Janczak, A.M.; Valros, A. A proposed role for proinflammatory cytokines in damaging behavior in pigs. Front. Vet. Sci. 2020, 7, 646.
PATOLOGÍA Nº 4 | Abril 2022 Síndrome de inflamación y necrosis porcina 18

MICOTOXINAS ¿CÓMO AFECTAN AL SISTEMA INMUNITARIO PORCINO?
Panagiotis Tassis
Profesor Adjunto de Medicina y Reproducción Porcina, Clínica de Animales de Granja, Facultad de Medicina Veterinaria, Universidad Aristóteles de Tesalónica, Grecia
LLLas micotoxinas son reconocidas por tener un importante impacto sobre sobre el sistema inmunitario porcino, pudiendo afectar indirectamente a la eficacia vacunal, además de aumentar la susceptibilidad a las infecciones y la necesidad de utilizar antimicrobianos, influyendo en última instancia al rendimiento productivo de los animales con un alto coste económico.

En este artículo, revisamos los principales efectos inmunomoduladores de las principales micotoxinas a las que pueden estar expuestos los cerdos a través de materias primas o piensos contaminados.

MICOTOXINAS Nº 4 | Abril 2022 Micotoxinas - ¿Cómo afectan al sistema inmunitario porcino? 20
Descarga el PDF
LA AMENAZA DE LAS MICOTOXINAS
Las micotoxinas son metabolitos secundarios producidos por hongos (géneros Aspergillus, Penicillium, Fusarium, Alternaria y Claviceps) que pueden encontrarse en los granos (maíz, trigo, cebada, etc.) en todo el mundo.
Los estudios demuestran la variabilidad de la distribución mundial de las micotoxinas entre distintas regiones y zonas climáticas1. Entre las numerosas micotoxinas que existen, se ha señalado que el deoxinivalenol (DON), las fumonisinas (FBs, FB1-FB3), la zearalenona (ZEN), las aflatoxinas (AFs, principalmente AFB1), la ocratoxina A (OTA) y la toxina T-2 son las más relevantes para la salud y la producción de los cerdos2.
Estudios recientes han puesto de manifiesto que hasta el 80% de los cultivos de alimentos y piensos están contaminados con micotoxinas a nivel mundial (ocurrencia por encima de los niveles detectables en hasta el 60-80%), siendo la co-contaminación de los granos con múltiples micotoxinas un hallazgo común3
Un estudio de 10 años con muestras de 100 países reveló que el DON, la FB y la ZEN eran las micotoxinas más prevalentes, detectándose en el 64%, 60% y 45% de todas las muestras, respectivamente. Las concentraciones medias fueron de 723 μg/kg, 388 μg/kg y 55 μg/kg para FBs, DON y ZEN, respectivamente1.
Los cerdos y las aves de corral son muy susceptibles y sensibles a los efectos de las micotoxinas4. En el caso de los cerdos, los efectos de las micotoxinas son múltiples y dependen de5:
El tipo de micotoxina. El nivel y la duración de la exposición. La edad del animal.
La ingestión de grandes cantidades de estas toxinas puede resultar en CASOS AGUDOS de micotoxicosis con síntomas clínicos bien descritos2,4,6:
Zearalenona: trastornos reproductivos y síndrome de hiperestrogenismo. Deoxinivalenol: vómitos y retraso del crecimiento.
Fumonisinas: edema pulmonar.
Aflatoxinas (agudo): reducción de la ingesta de alimentos y aumento de peso.
Ocratoxina A: polidipsia, poliuria y reducción del crecimiento.
El consumo crónico de bajos niveles de micotoxinas y la inducción de síntomas clínicos inespecíficos parece más probable en condiciones de campo.
Los EFECTOS TÓXICOS CRÓNICOS de las micotoxinas en los cerdos incluyen hepatotoxicidad, genotoxicidad, nefrotoxicidad,neurotoxicidad, reprotoxicidad, inmunotoxicidad y otros efectos como los trastornos neuroendocrinos6 7
M
INMUNOLOGÍA 21
IMPACTO
DE LAS
MICOTOXINAS EN EL SISTEMA INMUNITARIO PORCINO
Los efectos de las micotoxinas en los cerdos son múltiples y varían considerablemente. Teniendo en cuenta que la exposición de micotoxinas se produce a través de la ingestión de alimentos contaminados, la capa de células epiteliales gastrointestinales es el primer lugar de contacto e interacción14 , 15
A partir de ese momento, se produce una inmunomodulación y una secuencia de reacciones inflamatorias que pueden verse influidas por los efectos de la micotoxina a nivel molecular y celular.
Por ejemplo, las micotoxinas producidas por Fusarium pueden producir efectos inmunoestimulantes o inmunosupresores, según la edad del hospedador, la dosis y duración de la exposición7,16 , mientras que las AFs y la OTA inducen inmunosupresión17,18
Las consecuencias sanitarias y económicas de los efectos de las micotoxinas en el sistema inmunitario de los cerdos son significativas, habiéndose descrito tres consecuencias principales19 21:
1 2 3
Mayor susceptibilidad a enfermedades infecciosas.
Reactivación de infecciones crónicas.
Disminución de la eficacia vacunal.
La mezcla de micotoxinas presentes en los piensos para cerdos puede aumentar la variabilidad de efectos sobre el sistema inmunitario y no pueden predecirse fácilmente, ya que podrían tener una interacción antagónica, aditiva o sinérgica y aumentar el impacto de cada micotoxina20
A continuación, se repasan las evidencias relativas a los mecanismos subyacentes a la inmunomodulación inducida por micotoxinas.
Se hace especial referencia a los ensayos con cerdos o líneas celulares porcinas, aunque también se presentan selectivamente pruebas de otros animales de granja, animales de laboratorio y líneas celulares.
El sistema inmunitario presenta una especial susceptibilidad a la inmunosupresión inducida por micotoxinas. Esto se debe a la vulnerabilidad de las células en continua proliferación y diferenciación que participan en actividades mediadas por el sistema inmunitario y que regulan la compleja red de comunicación entre los componentes celulares y humorales8 MICOTOXINAS Nº 4 | Abril 2022 Micotoxinas - ¿Cómo afectan al sistema inmunitario porcino? 22
TRICOTECENOS: DEOXINIVALENOL TRICOTECENOS: DEOXINIVALENOL
El DON y otras micotoxinas producidas por Fusarium afectan directamente a la síntesis de globulinas en el hígado y comprometen la respuesta inmunitaria de los cerdos22
Asimismo, los tricotecenos de tipo B, incluido el DON, tienen la capacidad de estimular e inhibir las funciones inmunitarias, interrumpiendo la señalización intracelular entre los leucocitos23
LOS EFECTOS INMUNOESTIMULANTES O INMUNOSUPRESORES DE
Las células inmunitarias (macrófagos, linfocitos B y T y células NK) son sensibles a DON, 3-Ac-DON y 15-Ac-DON, y se pueden observar efectos inmunoestimulantes/inflamatorios o inmunosupresores dosis-dependientes7,23,24,27,28
EFECTOS MOLECULARES Y GENÉTICOS
La expresión génica inflamatoria diferencial y la apoptosis inducida por DON son mecanismos que juegan un papel importante en sus efectos inmunológicos.
EFECTOS TÓXICOS
Los efectos tóxicos del DON en los animales de granja se han estudiado ampliamente25, siendo los efectos anorexígenos e inmunomoduladores los más pronunciados en los cerdos.
El rechazo y la reducción de la ingesta tras la ingestión de pienso contaminado con DON se han relacionado con los efectos hormonales e inmunotóxicos de esta toxina, habiéndose observado que los cambios en las hormonas de la saciedad (colecistoquinina y péptido tirosina tirosina) y los cambios de las citoquinas proinflamatorias (IL-1β, IL-6, TNF-alfa) están asociados a la anorexia inducida por DON25
Pocos estudios han demostrado los efectos de 3-Ac-DON, 15-Ac-DON y DON-3-glucósido en la respuesta inmunitaria.
No obstante, en el caso de las formas acetiladas de DON, hay pruebas de que al menos el 15-Ac-DON genera una toxicidad crónica general similar a la del DON, mientras que la inmunotoxicidad del 3-Ac-DON y del 15-Ac-DON podría estar menos expresada25
Como se ha observado en estudios in vivo, los tricotecenos pueden ser estimulantes en algunos modelos de leucocitos, pero inhibidores en otros. Paradójicamente, estas actividades a veces se producen conjuntamente26
La diana molecular más relevante de los tricotecenos es la subunidad ribosómica 60S, lo que sugiere que un mecanismo subyacente es la inhibición de la translocación29 .
Sin embargo, se sabe que los tricotecenos y otros inhibidores de la translocación que se unen a los ribosomas también pueden activar rápidamente las proteínas quinasas activadas por mitógenos (MAPK), provocando la expresión de genes relacionados con la inflamación como citoquinas proinflamatorias23,24, e inducir la apoptosis en un proceso conocido como “respuesta al estrés ribotóxico” 30 31

Los MAPKs modulan procesos fisiológicos como el crecimiento, diferenciación y apoptosis celular 32 y son críticos para la transducción de señales en la respuesta inmunitaria33
Además, se ha señalado que el DON afecta predominantemente a las células de proliferación intensa como las células epiteliales intestinales, el hígado y las células inmunitarias, y el orden de sensibilidad al DON es inmunitario > neuroendocrino > intestinal7, 14
DON DEPENDEN DE LA DOSIS, FRECUENCIA Y DURACIÓN DE LA EXPOSICIÓN24
INMUNOLOGÍA 23
EFECTOS INMUNITARIOS EN LECHONES EFECTOS HEPATOTÓXICOS
Como se ha descrito anteriormente34, las bajas concentraciones de DON (hasta 840 μg/kg de alimento durante 4 semanas) no afectan a la respuesta inmunitaria de los lechones en lo que respecta a la concentración de inmunoglobulinas, la proliferación de linfocitos y la producción de citoquinas.
Sin embargo, en otros estudios se ha demostrado que el DON aumenta la concentración de IgA en la sangre, mientras que la proliferación de linfocitos inespecíficos puede aumentar o disminuir19 35 38
Ferrari et al. 39 no demostraron efectos inmunitarios significativos tras 6 semanas de exposición oral a DON en cerdos, confirmando la variabilidad de los efectos inmunitarios de DON, mientras que Frankic et al. 37 encontraron que el DON (4 mg/kg de alimento durante 14 días en cerdos destetados) aumentaba significativamente el daño en el ADN en los linfocitos en un 28%.
Por otro lado, según Döll y Dänicke40, de acuerdo con investigaciones anteriores sobre cerdos, otros animales de granja y humanos, normalmente sólo hay efectos menores (hasta 1,5 veces), insignificantes o ningún efecto del DON sobre la IgA.

En el estudio in vitro de Doll et al. 41 con hepatocitos expuestos a 500 o 2000 nm de DON con o sin 1μg lipopolisacáridos (LPS)/ ml (incubación durante 48 horas), se sugirió que el DON tiene el potencial de provocar y modular las reacciones inmunitarias en las células hepáticas porcinas.
El estudio aportó pruebas de que:
El DON y los LPS tuvieron efectos sinérgicos, aumentando la expresión de ARNm de TNF-α en los hepatocitos.
El DON estimuló una inducción dependiente de la dosis de ARNm de IL-6.
Las concentraciones sobrenadantes de IL-6 inducidas por LPS se redujeron significativamente.
La expresión del ARNm de IL-10 antiinflamatoria aumentó.
EFECTOS SOBRE LA RESPUESTA A LA VACUNACIÓN
En un estudio sobre los efectos del DON sobre la respuesta inmunitaria a la vacunación (2,2-2,5 mg DON/ kg de pienso, cerdos destetados durante 9 semanas)19, se observó un aumento de las IgA e IgG específicas frente a la ovoalbúmina (OVA), mientras que los ganglios linfáticos de los cerdos tratados tenían una expresión reducida del ARNm de TGF-β y de IFN-γ, lo que respaldaba la posibilidad de una reducción de la respuesta a la vacunación inducida por el DON.
La toxina tuvo un efecto bifásico sobre la proliferación de linfocitos específicos de OVA, sugiriendo un aumento en los días posteriores a la inmunización con OVA, pero una disminución en las semanas siguientes.
Otro estudio en cerdos inmunizados con OVA mostró un aumento de los títulos de IgG anti-OVA a los 42 días después de la exposición a una dieta contaminada con DON.
Simultáneamente, aumentó la expresión de las quimiocinas implicadas en reacciones inflamatorias (IL-8, quimiocina, CXCL20, IFN- γ).
El DON también aumentó la expresión del gen del antioxidante glutatión peroxidasa 2 (GPX-2) y redujo la expresión de los genes que codifican los antioxidantes enzimáticos, incluyendo GPX-3, GPX-4 y la superóxido dismutasa 3 (SOD-3), involucrados en el estrés oxidativo42
Asimismo, se observó una respuesta reducida o retardada de los anticuerpos a los antígenos dependientes del timo en cerdos en crecimiento alimentados con granos contaminados con DON22,43.
MICOTOXINAS Nº 4 | Abril 2022 24
EFECTOS SOBRE LOS MACRÓFAGOS
Los macrófagos parecen ser especialmente sensibles a los tricotecenos26 44. De hecho, se considera que los macrófagos son células con una mayor sensibilidad al DON (10 a 100 veces) en comparación con los fibroblastos, linfocitos, IEC o astrocitos.
Basándose en algunas hipótesis, este aumento de la sensibilidad puede atribuirse a la capacidad de DON para entrar en los macrófagos o al aumento de la apoptosis de los macrófagos tras la activación inducida por DON de la vía JAK/STAT4 45 .
EFECTOS SOBRE LAS CÉLULAS DENDRÍTICAS
La modulación de la función de las células dendríticas (CD) probablemente contribuye a los efectos inmunosupresores inducidos por el DON.
De hecho, un estudio in vitro e in vivo reveló la interacción entre DON y CD. Los hallazgos tras alimentar a cerdos con 5,3 ppm de DON en el pienso durante 5-11 semanas (in vivo) y/o tras el tratamiento de CD derivadas de monocitos con 100-800ng/mL de DON (in vitro), incluyeron55:
Disminución de la actividad endocítica.
Inhibición de la secreción de IL-10.
Deterioro de la capacidad de las CD para la captación de antígenos.
La exposición a dosis bajas de DON resulta en: Estimulación y activación de macrófagos (macrófagos humanos, de ratones, murinos y porcinos).
Secreción de citoquinas inflamatorias (IL-1β, IL-2, IL-4, IL-5, IL-6 y TNFα).
Expresión de las proteínas intracelulares COX-2 e iNOS (activación selectiva de la ERK, NFκB y de la proteína activadora-1) 24 , 36 46 48 , de la sintasa de óxido nítrico49 y de numerosas quimiocinas50,51
EFECTOS SOBRE LA BARRERA INTESTINAL
Los efectos del DON en el intestino de los cerdos han sido bien descritos por Pinton y Oswald 56 , sugiriendo múltiples efectos negativos sobre la integridad del epitelio y la barrera intestinal, así como la modulación de la actividad del epitelio intestinal en su papel en la respuesta inmunitaria, afectando la producción de citoquinas por las células intestinales o inmunitarias, posiblemente interfiriendo también con la comunicación entre las células epiteliales y otras células inmunitarias intestinales.
Cano et al. 57, investigaron los efectos in vitro del DON purificado [IPEC-1 porcino y explantes yeyunales porcinos (modelo ex vivo)], y sugirieron que el DON puede:
La exposición a dosis altas de DON induce efectos supresores de procesos relacionados con los macrófagos, como la secreción de citoquinas y la fagocitosis, e induce su apoptosis (mediante la activación de la quinasa p38), aumentando la susceptibilidad del hospedador a patógenos y reduciendo la activación de los linfocitos B y T (los macrófagos no actúan como células presentadoras de antígenos)52 54
Sin embargo, los estudios en macrófagos porcinos primarios evidencian la falta de activación de la COX-2 y la IL-6 por el DON en los macrófagos porcinos, lo que sugiere un modo de acción distinto en esta especie36
Potenciar la expresión de genes relacionados con la inmunidad.
Aumentar la concentración tiempo-dependiente de proteínas en las células diferenciadas IPEC-1.
Causar una respuesta inflamatoria intestinal temprana. Interrumpir la homeostasis intestinal.
Inclinar el sistema inmunitario intestinal hacia una respuesta del Th17.
INMUNOLOGÍA 25
TRICOTECENOS:
TRICOTECENOS:
TOXINAS T-2 Y HT-2
TOXINAS T-2 Y HT-2
Según la EFSA58, el cerdo doméstico se encuentra entre las especies más sensibles a los efectos inmunotóxicos y hematotóxicos de las toxinas T-2 y HT-2.
Se ha descrito que la toxina T-2 es inmunotóxica debido a sus propiedades citotóxicas, apoptóticas o inmunosupresoras. Al igual que otros tricotecenos, la toxina T-2 puede ser tanto inmunosupresora como inmunoestimuladora, dependiendo de la dosis y el momento de la exposición.
EN DIVERSOS ESTUDIOS
La diana molecular más destacada de los tricotecenos es la unidad ribosómica 60S, donde impide la iniciación de las cadenas polipeptídicas66 .
Los estudios in vitro sugieren que la toxina T-2 interactúa con la peptidil transferasa, una integrante de la subunidad ribosómica 60S, inhibiendo así la transpeptidación en el proceso de formación de enlaces peptídicos, lo que da lugar a una inhibición de la prolongación y terminación de la síntesis proteica62 , 63
Los efectos tóxicos producidos por las toxinas T-2 y la toxina HT-2 incluyen la inhibición de la síntesis proteica (mediante la unión e inactivación de la actividad de la peptidil transferasa en el punto de transcripción), lo que afecta a la síntesis de inmunoglobulinas y, a su vez, a la inmunidad humoral67 69
Las células dendríticas, las más potentes células presentadoras de antígenos (APC) del sistema inmunitario, han demostrado ser sensibles a los tricotecenos, observándose que la toxina T-2 altera su proceso de maduración64
En un estudio in vitro anterior con macrófagos alveolares primarios de origen porcino, la preexposición de los macrófagos a 3 nM de toxina T-2 disminuyó la producción de mediadores inflamatorios (IL-1β, TNF-α , óxido nítrico) en respuesta al LPS y la disminución de la respuesta proinflamatoria se asoció con una disminución de la expresión del ARNm de los TLR.
La toxina T-2 60 ,61:
Induce la peroxidación de los lípidos, afectando la integridad de la membrana celular.
Provoca depleción celular en el tejido linfoide.
Inhibe la función de las células inflamatorias.
Disminuye las respuestas inmunitarias humorales y celulares, lo que conduce a una mayor susceptibilidad a las infecciones.
La exposición a la toxina T-2 provoca leucopenia y depleción celular en los órganos linfoides, lo que perjudica considerablemente la producción de anticuerpos, reduce la respuesta proliferativa de los linfocitos y obstaculiza el desarrollo de las células dendríticas70
Por otro lado, también puede afectar a las ADN polimerasas, a la desoxinucleotidil transferasa terminal, a la monoaminooxidasa y a varias otras proteínas que intervienen en la coagulación71.
Se ha demostrado un efecto perjudicial de la toxina T-2 sobre el ADN , tiempo- y dosis-dependiente, utilizando células mononucleares de sangre periférica de cerdos (incubación con 0,1-1 μM durante 24 o 42 horas)72
Así pues, la ingestión de bajas concentraciones de toxina T-2 puede afectar a la activación de los TLR al disminuir el reconocimiento de patrones de patógenos, interfiriendo con el inicio de la respuesta inmunitaria inflamatoria frente a los patógenos65
La toxicidad T-2 aguda (1,2 mg/ kg de peso corporal por vía intravenosa) se caracteriza por emesis, paresia posterior, apatía y letargo, así como por graves daños en las células que se dividen activamente en la médula ósea, los ganglios linfáticos, el bazo, el timo y la mucosa intestinal. Sin embargo, en 24 horas, los cerdos supervivientes se recuperan y parecen normales60 73 .
SE HAN DEMOSTRADO LOS EFECTOS DE LA TOXINA T-2 SOBRE LA RESPUESTA INMUNITARIA, TANTO HUMORAL COMO CELULAR⁵9
MICOTOXINAS Nº 4 | Abril 2022 Micotoxinas - ¿Cómo afectan al sistema inmunitario porcino? 26
En un estudio de alimentación con cerdos se observó inmunosupresión (0,5-3,0 mg T-2/kg de pienso).
Se inmunizó a los cerdos con globulina de caballo, observándose una reducción de la síntesis de anticuerpos, así como una disminución dosis-dependiente de los elementos linfoides en el timo y el bazo.
El recuento de leucocitos y la porción de linfocitos T se redujeron en todos los grupos de exposición74
En los cerdos inmunizados con OVA, las dosis subclínicas de toxina T-2 indujeron un aumento temprano y transitorio de la concentración plasmática total de IgA, pero una disminución del título de IgG anti-OVA.
Los cerdos alimentados con 1,324 o 2,102 mg de toxina T-2/ kg exhibieron una producción reducida de anticuerpos anti-ovalbúmina el día 21 sin alteración significativa de la proliferación de linfocitos específicos75.
Frankic et al.37 señalaron que la toxina T-2 (3 mg/kg de pienso durante 14 días en cerdos destetados) aumentaba la cantidad de daño del ADN en los linfocitos en un 27% y disminuía la IgG sérica total.
De manera análoga al efecto sobre la proliferación de los linfocitos, se comprobó que cantidades bajas de toxina T-2 aumentaban los niveles de anticuerpos, mientras que las cantidades altas eran inmunosupresoras60, por lo que se puede observar una mayor susceptibilidad a las enfermedades infecciosas (por ejemplo, Mycobacterium, Staphylococcus, Listeria, Toxoplasma y el virus del herpes simple (HSV-1)efectos observados en ratas, ratones y pollos)58.
Li et al.76 explicaron que la supresión del IFN-γ por la toxina T-2 es probablemente uno de los factores responsables de la disminución de la inmunidad antiviral en presencia de la toxina T-2. La supresión del IFN-γ puede deberse a un aumento de la expresión de la IL-6 (interleucina 6).
LOS MACRÓFAGOS, LA Ig A Y LAS CITOQUINAS PROINFLAMATORIAS
TIENEN UN PAPEL SIGNIFICATIVO EN LOS EFECTOS INMUNOMODULADORES DE LOS TRICOTECENOS⁷⁷
Los mecanismos subyacentes de los efectos de los tricotecenos en el sistema inmunitario, tal y como se sugiere en los estudios de Wu et al.77 79 y Liao et al.62, son:
1Activación de las proteínas quinasas activadas por mitógenos (MAPK)
La teoría más aceptada es que el DON y otros inhibidores de la traslación de la unión al ribosoma pueden activar a las proteínas quinasas activadas por mitógenos (MAPK) mediante un mecanismo conocido como proceso de “respuesta al estrés ribotóxico” 30 Los MAPKs, que son cruciales para la transducción de señales en la respuesta inmunitaria, participan en la regulación transcripcional y post-transcripcional de los genes.
El DON se une al locus de la peptidil transferasa del ribosoma 28s, lo que activa la respuesta al estrés ribotóxico e induce la fosforilación de la proteína quinasa (PKR) y la quinasa hematopoyética (Hck), y luego desencadena rápidamente la vía de señalización MAPK (así como las vías NF-kB y JAK/STAT), lo que finalmente conduce a la apoptosis celular y a la expresión de citoquinas proinflamatorias80.
Los tricotecenos también afectan a moléculas de señalización relacionadas con la apoptosis, como IL-6, IL-1β y TNF-α . En este sentido, la fosforilación MAPK puede activarse después de que estas toxinas se unan al peptidil de los ribosomas para regular las respuestas inmunitarias y la apoptosis23 88
INMUNOLOGÍA 27
Estrés del retículo endoplasmático y señalización mediada por el calcio
El DON puede inducir estrés del retículo endoplásmico (RE)81, aumentando asimismo la expresión de las proteínas ATF3 y DDIT3 (dos de los principales marcadores de estrés del RE) en un plazo de 3 horas81
LA SOBREEXPRESIÓN DE ATF3 Y DDIT3
PUEDE CONDUCIR A LA DETENCIÓN DEL CICLO CELULAR Y/O LA APOPTOSIS⁸,⁸³
El DON puede inducir la fosforilación de las proteínas quinasas JNK en las células Jurkat, desencadenando una respuesta de activación de los linfocitos T y la separación de la caspasa-3, un evento conocido por mediar la apoptosis, dentro de las 3 horas después de su exposición81
La caspasa-12 activada puede inducir la activación de la caspasa-9 a través de la escisión directa de la caspasa-9, que a su vez induce la activación de la caspasa-3 y finalmente se produce la apoptosis84
3
Inducción de vías de señalización mitocondrial y apoptosis
El DON es capaz de inducir apoptosis al involucrar la vía intrínseca mitocondrial a través de los siguientes mecanismos85,86:
Apertura del poro de transición de permeabilidad mitocondrial (mPTP).
Pérdida del potencial transmembrana mitocondrial. Aumento del O2- (anión superóxido).
Liberación del citocromo C.
Así pues, la disfunción mitocondrial, a raíz de la liberación del citocromo C en el citoplasma y la activación en serie de las caspasas, contribuye a la apoptosis inducida por DON, posiblemente modulada por la familia Bcl-2 62
4
Interferencia en la síntesis proteica
El DON puede influir en la vía de la síntesis proteica en las células a través de la alteración de la síntesis de ARN, del funcionamiento ribosómico y de la traducción.
El DON también puede aumentar la expresión de microARNs (miRNA) responsables de la inhibición de genes selectivos y la síntesis de los ribosomas87 Además, los tricotecenos reducen considerablemente la expresión del IFN-γ en cerdos y ratones, reduciendo así la resistencia del hospedador a los virus y su capacidad de reparación19,93, mientras que el DON reduce la expresión del IFN-b y promueve la apoptosis celular 48 .

ESTRÉS OXIDATIVO
El estrés oxidativo es un importante mecanismo de toxicidad asociado a los tricotecenos, ya que altera el funcionamiento normal de las mitocondrias y genera radicales libres, incluidos los ROS. Estos compuestos inducen la peroxidación de los lípidos, cambian el estado antioxidante de las células y reducen la actividad de las enzimas antioxidantes como la glutatión-S-transferasa (GST), la superóxido dismutasa (SOD) y la catalasa (CAT)77,88
El daño al ADN también se asocia con la generación de ROS y la peroxidación de lípidos. Algunas vías de señalización, entre ellas MAPK, JAK/STAT y NF-κB, son inducidas posteriormente por el estrés oxidativo, y las vías de apoptosis mediada por caspasas también se activan89
El estrés oxidativo (generación de ROS tan pronto como 30 minutos después de la exposición) es el mecanismo por el cual la toxina T-2 causa daños en el ADN y apoptosis90 92
2
MICOTOXINAS Nº 4 | Abril 2022 Micotoxinas - ¿Cómo afectan al sistema inmunitario porcino? 28
INMUNOMODULACIÓN EVASIÓN INMUNITARIA
El efecto inmunomodulador de los tricotecenos está determinado por el equilibrio entre las vías de señalización de supervivencia y muerte celular 26 , 88 , 94
La apoptosis celular inducida por la toxina T-2 se inhibe simultáneamente por la vía JNK1-STAT3 (que mantiene la función normal de las mitocondrias) y se promueve por la vía STAT1 en la misma célula94

El DON inicia tanto una vía de supervivencia (ERK/AKT/ p90Rsk/Bad) como una vía apoptótica competidora (p38/ p53/Bax/ Mitocondrias/ Caspasa-3) en macrófagos RAW
264.726
INMUNOESTIMULACIÓN
El efecto inmunoestimulador de los tricotecenos puede estar mediado, en parte, por la autofagia95 , 96
Según Tang et al.9 , la autofagia inducida por DON inhibe la apoptosis de las células epiteliales intestinales al mitigar el daño causado por el estrés oxidativo, lo que hace que la respuesta de las células al estrés falle.
Según Bin-Umer et al.95, la autofagia de las mitocondrias dañadas (mitofagia) desempeña un papel fundamental en la resistencia de las células a los tricotecenos.
Los tricotecenos tienen un mecanismo de “evasión inmunitaria” que suprime las defensas inmunitarias del hospedador y las inducidas por las vacunas.
Este mecanismo interfiere con los genes antiapoptóticos, promoviendo la apoptosis inducida por el estrés oxidativo93,97 98, permitiendo que las toxinas escapen a la reacción del hospedador y a la reparación inmunitaria78
ZEARALENONA ZEARALENONA
Debido a sus propiedades estrogénicas, el ZEN se une a los receptores de estrógeno (REs) y se asocia típicamente con los trastornos reproductivos en el porcino99. No obstante, se sabe que la ZEN también se relaciona con fenómenos de hepatotoxicidad, hematotoxicidad, inmunotoxicidad y genotoxicidad 45 , 100
La ZEN no solo activa genes relacionados con la respuesta inmunitaria, sino que también interfiere con el sistema inmunitario esplénico, cambia los fenotipos de los linfocitos del bazo e incluso provoca la atrofia de los linfocitos en ratones o ratas102 103 Además, la ZEN puede inducir la inmunosupresión al reducir las inmunoglobulinas en el suero y las citoquinas en los órganos linfoides104
Por otro lado, la secuenciación del ARN en muestras de hígado de lechones alimentados con pienso contaminado con ZEN y DON indicó un efecto sobre la expresión y conjunto de transcritos relacionados con la inmunidad105
Dado que las células inmunitarias también expresan REs (REα en las células NK, macrófagos y células T, REβ en los monocitos y los linfocitos B101), la ZEN también puede unirse a estos receptores, influyendo en diversas vías metabólicas de la respuesta inmunitaria100
INMUNOLOGÍA 29
RESPUESTA INMUNITARIA HUMORAL CITOTOXICIDAD Y DAÑO OXIDATIVO
En cuanto a los efectos de la ZEN en la respuesta inmunitaria humoral, un estudio realizado con ratas (5,0 mg/kg de ZEN durante 36 días) reveló que la ZEN sola (sin desafío inmunitario) puede disminuir la producción de inmunoglobulinas106. Además, un estudio in vitro con células mononucleares de sangre periférica (PBMC) de lechones también mostró una disminución de los niveles de inmunoglobulina107
En cambio, en un estudio in vivo realizado por Swamy et al.108, se observaron mayores concentraciones de inmunoglobulinas séricas (aumento de IgM e IgA, pero no de IgG) en cerdos alimentados con granos contaminados con DON, ácido fusárico (FA), ZEN y 15-acetildeoxinivalenol (15-acetilDON).
Según otro estudio in vivo realizado por el mismo grupo109 con diferentes concentraciones de las mismas micotoxinas en cerdos, se observó la ausencia de efecto de la dieta en los niveles de anticuerpos IgM e IgG.
Los efectos inconsistentes de la ZEN sobre la respuesta inmunitaria humoral podrían estar relacionados con los efectos específicos de los receptores, ya que la ZEN es un agonista de REα y un agonista-antagonista mixto de REβ110 , con un posible antagonismo completo de la REβ expresado por los linfocitos B103
Los experimentos in vitro con células Vero y Caco-2 sugieren que la ZEN induce citotoxicidad y daño oxidativo independientemente de su potencial estrogénico111
Un estudio in vitro de Taranu et al.112, en el que se investigaban los efectos de la ZEN (10 mM) en la expresión génica de las células intestinales porcinas (IPEC-1), apoyó que, aunque esas concentraciones de ZEN no afectan a la viabilidad celular, el 70% de los 190 genes de expresión diferencial estaban sobreexpresados.
Los genes que codifican las enzimas glutatión peroxidasa (GPx6, GPx2, GPx1) se encontraban entre los más expresados, lo que respalda la idea de que las micotoxinas inducen daño oxidativo.
Se encontró una mayor expresión de las citoquinas implicadas en la inflamación (por ejemplo, TNF-α , IL-6, IL-8) y el reclutamiento de células inmunitarias (por ejemplo, IL-10), demostrando que la ZEN modula las vías de reparación inmunitaria y/o celular de las células intestinales.
METABOLITOS DE ZEN
Marin et al.113 estudiaron los efectos de la ZEN y sus metabolitos, αzearalenol (α-ZEL), β-zearalenol (β-ZEL) y zearalanona (ZAN), sobre varias funciones de los neutrófilos como la proliferación, la síntesis de citoquinas y el estrés oxidativo en un modelo de células polimorfonucleares porcinas (PMN).
Se observó que la toxina parental era menos tóxica, mientras que los derivados de ZEN indujeron una disminución significativa de la síntesis de IL-8 en los PMN Se llegó a la conclusión de que la ZEN y sus derivados pueden tener efectos divergentes sobre importantes parámetros de la inmunidad innata de los cerdos, como la viabilidad de las células, la IL-8 y la síntesis de aniones superóxido.
En otro estudio realizado por el mismo grupo107 con PBMC:
5 y 10 μM de ZEN y ZAN disminuyeron significativamente la síntesis de TNF-α en el sobrenadante del cultivo celular de PBMC.
10 μM de ZAN disminuyó la síntesis de IL-8.
ZEN y sus metabolitos, en concentraciones superiores al 5 μM, indujeron una disminución significativa de la concentración de IgG, IgA o IgM.
Una evaluación in vitro posterior de la toxicidad de α-ZEL y β-ZEL en macrófagos RAW264.7114 demostró que la β-ZEL tenía un efecto inhibitorio más fuerte sobre la viabilidad de los macrófagos que la α-ZEL.
MICOTOXINAS Nº 4 | Abril 2022 Micotoxinas - ¿Cómo afectan al sistema inmunitario porcino? 30
β-ZEL también indujo muerte celular, principalmente por apoptosis en lugar de necrosis, mientras que los otros metabolitos ZEN se asociaron a:
Pérdida de potencial de la membrana mitocondrial (MMP). Cambios mitocondriales en las proteínas Bcl-2 y Bax.
Liberación citoplasmática del citocromo c y el factor inductor de apoptosis (AIF).
Al explicar las alteraciones observadas en los macrófagos, se llegó a la conclusión de que la activación de p53, JNK o p38 quinasa por los metabolitos ZEN es la principal señal corriente arriba necesaria para la alteración mitocondrial de las vías de señalización Bcl-2 (antiapoptótica)/Bax (proapoptótica) y la generación de especies de oxígeno reactivo intracelular (ROS), mientras que la pérdida de potencial de la membrana mitocondrial y la translocación nuclear del factor inductor de la apoptosis son los eventos críticos de la apoptosis mediada por el metabolito ZEN en los macrófagos.
FUMONISINA B FUMONISINA B
La toxicidad por FB, según el nivel de contaminación y el tiempo de exposición, puede provocar el síndrome de edema pulmonar porcino debido a sus efectos tóxicos cardiovasculares, así como un aumento de la relación esfinganina/ esfingosina (Sa/So) en el suero y los tejidos, toxicidad hepática y renal , retraso en la madurez sexual y alteraciones de la funcionalidad reproductiva, deterioro de la respuesta inmunitaria innata y adquirida, lesiones histológicas en los órganos internos, así como alteraciones de la fisiología cerebral.
Debido a su parecido estructural con la ceramida, las fumonisinas inhiben competitivamente las ceramida sintasas (CerS), un grupo de enzimas clave en la biosíntesis de la ceramida y los esfingolípidos más complejos, lo que da lugar a la interrupción de la síntesis de novo de la ceramida, así como al metabolismo de los esfingolípidos y, en consecuencia, a alteraciones en las vías lipídicas115 .

INFLAMACIÓN
Las FBs, especialmente la B1 (FB1), influyen en la respuesta inflamatoria21 116 .
Se ha descrito una reducción de la expresión de citoquinas (IL-6, IL-1β, IL-12p40 y IL-8) en el bazo y un aumento significativo de la expresión de IL-1β, IL-6, IFN-γ y TNF-α en el intestino delgado de los lechones alimentados con dietas contaminadas [ya sea DON (3 mg/kg) o FB (6 mg/kg), o ambos durante 35 días]117
Tras la ingestión de 2,8 μM FB1/kg de peso corporal (37-44 mg FB1/kg de alimento), se encontró una disminución de la expresión de la mayoría de las citoquinas en las diferentes porciones intestinales tras 14 días de exposición118
Además, 8 mg de FB1/ kg de pienso disminuyó la expresión génica de las citoquinas IL-4, IL-6 e IL-10 de Th2 en la sangre de los cerdos116,119. Algunos de los cambios en la expresión de ARNm de IL1α , IL1β, IL6, IL8, TNFα y MCP-1 inducidos por FB u otras toxinas de Fusarium también podrían estar relacionados con la citotoxicidad120.
INMUNOLOGÍA 31
FUNCIÓN INTESTINAL
En cuanto a la morfología y la función intestinal , las FBs se han asociado con21:
Fusión y atrofia de las vellosidades intestinales.
Disminución de la resistencia eléctrica transepitelial (TEER), densidad de células caliciformes, y expresión de ocludina y cadherina E.
Mayor translocación bacteriana a otros órganos y proliferación de bacterias oportunistas intestinales.
Se han demostrado efectos negativos significativos en el sistema inmunitario intestinal (exposición oral a 1 ppm FB durante 10 días, seguida de un desafío con E. coli), que muestran una reducción de la expresión intestinal de IL-12p40, un deterioro de la función de las células presentadoras de antígenos intestinales (APC), una disminución de la expresión de la molécula del Complejo de Mayor de Histocompatibilidad clase II (MHC-II) y una reducción de la capacidad de estimulación de los linfocitos T tras la estimulación121
RESPUESTA INMUNITARIA
HUMORAL
En cerdos expuestos a FB1 y vacunados frente al virus de la enfermedad de Aujeszky (Herpesvirus Suid 1 [SuHV1]), la respuesta inmunitaria humoral se vio muy alterada, con una fuerte disminución de los anticuerpos observados122
De forma similar, la exposición in vivo (28 días) de lechones destetados a pienso contaminado con 8 mg de FB1/kg disminuyó significativamente la expresión del ARNm de la IL-4 por parte de los glóbulos sanguíneos de los cerdos y disminuyó el título de anticuerpos específicos tras la vacunación frente a Mycoplasma agalactiae116
En un estudio similar con FB1 y vacunación frente a Mycoplasma agalactiae, se demostró que los niveles de anticuerpos específicos disminuyeron significativamente después de la vacunación, así como el nivel de expresión de ARNm de la IL-10119
En otro estudio se constató una disminución de la expresión de IL-8 en el intestino de los cerdos tras la administración oral de 0,5 mg/kg de FB1, aunque otras citoquinas no se vieron afectadas123.
Según experimentos in vitro e in vivo, la FB1 modifica el equilibrio de citoquinas Th1/ Th2 (T-helper 1/T-helper 2) en los cerdos de manera similar a una respuesta humoral alterada116 119, además de influir en la respuesta inflamatoria. Por otro lado, la incubación de macrófagos alveolares porcinos con FB1 condujo a una reducción significativa del número de células viables y a la muerte celular por apoptosis124
Un experimento in vivo con cerdos [ya sea DON (3 mg/ kg) o FB (6 mg/kg), o ambos durante 35 días] demostró que la IL-8, la IL-1β, la IL-6 y la proteína inflamatoria de los macrófagos-1β disminuían significativamente en el bazo de los lechones expuestos a dietas multicontaminadas (DON y FB), mientras que los animales que sólo recibieron alimentos contaminados con FB demostraron una disminución significativa en la codificación del ARNm para la IL-1b y la IL-6125.
AFLATOXINAS AFLATOXINAS
Las aflatoxinas tienen propiedades hepatotóxicas, carcinogénicas e inmunotóxicas, perjudicando tanto la respuesta inmunitaria innata como la adquirida126
La ingestión de aflatoxinas (140 y 280 ppb durante 4 semanas) tiene un efecto bifásico en el número total de leucocitos de modo que una dosis baja de AF (140 ppb) disminuye el número total de leucocitos, mientras que una dosis alta (280 ppb) tiene el efecto opuesto, además de disminuir la expresión de los mRNA de citoquinas proinflamatorias (IL-1β, TNF-alfa) y aumentar la de los mRNA de citoquinas antiinflamatorias (IL-10)127. En este estudio también se observó una reducción de la respuesta inmunitaria inducida por Mycoplasma agalactiae en el grupo tratado con 280 ppm.
MICOTOXINAS Nº 4 | Abril 2022 Micotoxinas - ¿Cómo afectan al sistema inmunitario porcino? 32
En lo que respecta a los efectos de la AFB1 en el proceso inflamatorio, se ha demostrado que la exposición in vitro de los macrófagos alveolares de los cerdos a esta toxina da lugar a una disminución de la viabilidad y la actividad fagocítica de las células de cultivos primarios en función del tiempo y la dosis124.
La evaluación de muestras de sangre de lechones de 25 días de vida nacidos de cerdas que recibieron AF a través del pienso durante la gestación y lactación, demostró la reducción de la respuesta linfoproliferativa a los mitógenos y la incapacidad de los macrófagos derivados de monocitos para producir eficientemente aniones superóxido tras la estimulación de una reacción oxidativa in vitro, mientras que su capacidad de fagocitar glóbulos rojos no se vio comprometida. Las células granulocíticas mostraron una reducción de la respuesta quimiotáctica al factor quimioatrayente bacteriano y a la caseína128
La AFB1 interfiere en el desarrollo de la inmunidad adquirida en los cerdos tras la vacunación frente a la erisipela con una preparación bacteriana (una suspensión de bacterias muertas) de E. rhusiopathiae y aumenta la gravedad de la infección con E. rhusiopathiae129
Por otra parte, en un modelo de cerdo vacunado con ovoalbúmina (OVA), la exposición a la AFB1 no tuvo un efecto importante sobre la inmunidad humoral (concentraciones de IgA, IgG e IgM totales y de IgG específicas anti-OVA), pero se detectó un fallo en la activación de los linfocitos130
Los hallazgos de otro estudio131 sobre la implicación de la AFB1 en la replicación del virus de la gripe porcina (SIV) in vitro e in vivo, apoyaron la hipótesis de que la exposición a la AFB1 favorece la replicación del SIV, la inflamación y el daño pulmonar al activar la señalización de TLR4-NFkB.
Un estudio con esplenocitos porcinos132 proporcionó pruebas de los mecanismos subyacentes implicados en la inmunosupresión inducida por AFB1
En el estudio, la AFB1 inhibió la producción de IL-2 en los esplenocitos porcinos, provocando una inmunotoxicidad dosis-dependiente Además, la AFB1 disminuyó el nivel de glutatión reducido (GSH) y aumentó la peroxidación lipídica en los esplenocitos porcinos, lo que va acompañado de un aumento de la fosforilación de ERK1/2.
LA AFB1 INHIBE LA PROLIFERACIÓN DE LINFOCITOS INDUCIDA
POR ANTI-CD3 Y LA PRODUCCIÓN DE IL-2 POR LA VÍA DE SEÑALIZACIÓN ERK1/2
MAPK MEDIADA POR EL ESTRÉS OXIDATIVO
Además, la AFB1 altera la inmunidad celular, probablemente por la alteración de la capacidad de presentación de antígenos de las células dendríticas133 . Por otro lado, la exposición a AF aumenta la capacidad de inducción de proliferación de los linfocitos T por parte de las células dendríticas derivadas de monocitos porcinos, lo que mejora la capacidad de presentación de las células134
La OTA es un importante agente nefrotóxico, además de tener propiedades hepatotóxicas, así como inmunotóxicas, neurotóxicas y teratogénicas21
EXPRESIÓN DE CITOQUINAS
La OTA también afecta a la expresión de citoquinas. Un experimento realizado con lechones destetados que ingirieron una dieta contaminada con OTA (181 ng/g de pienso) mostró un aumento del nivel de TNF-α y de IL-10 en plasma, con una menor capacidad de responder con la expresión de citoquinas en un desafío ex vivo con lipopolisacáridos (LPS)137 .
OCRATOXINA
OCRATOXINA
A
A
INMUNOLOGÍA 33
RESPUESTA INMUNITARIA HUMORAL
Se describió una perturbación de la respuesta inmunitaria humoral en un estudio in vivo con cerdos (500 μg OTA/kg de pienso durante 3 meses)122, observándose una fuerte disminución del título de anticuerpos tras la inmunización frente a la Enfermedad de Aujeszky.
Las cerdas jóvenes alimentadas con piensos contaminados con OTA mostraban135:
Una reducción de la respuesta de hipersensibilidad de los basófilos cutáneos a la fitohemaglutinina.
PROLIFERACIÓN DE CÉLULAS INMUNITARIAS
Hay evidencias, principalmente de estudios in vitro, de los efectos de la OTA sobre los neutrófilos y los macrófagos, incluido el estrés oxidativo, la apoptosis, la fosforilación del ERK1/2 y la liberación de TNFα por las vías del NF-kB138
En un estudio sobre la toxicidad de las micotoxinas de Penicillium en la proliferación de linfocitos inducida por mitógenos, se observó que la OTA era el inhibidor de la proliferación celular más potente (50% de inhibición a 1,3 mM)139
Además, se ha señalado que la OTA induce la fosforilación de P38 y ERK1/2 en los macrófagos alveolares porcinos, causando inmunotoxicidad mediante un aumento de las proteínas de la vía de señalización inflamatoria mediada por el receptor Toll-like 4 (TLR4) y una elevada producción de ROS intracelular140.
Una reducción de la hipersensibilidad retardada a la tuberculina.
Una disminución del índice de estimulación para la linfoblastogénesis.
Una disminución de la producción de IL-2 cuando los linfocitos fueron estimulados con concanavalina.
Una disminución del número y la actividad fagocítica de los macrófagos.
La aparición espontánea de una infección clínica por Salmonella choleraesuis relacionada con la dosis se produjo en lechones alimentados con 1 y 3 mg de OTA/kg de pienso136
En otro experimento realizado por el mismo grupo, se vacunó a los lechones frente a S. choleraesuis. La ingestión de OTA (1mg de OTA /kg de pienso) provocó infecciones espontáneas de Brachyspira hyodysenteriae y Campylobacter coli que se asociaron a la inmunosupresión inducida por OTA, mostrando una respuesta retardada al antígeno y una respuesta humoral reducida136
Por el contrario, en un estudio anterior135, la OTA (2,5 mg de OTA/kg de pienso durante 35 días) no tuvo ningún efecto en las concentraciones de inmunoglobulina total y específica.
La OTA puede inducir una expresión alterada de los genes que intervienen en el crecimiento/proliferación celular, la muerte/ supervivencia celular y la función inmunitaria en el riñón, así como una expresión alterada de las moléculas que intervienen en la respuesta inmunitaria y antioxidante en el intestino de los cerdos141 142 .
También se ha descubierto que la OTA modula la expresión de los microARN , en particular en las células renales in vivo e in vitro Muchos de los miARNs alterados están involucrados en las vías de señalización del MAPK 138
La OTA también induce la fosforilación de P38 y ERK1/2 en los esplenocitos de los cerdos, lo que produce nefrotoxicidad e inmunotoxicidad, respectivamente143
Según los enfoques proteómicos, el aumento de la expresión de las proteínas mitocondriales que participan en el transporte de electrones, la síntesis de proteínas, la respuesta al estrés y la muerte celular y la modulación de las proteínas que participan en la inflamación son factores relacionados con la toxicidad de la OTA144,145. Además, se ha descrito una disminución de la viabilidad de los linfocitos T y de la sangre periférica y esplenocitos (400, 800 μg/ kg dieta) en cerdos146
LA NEFROTOXICIDAD Y LA INMUNOTOXICIDAD DE LA OTA PODRÍAN INVOLUCRAR ESTRÉS
AUTOFAGIA¹⁴³,¹⁴⁶ MICOTOXINAS Nº 4 | Abril 2022 Micotoxinas - ¿Cómo afectan al sistema inmunitario porcino? 34
DEL RE, ACTIVACIÓN DE LA SEÑALIZACIÓN MAPK Y
CONCLUSIONES
Se considera que los hongos son la mayor amenaza para la salud animal y vegetal entre todas las clases taxonómicas de patógenos147 y los estudios actuales han proporcionado evidencias claras de que las micotoxinas afectan al sistema inmunitario de los cerdos
El intestino es, sin duda, el eslabón clave entre las micotoxinas ingeridas y los efectos perjudiciales para el animal.
Los efectos negativos de las micotoxinas en el intestino y en el sistema inmunitario implican que pueden desempeñar un papel fundamental en el inicio, la progresión y la duración de las infecciones intestinales y sistémicas. Así, al comprometerse la integridad intestinal también aumenta la probabilidad de que los microorganismos, productos microbianos o micotoxinas pasen a la circulación y desencadenen enfermedades sistémicas148 -150
Los amplios efectos inmunosupresores de las micotoxinas pueden disminuir la resistencia del hospedador a las enfermedades infecciosas20, mientras que la respuesta a las vacunas también se puede ver alterada con dosis de micotoxinas que no alteren la respuesta inmunitaria global75,116 130
Tal alteración de la inmunidad vacunal puede provocar la aparición de enfermedades, incluso en grupos vacunados adecuadamente. Estos casos son importantes cuando se investiga la efectividad de los programas de vacunación en las granjas.
En cuanto a la reducción de la proliferación de linfocitos en estudios in vivo, se ha sugerido efecto aditivo tras la exposición conjunta a las toxinas AF y FB u OTA y T-2 y sinérgico tras la exposición conjunta a FB y DON151.
Cuando esas observaciones se combinan con las diversas propiedades inmunomoduladoras de las micotoxinas, resulta evidente que la respuesta vacunal, la susceptibilidad a las infecciones y el uso de antimicrobianos, así como la productividad y el rendimiento económico puedan verse alterados debido a la ingestión de micotoxinas. Estas cuestiones deben tenerse en cuenta al evaluar la necesidad de un programa preventivo frente a las micotoxinas en las explotaciones porcinas.

Los episodios de contaminación de los piensos con mezclas de micotoxinas deben ser considerados más probables que la contaminación con una sola micotoxina en condiciones de campo. A este respecto, los efectos de las mezclas de micotoxinas en el sistema inmunitario de los cerdos aún no se han aclarado por completo.
Adaptación del artículo publicado en mycotoxinsite: Efectos y mecanismos inmunomoduladores de las micotoxinas en el cerdo
DESCARGAR BIBLIOGRAFÍA
INMUNOLOGÍA 35
S SALMONELOSIS PORCINA: LA INFECCIÓN EN LECHONES, ¿EL ESLABÓN OLVIDADO PARA SU CONTROL?

DDesde que se publicaran hace casi 14 años los resultados del estudio europeo sobre salmonelosis en el ganado porcino en el que España resultó líder en casi todas las categorías (abuelas, madres 2008, 2009), poco hemos mejorado al respecto en nuestro país. La carne de cerdo se considera desde entonces una de las principales fuentes de infección por Salmonella para las personas, pero, a pesar de ello, y de nuestro liderazgo en el sector porcino europeo, son pocos los esfuerzos que se han hecho para controlar esta infección en nuestras explotaciones.
REPASO HISTÓRICO A LOS PROGRAMAS DE CONTROL SALMONELLA
Instituto Agroalimentario de Aragón-IA2 (Universidad de Zaragoza-CITA), Zaragoza, España
En realidad, que los cerdos fueran una fuente significativa de salmonelosis humana se conocía desde mucho antes. Fueron los suecos los que, tras sufrir un importante brote de salmonelosis humana asociado con el consumo de productos animales contaminados a mediados de la década de 1950, iniciaron lo que se conoció como el primer Programa Nacional de Control de Salmonella en Europa (Lundbeck et al, 1955).
Ese programa planteó, como principal objetivo, suministrar productos animales para consumo humano, incluida la carne de cerdo, libres de Salmonella, y se diseñó para prevenir la contaminación por esta bacteria de toda la cadena de producción cárnica.
Nº 4 | Abril 2022 DIAGNÓSTICO Salmonelosis porcina:
su control? 36
Descarga el PDF
la infección en lechones, ¿el eslabón olvidado para
Tras el programa de control sueco, otros países escandinavos siguieron su ejemplo, con Dinamarca, uno de los principales países europeos exportadores de cerdo, iniciando su propio programa en 1995 (Mousing et al.,1997).
El éxito de los programas escandinavos, aunque a un alto coste económico, junto con el desarrollo de una nueva normativa europea (Reglamento -CEnº 2160/2003 sobre el control de la Salmonella y otros agentes zoonóticos específicos transmitidos por los alimentos), impulsó el inicio de nuevos programas nacionales de control en otros países (Alemania y Reino Unido en 2002, Irlanda en 2003, Países Bajos en 2005 y Bélgica en 2007).
Estos programas se basaron, principalmente, en el modelo de control danés, con el uso de la serología como piedra angular de todos ellos. Sin embargo, los resultados no han sido tan evidentes como los obtenidos por Dinamarca.
EL RETO DEL CONTROL DE LA SALMONELOSIS EN EL PORCINO
El problema de controlar una infección como la salmonelosis en un entorno productivo como el del porcino es evidente. La cadena de producción de carne de cerdo es un proceso complejo que, de forma resumida, podría dividirse en cuatro fases claramente diferenciadas:
Los cerdos de engorde se consideran la principal fuente de contaminación de las canales en el matadero (Argüello et al., 2013), por ello, la salmonelosis se ha estudiado especialmente durante la fase de cebo.
CERDAS Bioseguridad
Hoy en día, se sabe que son numerosos los factores que favorecen la presencia y mantenimiento de Salmonella en las explotaciones, y la gran mayoría de ellos pueden presentarse en cualquiera de las fases anteriores, dificultando enormemente el control de esta infección. Estos factores podrían agruparse en cuatro categorías principales: bioseguridad, higiene, estrés y alimentación (Figura 1)
En este periodo es fácil recoger muestras, ya sea en la granja (sangre y heces), o en el momento del sacrificio (sangre, jugo de carne, contenido gastrointestinal, nódulos linfáticos mesentéricos, amígdalas o las propias canales) y monitorizar la infección.
La mayoría de los programas de control se han centrado en esta fase al final de la cadena productiva, implementándose en ese momento diferentes acciones para intentar reducir la infección en la explotación.
Higiene CEBO MATADERO
Esta podría haber sido una de las razones que han dificultado el éxito de estos programas pues, para controlar la infección, seguramente debamos también entender mejor lo que ocurre en periodos anteriores.
FIGURA 1
EPIDEMIOLOGÍA 37
S
Cebo
Lactación Transición
Sacrificio
LACTACIÓN TRANSICIÓN Estrés
La mayoría de los factores de riesgo de salmonelosis porcina están presentes en todas las fases de la cadena de producción porcina. (limpieza y desinfección) Alimentación Fisiología/Inmunología
¿QUÉ SABEMOS DE LA SALMONELOSIS EN LACTACIÓN Y TRANSICIÓN ?

Existe una escasa información sobre la epidemiología de la salmonelosis porcina durante la lactación y transición, a pesar de que son dos épocas de gran riesgo para los animales.
Los lechones nacen prácticamente desprotegidos, en un ambiente posiblemente contaminado por Salmonella (un 30% de las explotaciones de madres son positivas a Salmonella en la UE según el estudio de la EFSA, y más del 60% en España), y necesitan urgentemente de la inmunidad maternal obtenida a través del calostro.
LA TRANSICIÓN ES SEGURAMENTE CUANDO MÁS SE EVIDENCIA LA DISMINUCIÓN DE LOS NIVELES DE ANTICUERPOS
MATERNALES (BIANCHI ET AL., 1995)
A pesar de todo, son escasos los trabajos que han estudiado la prevalencia de esta infección en estas fases tempranas. Y es que, si se quisiera determinar con cierta precisión la prevalencia de infección por Salmonella en lechones de explotaciones comerciales, se requeriría del sacrificio (posiblemente poco ético) de un gran número de animales jóvenes. Tras el destete, los lechones vuelven a ser muy vulnerables a patógenos entéricos, pues la colonización intestinal por estas bacterias se ve favorecida por dos factores principales:
1 2
Así, ingestión de calostro y de Salmonella pueden ocurrir casi simultáneamente en el caso de que la cerda esté infectada y haya excretado la bacteria por las heces en ese periodo de estrés asociado con el parto.
La disbiosis intestinal generada por el cambio de dieta.
El estrés asociado a un nuevo entorno, al ser separados de la madre y mezclados con otros lechones (Campbell et al., 2013)
Nº 4 | Abril 2022 DIAGNÓSTICO
su control? 38
Salmonelosis porcina: la infección en lechones, ¿el eslabón olvidado para
Solo hay algún estudio que estima la proporción de lechones que eliminan Salmonella en grupos de animales muy concretos y, generalmente, los resultados publicados suelen indicar una baja proporción de animales excretores (Funk et al, 2001; Baber et al., 2002)
La cuestión entonces es saber si estos resultados reflejan una realidad o podrían estar sesgados por el tipo de muestra analizada y/o las circunstancias que rodean esos periodos.
En el caso de lechones lactantes, la muestra típica analizada en estos estudios se obtenía mediante hisopos rectales, lo que implicaba la obtención de una pequeña cantidad de heces que podría limitar la sensibilidad de la bacteriología (Funk et al., 2000).
En el inicio de la transición, sin embargo, aunque la cantidad de materia fecal a analizar podría haber sido mayor, es habitual el uso de antimicrobianos en el pienso/agua (colistina –hasta hace poco-, y óxido de zinc) que estarían dificultando la detección de la bacteria. Así, es muy escasa y, seguramente, sesgada la información que tenemos sobre esta infección en estos dos periodos.
PREVALENCIA DE SALMONELLA EN LECHONES DESTETADOS
En este artículo se presentan los resultados de un estudio que tuvo como principal objetivo estimar la prevalencia de infección por Salmonella en lechones al destete en granjas comerciales.
Para ello, se aprovechó de la existencia en España de mataderos especializados en el sacrificio de lechones para consumo.
MATERIAL Y MÉTODOS MATERIAL Y MÉTODOS
Para estimar la prevalencia de infección por Salmonella en este tipo de animales se analizaron lechones sacrificados para consumo humano en mataderos comerciales. En España se sacrificaron casi dos millones de lechones para consumo en 2018 (MAPAMA, 2020).

Se trata generalmente de lechones entre 4 y 6 semanas de vida con un peso medio de 7,5 kg. Estos animales están libres de antibióticos, pues no pueden tratarse antes de su sacrificio.
Los lechones procedían de 5 explotaciones que presentaban valores medios de seroprevalencia a Salmonella >50%.
Los resultados obtenidos deberían ayudarnos a entender lo que puede estar ocurriendo con la salmonelosis porcina en esas fases iniciales de la cadena de producción, cuando además intervienen algunos factores inmunológicos y fisiológicos exclusivos de los animales en este periodo (Figura 1).
EPIDEMIOLOGÍA 39
MUESTREO ANÁLISIS
En el matadero, los lechones se seleccionaban aleatoriamente del lote que se sacrificaba el día del muestreo y de cada lechón seleccionado se recogía el paquete gastrointestinal completo. De ahí se obtenían nódulos linfáticos mesentéricos (NLM) y contenido intestinal (CI) para la detección de Salmonella.

Se recogía un pedazo de músculo diafragmático para la obtención de jugo muscular (JM) para la detección de anticuerpos frente a Salmonella (Figura 2).
A lo largo de los dos años del estudio, se fueron recogiendo cada 3-4 meses muestras fecales individuales de cerdas de la explotación y muestras de heces (pools) de las naves de cebo para la detección e identificación de los serotipos de Salmonella circulantes.

Se recogieron muestras de suero para monitorizar la seroprevalencia frente a Salmonella en cerdas y cebo.
Las salmonelas aisladas, tanto de lechones como de cerdas y animales de cebo, se enviaron a serotipar al Laboratorio de Referencia para Salmonelosis Animales en Algete, Madrid.


Posteriormente, se realizó el tipado molecular de algunos de los serotipos coincidentes encontrados, tanto en lechones (NLM y CI) como en cerdas y naves de cebo (heces), mediante la técnica de electroforesis por campos pulsados (PFGE) en la Facultad de Veterinaria de Zaragoza.

Los NLM y CI obtenidos de cada lechón se pesaban y se procesaban para el aislamiento de Salmonella siguiendo la norma ISO 6579:2002/Amd 1:2007.


El JM se analizó mediante un ELISA indirecto (ELISA HerdCheck Salmonella, IDEXX, ME, USA) y se determinó el porcentaje de densidad óptica (%DO) de cada lechón como indicador del nivel de anticuerpos maternales frente a Salmonella.
En este caso, un animal se consideró seropositivo cuando el porcentaje de densidad óptica (%DO) obtenido en la prueba de ELISA fue ≥40.
Lechones destetados (4 semanas)
Lechones inicio transición (6 semanas)
≥ 7 kg
FIGURA 2
Esquema de la toma de muestras para la determinación de la prevalencia de Salmonella en lechones al destete.
Sacrificio
Contenido intestinal (CI) Nódulos linfáticos mesentéricos (NLM)
Jugo muscular (JM)
Nº 4 | Abril 2022
Salmonelosis porcina:
infección
su control? 40
Laboratorio
DIAGNÓSTICO
la
en lechones, ¿el eslabón olvidado para
RESULTADOS Y DISCUSIÓN RESULTADOS Y DISCUSIÓN
MADRES Y CEBO
En las 5 explotaciones se aisló con regularidad Salmonella en las heces de las cerdas, así como en las muestras de heces de las naves de cebo (Tablas 1 y 2) Igualmente, la seroprevalencia se mantuvo muy alta en las cerdas (72% de media), aunque algo más baja en los animales de cebo (24,2%).
ESTOS RESULTADOS
TABLA 1
Frecuencia de aislamiento de Salmonella en cerdas y seroprevalencia frente a Salmonella en las explotaciones del estudio.
TABLA 2
Frecuencia de aislamiento de Salmonella en muestras de heces de naves de cebo y seroprevalencia frente a Salmonella en animales de cebo en las explotaciones del estudio.
Los principales serotipos identificados en las muestras de madres y animales de cebo se presentan en la Figura 3
de serotipos en lechones, cerdas y animales de cebo.
El serotipo predominante fue Rissen, seguido de Kapemba, Anatum, Derby, Brandenburgo y la variante monofásica de Typhimurium. Entre estos serotipos, los de mayor interés por su impacto en Salud Pública serían la variante monofásica de Typhimurium, Derby y, en menor medida, Rissen
EN LAS
MADRES
INDICABAN QUE SALMONELLA CIRCULABA CONSISTENTEMENTE TANTO
EXPLOTACIONES DE
COMO EN LAS NAVES DE CEBO DURANTE LA DURACIÓN DEL ESTUDIO
24,6% 39,1% 8,05% 1,2% 1,2% 10,3% 10,3% 11,5% 1,2% 12,6% 33,9% 2,1% 0,4% 7,5% 7,5% 1,4% 4,6% 0,7%7,5% 1,1% 0,4% 0,4% LECHONES CERDAS Y CEBO Rissen Monofásica Typhimurium London Brandenburg Derby Anatum Goldcoast Kapemba Agona Ohio Infantis FIGURA 3
Granja Nº muestras fecales Nº muestras fecales + (%) Nº muestras de suero Seroprevalencia (%) A 40 16 (40,0) 144 56,9 B 40 9 (22,5) 134 85,8 C 40 13 (32,5) 134 73,1 D 47 1 (2,1) 158 81,6 E 47 8 (17,0) 116 60,3 Total 214 47 (21,9) 686 72 Granja Nº pools de heces Nº pools de heces + (%) Nº muestras de suero Seroprevalencia (%) A 32 14 (43,8) 91 31,9 B 24 6 (25,0) 90 27,8 C 32 12 (37,5) 90 21,1 D 57 10 (17,5) -E 46 9 (19,6) 150 19,3 Total 191 51 (26,7) 421 24,2 EPIDEMIOLOGÍA 41
Distribución
LECHONES
Se analizaron un total de 884 lechones:
495 lechones recién destetados (4 semanas de vida).
389 lechones tras pasar dos semanas en la nave de transición hasta alcanzar un mínimo de 7 kg.
En la Tabla 3 se pueden observar los resultados de infección (Salmonella en NLM) y excreción (Salmonella en CI) para ambos tipos de lechones.
Se observaron prevalencias de infección y excreción muy altas (36%) y similares en ambos grupos, indicando que los lechones a estas edades se infectan con Salmonella sin necesidad de presentar signos clínicos y, por tanto, actúan como portadores activos (diseminadores) de la bacteria.
La proporción de lechones excretando Salmonella fue muy superior a lo observado en otros estudios, pero en este caso la cantidad de heces que se pudieron analizar fue muy superior a la que se hubiera obtenido con un hisopo.
Esto justificaría la mayor sensibilidad del cultivo bacteriológico en este estudio y, por lo tanto, la mayor prevalencia de excreción.
Además, el hecho de que se tratara de animales destinados a matadero pudo influir en una mayor eliminación de Salmonella debido al estrés generado durante el transporte y la espera previa al sacrificio (Scherer et al., 2008)
Es interesante destacar que, dentro del grupo de los animales de 4 semanas de vida, la cantidad de NLM analizada fue significativamente superior en los animales que resultaron infectados que en los no infectados (8,2 g y 7,3 g, respectivamente; P<0.001), sugiriendo de nuevo que la cantidad de muestra analizada era un factor importante para la detección de Salmonella en lechones subclínicamente infectados (Funk et al., 2000).

Como era de esperar, se observó una relación significativa entre la presencia de Salmonella en NLM y la probabilidad de excretar la bacteria en heces (CI).
Un lechón infectado (NLM positivo) presentó una probabilidad 10 veces superior de excretar Salmonella (CI positivo) que un lechón NLM negativo (Figura 4).
Relación entre infección con Salmonella y excreción de la bacteria en lechones (de 4 y 6 semanas tomados en conjunto).
71,6% 28,4% 83,39% 16,1%
INFECCIÓN VS. EXCRECIÓN Lechones infectados (n=320) Lechones no infectados (n=564)
Excretores No excretores
TABLA 3
Detección de Salmonella a partir del contenido intestinal (CI) y nódulos linfáticos mesentéricos (NLM) de lechones de 4 y 6 semanas de edad.
FIGURA 4
Lechones 4 semanas de vida Lechones 6 semanas de vida Granja Nº Nº CI+ (%) Nº NLM+ (%) Nº Nº CI+ (%) Nº NLM+ (%) A 105 30 (28,6) 19 (18,1) 96 39 (40,6) 47 (48,9) B 118 16 (13,6) 21 (17,8) 75 34 (45,3) 26 (34,7) C 99 36 (36,4) 29 (29,3) 89 26 (29,2) 34 (38,2) D 92 42 (45,7) 52 (56,5) 49 29 (59,2) 22 (44,9) E 81 51 (63,0) 57 (70,4) 80 14 (17,5) 16 (20,0) Total 495 175 (35,4) 178 (36,0) 389 142 (36,5) 145 (37,3) Nº 4 | Abril 2022 DIAGNÓSTICO Salmonelosis porcina: la infección en
olvidado para su control? 42
lechones, ¿el eslabón
Mediante la técnica de PFGE pudimos confirmar que, en el 97,5% (39) de los 40 lechones infectados que se analizaron, se encontró una alta homología genética (≥ 90%) entre los aislados de Salmonella obtenidos de NLM y aquellos obtenidos de CI.

Este resultado, y el hecho de que los lechones no presentaran signos clínicos de enfermedad, indicaban sin lugar a dudas el importante papel de estos animales en el mantenimiento de la infección por Salmonella en estas explotaciones.
En estudios experimentales se ha demostrado que la excreción es particularmente importante durante las dos primeras semanas tras la primo infección (Scherer et al., 2008; Pires et al., 2013) por lo que, en este caso, es muy probable que los lechones se hubieran infectado en algún momento en las primeras semanas de lactación.
Respecto a los serotipos observados, se detectó una mayor variedad de serotipos en los lechones que en los animales adultos o de cebo (Figura 3), aunque en esta diferencia pudo influir el menor número de muestras positivas analizadas en este segundo grupo.
En cualquier caso, cabe destacar que la mayoría (82%) de los serotipos detectados en cerdas y cebos se detectaron también en los lechones, aunque con una frecuencia de presentación diferente.
Los valores de %DO fueron significativamente superiores en los lechones de 4 semanas de vida (mediana %DO= 15,5) con respecto a los de 6 semanas de vida (mediana %DO=4,7; P<0,001), indicando una importante reducción de los anticuerpos maternales frente a Salmonella entre las 4 y 6 semanas de vida.
En el caso particular de los lechones de 4 semanas, el valor de %DO fue significativamente superior en los lechones no infectados por Salmonella comparado con los infectados (17,3 vs. 12, respectivamente; P=0,002), lo que sugería el posible efecto protector de la inmunidad maternal.
Este efecto no se observó a las 6 semanas de vida, probablemente debido a que los niveles de anticuerpos eran ya muy bajos (Figura 5).
No infectados 4,8 17,3 12 4,7 0 2 4 6 8 10 12 14 16 18 20 Infectados 4 semanas 6 semanas %D0 (mediana)
FIGURA 5
Valores de %DO y su relación con la infección por Salmonella según la edad de los lechones.
EPIDEMIOLOGÍA 43
RELACIÓN ENTRE AISLADOS DE SALMONELLA DETECTADOS EN LECHONES Y EN MADRES O ANIMALES DE CEBO
Como análisis final, se compararon genéticamente aislados del mismo serotipo obtenidos de lechones, cerdas y naves de cebo. La técnica de PFGE permitió identificar cepas genéticamente similares (>90% homología) entre lechones de 4 semanas y cerdas adultas en 4 de las explotaciones estudiadas.
Estos aislados perduraban en la explotación largos periodos de tiempo, encontrando la misma cepa en muestreos realizados con una diferencia de 200 días o más, lo que reforzaría la importancia de la transmisión madre-lechón y el papel de estos en el mantenimiento de la contaminación en la explotación.
También se detectaron aislados genéticamente similares entre lechones de 6 semanas de vida (principio de transición) y muestras obtenidas de las naves de cebo de las 4 explotaciones donde se pudieron comparar este tipo de aislados.
Esta relación se detectó para los tres serotipos más predominantes en las naves de cebo (Rissen, Derby y la variante monofásica de Typhimurium), lo que sugería el mantenimiento de la infección entre la fase de transición y la de cebo.
No se detectó un patrón temporal particular de infección entre lechones y naves de cebo, de forma que un determinado aislado de Salmonella podía encontrarse al mismo tiempo en transición y cebo, o primero en los lechones y después en el cebo, o viceversa, sugiriendo la existencia de contaminación cruzada entre fases y/o la falta de una higiene adecuada de los corrales en estas explotaciones.
CONCLUSIONES
En explotaciones comerciales con alta seroprevalencia, la prevalencia de salmonelosis en lechones en el periodo alrededor del destete puede ser muy alta. Los lechones pueden infectarse de forma subclínica y actuar como portadores activos de Salmonella, estando el origen de la infección muy probablemente en las madres.
Los resultados del estudio también apuntan a la importancia del calostro en la protección de los lechones frente a esta infección.
Las relaciones genéticas entre aislados sugieren la existencia de una transmisión de Salmonella de madres a lechones que alcanza a su vez a los animales en el cebo.
Por todo ello, reducir la excreción de Salmonella de las cerdas a su entrada en maternidad, mejorar la calidad del calostro y garantizar su adecuada ingestión por los lechones, deberían considerarse como estrategias útiles para reducir los niveles de infección durante la lactación, lo que seguramente redundará en una menor prevalencia de Salmonella en la fase de cebo.
BIBLIOGRAFÍA
Argüello H, Álvarez-Ordoñez A, Carvajal A, Rubio P, Prieto M. 2013. Role of slaughtering in Salmonella spreading and control in pork production. J Food Prot 76:899–911.
Barber DA, Bahnson PB, Isaacson R, Jones CJ, Weigel RM. 2002. Distribution of Salmonella in swine production ecosystems. J Food Prot 65:1861–1868.
Bianchi AT, Moonen-Leusen HW, van der Heijden PJ, Bokhout BA. 1995. The use of a double antibody sandwich ELISA and monoclonal antibodies for the assessment of porcine IgM, IgG and IgA concentrations. Vet Immunol Immunopathol 44:309–317
Campbell JM, Crenshaw JD, Polo J. 2013. The biological stress of early weaned piglets. J Anim Sci Biotechnol 4:19.
EFSA. 2008. Report of the Task Force on Zoonoses Data Collection on the analysis of the baseline survey on the prevalence of Salmonella in slaughter pigs. Part A. EFSA J 135: 1-111.
EFSA. 2009. Analysis of the baseline survey on the prevalence of Salmonella in holdings with breeding pigs, in the EU. Part A. EFSA J 7 (12): 93 pp.
Funk JA, Davies PR, Nichols MA. 2000. The effect of fecal sample weight on detection of Salmonella enterica in swine feces. J Vet Diagn Invest 12:412–418.
Funk JA, Davies PR, Nichols MA. 2001. Longitudinal study of Salmonella enterica in growing pigs reared in multiple-site swine production system. Vet Microbiol 83:45–60.
Lundbeck H, Plazikowski U, Silverstolpe L. 1955. The Swedish Salmonella outbreak of 1953. J App Microbiol 18: 535–548.
MAPAMA. 2020. El sector de la carne de cerdo en cifras: principales indicadores económicos 2019. Ministerio de Agricultura y Pesca, Alimentación y Medio Ambiente, España. https://www.mapa.gob.es/es/ ganaderia/estadisticas/indicadoreseconomicoscarnedecerdo2019_tcm30-379728.pdf. Consultado el 22 de junio de 2021.
Mousing J, Jensen PT, Halgaard C, Bager F, Feld N, Nielsen B, Bech-Nielsen, S. 1997. Nation-wide Salmonella enterica surveillance and control in Danish slaughter swine herds. Prev Vet Med 29: 247–261.
Pires AF, Funk JA, Bolin CA. 2013. Longitudinal study of Salmonella shedding in naturally infected finishing pigs. Epidemiol Infect 141: 1928–1936.
Scherer K, Szabó I, Rösler U, Appel B, Hensel A, Nöckler K. 2008. Time course of infection with Salmonella typhimurium and its influence on fecal shedding, distribution in inner organs, and antibody response
in fattening pigs. J Food Prot 71:699–705.
Nº 4 | Abril 2022 Salmonelosis porcina:
olvidado para su control? 44 DIAGNÓSTICO
la infección en lechones, ¿el eslabón




Determinar el estatus Control del progreso Definir medidas Ceva Salud Animal S.A. Avda. Diagonal 609-615 pl. 9 08028 Barcelona España - www.ceva.es - Tel. +34 932920660 - ceva.salud-animal@ceva.com Salmonella: desenmascárala, combátela. Vacunación de cerdas y lechones www.stop-salmonella.com Enfoque integral, enfoque One Health Bioseguridad V ac unac ió n M an ejo Control de salmonella Tu plan de control en 3 pasos: Ceva Salud Animal S.A. Avda. Diagonal 609-615 pl. 9 - 08028 Barcelona, España - www.ceva.es - Tel. +34 932920660 - ceva.salud-animal@ceva.com Ficha técnica
A USO RACIONAL DE ANTIMICROBIANOS EN PORCINO: ANTIMICROBIANOS QUE ACTÚAN INHIBIENDO LA SÍNTESIS DE PROTEÍNAS - PARTE I


El uso racional de los antimicrobianos en Medicina Humana y Veterinaria es una pieza clave en la lucha contra el auge de las bacterias multirresistentes. Así, para cumplir con la regla de usar los antimicrobianos “tan poco como sea posible, tanto como sea necesario”, es imprescindible conocer los mecanismos y espectro de acción de estos compuestos para maximizar su eficacia y minimizar el desarrollo de resistencias.
Juan A. Gilabert, Sonia Rubio, Mª Dolores San Andrés y Manuel I. San Andrés.


Sección Dptal. de Farmacología y Toxicología, Facultad de Veterinaria, Universidad Complutense de Madrid
En la primera parte de este artículo se abordan las clases de antibióticos que basan su mecanismo de acción en la inhibición de la síntesis proteica (Figuras 1 y 2) asociada a la subunidad ribosomal 30S (aminoglucósidos y tetraciclinas), centrándonos en las más relevantes en el tratamiento de las enfermedades infecciosas que afectan al ganado porcino.

EE
Nº 4 | Abril 2022 ANTIMICROBIANOS Uso racional de antimicrobianos en porcino: Antimicrobianos que actúan inhibiendo la síntesis de proteínas – Parte I 46
Descarga el PDF
FIGURA
Esquema que muestra cómo en un ribosoma (subunidades grande y pequeña), un mRNA y muchas moléculas de tRNA trabajan juntas para producir péptidos o proteínas. (Modificado de LadyofHats – Wikimedia Commons).


ANTIBIÓTICOS INHIBIDORES DE LA SÍNTESIS DE PROTEINAS QUE EJERCEN SU ACCIÓN SOBRE LA SUBUNIDAD 30S

Los aminoglucósidos (AG) son compuestos naturales obtenidos de actinomicetos del suelo o productos semisintéticos derivados de ellos.
Tienen una estructura central formada por aminoazúcares unidos por enlaces glucosídicos a un aminociclitol dibásico, que suele ser 2-desoxiestreptamina.
Los aminoglucósidos se clasifican en cuatro subclases según la identidad del resto aminociclitol:
1 2 3 4
Sin desoxiestreptamina (p. ej., estreptomicina, que tiene un anillo de estreptidina).
Un anillo de desoxiestreptamina monosustituido (p. ej., apramicina).
Un anillo de desoxiestreptamina 4,5-disustituido (p. ej., neomicina, ribostamicina).
Un anillo de desoxiestreptamina 4,6-disustituido (p. ej., gentamicina, amikacina, tobramicina y plazomicina).
A
1
FIGURA 2
Alteración de la síntesis proteica bacteriana mediante la unión a la subunidad 30S.
AMINOGLUCÓSIDOS AMINOGLUCÓSIDOS
Aminoglucósido / Tetraciclina Proteína defectuosa mRNA tRNA Aminoácidos Unidad grande Unidad pequeña Sitio A Sitio P Subunidad 30S P A rRNA 16S ONE HEALTH 47
Nuevas proteínas formadas
ESPECTRO DE ACCIÓN
Los aminoglucósidos son activos frente a microorganismos Gram positivos (Gram+) y Gramnegativos (Gram-).
Son muy efectivos frente a Enterobacteriaceae, incluidos Escherichia coli, Klebsiella pneumonie y K. oxytoca, Enterobacter cloacae y E. aerogenes, Providencia spp , Proteus spp , Morganella spp y Serratia spp. Además, son activos contra Yersinia pestis y Francisella tularensis, Staphylococcus aureus, incluidos aislados resistentes a la meticilina y resistentes a la vancomicina e intermedios, P. aeruginosa y, en menor medida, Acinetobacter baumannii También, son susceptibles Mycobacterium tuberculosis, M. fortuitum, M. chelonae y M. avium
Puesto que, para la absorción de los aminoglucósidos en las células, es necesario el transporte de electrones (dependiente de oxígeno), carecen de actividad frente a bacterias anaerobias y también son ineficaces frente a Streptococcus spp. y Enterococcus spp.

MECANISMO DE ACCIÓN
El mecanismo de acción de los AG se basa en inhibir la síntesis de proteínas al unirse, con alta afinidad, al sitio A en el rRNA 16S en la subunidad 30S (Figura 2)
Como resultado de esta interacción, el antibiótico provoca la traducción incorrecta, dando como resultado una síntesis proteica errónea, permitiendo que los aminoácidos incorrectos se ensamblen en un polipéptido que, posteriormente, se liberará dañando la membrana celular
Algunos aminoglucósidos también pueden afectar a la síntesis de proteínas, bloqueando la elongación o inhibiendo directamente el proceso de iniciación.
Todos los aminoglucósidos son bactericidas y, normalmente, tienen un efecto postantibiótico (PAE) prolongado. Se ha demostrado que el PAE está directamente relacionado con el tiempo que tardan las bacterias en recuperarse de la inhibición de la síntesis de proteínas.

La entrada de aminoglucósidos en las células bacterianas se lleva a cabo en tres etapas distintas:
La primera etapa aumenta la permeabilidad de la membrana bacteriana.
La segunda y tercera etapa dependen de la energía.
Nº 4 | Abril 2022 ANTIMICROBIANOS Uso racional de antimicrobianos en porcino: Antimicrobianos que actúan inhibiendo la síntesis de proteínas – Parte I 48
ETAPA 1
La primera etapa implica la unión electrostática del aminoglucósido a los componentes cargados negativamente de la membrana bacteriana.
Estos cationes son responsables de la formación de puentes cruzados y de la estabilización de los componentes lipídicos de la membrana bacteriana y su eliminación conduce a la ruptura de la membrana externa, y, por tanto, a una mayor permeabilidad y al inicio del proceso de absorción del aminoglucósido.
ETAPAS 2 Y 3
La molécula es transportada activamente a través de la membrana citoplasmática (membrana interna) hacia el interior de la célula por medio de un mecanismo dependiente del oxígeno (fase I energía-dependiente).
El transporte está acoplado a una bomba de protones y el gradiente electroquímico transmembrana provee la energía para este proceso.
Esta es una fase limitante.
Este fenómeno facilita la entrada al citoplasma a través de un proceso lento, dependiente de la energía y mediado por el transporte de electrones.
CARACTERÍSTICAS FARMACOCINÉTICAS
Las características farmacocinéticas de los AG se basan en su escasa o nula absorción vía oral y, por lo tanto, se administran en su mayoría por vía intravenosa o intramuscular, a no ser que queramos obtener una acción a nivel gastrointestinal (GI).
Los cationes bivalentes (Ca2+ y Mg2+), el pH extracelular bajo, las condiciones de anaerobiosis e hiperosmolaridad reducen este gradiente y pueden inhibir o bloquear el transporte. Por lo tanto, la actividad de los aminoglucósidos se ve marcadamente reducida en el ambiente ácido y anaeróbico de un absceso o en la orina hipermolar.
El transporte puede verse favorecido por fármacos activos sobre la pared bacteriana, tales como la penicilina o la vancomicina. Esto podría representar la base molecular del sinergismo de potenciación observado con tales fármacos.
Presentan una amplia distribución en los tejidos, incluido el pulmón, y se eliminan rápidamente a través del riñón, lo que también hace que estos fármacos sean ideales para el tratamiento de infecciones del tracto urinario.
Estos antibióticos se comportan como bactericidas concentración-dependiente. Por tanto, el objetivo debe ser administrar la dosis más alta posible con la menor toxicidad.
Se ha demostrado que la dosificación una vez al día o de intervalo prolongado, aprovecha tres características de los aminoglucósidos:
Muerte dependiente de la concentración
Eliminación rápida
PAE prolongado
La inhibición de la síntesis de proteínas y la mala traducción de proteínas se produce una vez que las moléculas de aminoglucósidos acceden al citoplasma. Estas proteínas mal traducidas se insertan en la propia membrana citoplasmática y la dañan, facilitando la posterior entrada de aminoglucósidos con una rápida absorción de moléculas en el citoplasma, mayor inhibición de la síntesis de proteínas y muerte celular acelerada.
Las dosis más altas aumentan las concentraciones y minimizan la toxicidad al permitir un período de tiempo en el que hay poco o ningún fármaco en circulación.
Por tanto, la dosificación una vez al día se asocia con una nefrotoxicidad reducida y una eficacia igual.
ONE HEALTH 49
LA ADMINISTRACIÓN INHALADA DE AMINOGLUCÓSIDOS
SE HA CONVERTIDO EN UNA ADMINISTRACIÓN DE INTERÉS PORQUE
PERMITE UNA MAYOR
EXPOSICIÓN LOCAL
DENTRO DE LOS PULMONES CON UNA TOXICIDAD SISTÉMICA REDUCIDA
MECANISMOS DE RESISTENCIA
La resistencia a los aminoglucósidos toma muchas formas diferentes, incluida la modificación enzimática, la modificación del sitio diana a través de una enzima o una mutación cromosómica o de las bombas de eflujo.
Cada uno de estos mecanismos tiene efectos variables en diferentes miembros de la clase y, a menudo, son varios los mecanismos que están implicados.
MODIFICACIÓN ENZIMÁTICA DE FÁRMACOS
Los AME (enzimas modificadoras de aminoglucósidos) a menudo se encuentran en plásmidos que contienen múltiples elementos de resistencia, incluidos otros AME o β-lactamasas.
Se han descrito más de 100 AME y se clasifican ampliamente en tres grupos en función de su capacidad para acetilar, fosforilar o adenilar grupos amino o hidroxilo que se encuentran en varias posiciones alrededor del eje central de aminoglucósidos.
Estas modificaciones disminuyen la afinidad de unión del fármaco por su diana y conducen a una pérdida de potencia antibacteriana.
MODIFICACIÓN DEL SITIO DIANA
Se produce a través de la acción de las metiltransferasas (RMT) del rRNA 16S. Estas enzimas modifican residuos de nucleótidos de rRNA específicos de forma que bloquean la unión eficaz de los aminoglucósidos a su objetivo.

RESISTENCIA MEDIADA POR BOMBAS DE EFLUJO
Se ha demostrado que existen transportadores homólogos en algunas bacterias que participan en la salida del aminoglucósido.
EFECTOS ADVERSOS
Como efectos adversos, los aminoglucósidos pueden tener efectos negativos sobre la función renal. Su administración a animales que sufren alteraciones renales o en combinación con sustancias que también afecten a la función renal puede provocar riesgo de intoxicación.
Además, pueden provocar bloqueo neuromuscular, por lo que se recomienda tener en cuenta este efecto al anestesiar los animales tratados.
No se ha demostrado la seguridad del medicamento durante la gestación ni la lactación en lechones. Tampoco se recomienda su uso en animales menores de un mes.
TODOS LOS AMINIGLUCÓSIDOS, EXCEPTO ESPECTINOMICINA, PUEDEN PROVOCAR TOXICIDAD RENAL Y ÓTICA Y, RARAMENTE, BLOQUEO
NEUROMUSCULAR
Nº 4 | Abril 2022 ANTIMICROBIANOS Uso racional de antimicrobianos en porcino: Antimicrobianos que actúan inhibiendo la síntesis de proteínas – Parte I 50
INDICACIONES TERAPEÚTICAS
Los AG se usan como agentes únicos y también en combinación con otros antibióticos, tanto en terapia empírica como definitiva, para gran cantidad de patologías:
Pielonefritis aguda
Infecciones respiratorias (neumonía)
Infección intra-abdominal
Endocarditis infecciosa
Neutropenia febril
Endoftalmitis
Otitis externa maligna
Osteomielitis
Meningitis postquirúrgica
Brucelosis, listeriosis y tuberculosis
PRINCIPALES
AMINOGLUCÓSIDOS DE USO EN PORCINO
APRAMICINA (CATEOGORÍA C; EMA, AEMPS)
Existen 3 formulaciones comercializadas en forma de apramicina sulfato
Las tres están autorizadas para porcino, 1 en forma de premezcla medicamentosa y 2 en forma de polvo para administración con agua de bebida o leche.
La apramicina es efectiva frente a bacterias Gram-, como Salmonella y Escherichia coli, y está indicado su uso para el tratamiento de la colibacilosis, enteritis infecciosa y gastroenteritis.

La apramicina por vía oral (VO) se absorbe poco, por lo que solo se utiliza para infecciones que asientan a nivel gastrointestinal (GI).
No obstante, dicha absorción puede aumentar en recién nacidos, animales jóvenes y en los animales con la barrera intestinal alterada.
Se excreta principalmente a través de heces y muy poca cantidad en la orina.
En cuanto a los tiempos de espera marcados, por supuesto depende de la dosis administrada, pero de forma general para los preparados que se administran en el agua de bebida suele ser de 7 días y de 21 si se ha usado una formulación en forma de premezcla.
ONE HEALTH 51
ESTREPTOMICINA (CATEGORIA C)
Existen 9 formulaciones comercializadas en forma de dihidroestreptomicina sulfato de las cuales 6 están autorizadas para porcino: 4 asociadas a bencilpenicilina procaína, 1 además a dexametasona y 1 se presenta como monocomponente.
Como único componente presenta un espectro sólo contra Leptospira spp.
La dihidroestreptomicina se excreta principalmente por orina y no debe ser administrada junto con otros antibióticos bacteriostáticos, pentobarbital, ni anestésicos inhalatorios (por existir riesgo de depresión vascular), relajantes musculares (por riesgo de bloqueo neuromuscular) ni diuréticos renales (por riesgo de aumentar la ototoxicidad).
El tiempo de espera tras la administración de estreptomicina en carne es de 73 días.
En asociación con dexametasona en suspensión inyectable para administración intramuscular (IM)
El espectro es frente a Actinobacillus pleuropneumoniae y/o Pasteurella multocida, Streptococcus suis, Listeria monocytogenes y/o Haemophilus parasuis, estando indicado para meningitis y enfermedad de Glässer.
No se debe usar:
En caso de hipersensibilidad al ácido paraaminobenzoico (PABA), diabetes mellitus, animales con enfermedades degenerativas oculares o úlceras corneales, o con hiperadrenocorticismo (enfermedad de Cushing).

Durante el último tercio de la gestación y su empleo debe restringirse a procesos agudos, ya que no está recomendado patologías crónicas.
Durante más de 3 días consecutivos, continuando posteriormente el tratamiento con antibióticos sin corticosteroides.
El tiempo de espera de esta asociación en carne es de 68 días.
En asociación con bencilpenicilina procaína, solución inyectable para administración IM.
El espectro de acción se amplía a Escherichia coli, Klebsiella spp., Shigella spp., Proteus spp., Salmonella spp., Yersinia spp., Mycobacterium spp., Haemophilus spp., Brucilla spp., Campylobacter fetus.
Está indicada para el tratamiento de artritis, aborto (Brucella, Leptospira), leptospirosis, mal rojo, neumonía y bronconeumonía, síndrome mastitis-metritis-agalactia o MMA (termino propuesto en 1958 por Tharp y Amstutz, utilizado de forma rutinaria en España pero que, tras demostrase en la práctica que metritis y mamitis no siempre eran evidentes, se decidió definir como síndrome de disgalactia posparto o SDPP).
Con la asociación de ambos compuestos se logra una sinergia debido a un primer efecto de la penicilina sobre la pared celular bacteriana, permitiendo la penetración de la dihidroestreptomicina más fácilmente dentro de la célula, aumentando, por tanto, la eficacia de los dos compuestos por separado.
En lechones y cerdos de engorde, en situaciones de estrés este medicamento puede provocar fiebre transitoria, vómitos, incoordinación, temblores y apatía.
No se debe administrar junto con otros antibióticos bacteriostáticos y otros aminoglucósidos, pentobarbital
Nº 4 | Abril 2022 ANTIMICROBIANOS Uso racional de antimicrobianos en
que actúan inhibiendo la síntesis de proteínas – Parte I 52
porcino: Antimicrobianos
GENTAMICINA (CATEGORÍA C)
Existen 15 formulaciones comercializadas, de las cuales 5 están autorizadas para porcino en forma de gentamicina sulfato: 4 como monocomponente (3 para administrar con el agua de bebida y 1 para administración IM) y 1 de ellas asociadas con amoxicilina trihidrato para administración IM.
La presentación como monocomponente es activa frente a Escherichia coli no invasiva y está indicada frente a disentería y colibacilosis.
La presentación gentamicina/amoxicilina, además, es eficaz frente a Pasteurella multocida , Haemophilus parasuis y Actinobacillus pleuropneumoniae sensibles y está indicada para neumonías y colibacilosis.
La sinergia entre ambos antimicrobianos permite que la penetración de la gentamicina en la célula se incremente cuando la permeabilidad de la pared celular bacteriana es alterada por la amoxicilina. Este hecho permite el uso de cantidades más pequeñas del aminoglucósido.
El tiempo de espera para el monocomponente en agua de bebida es de 14 días en carne y 44 días en la administración IM. En la presentación gentamicina/amoxicilina para agua de bebida es de 84 días en carne.
NEOMICINA (CATEGORÍA C)
Existen 14 formulaciones comercializadas, de las cuales 9 están autorizadas para porcino en forma de neomicina sulfato: 3 se presentan en forma de polvo para administrar en el agua/leche, 4 en polvo para solución oral y 2 como premezcla medicamentosa.
La neomicina es activa frente a Escherichia coli, Klebsiella pneumoniae, Haemophilus influenzae, Proteus vulgaris, Salmonella spp., Shigella spp., Staphylococcus aureus, Streptococcus faecalis, Mycobacterium tuberculosis y Bacillus anthracis, estando indicada para el tratamiento de colibacilosis, salmonelosis, disentería vibriónica y enfermedad de los edemas causadas por microorganismos sensibles a la neomicina.
Su uso prolongado puede ocasionar síndrome de malabsorción y disbiosis intestinal. No se debe administrar con bloqueantes neuromusculares, anestésicos generales, antidiuréticos u otros aminoglucósidos.
En polvos para administración oral y para premezclas el tiempo de espera para carne es de 20 días y en la formulación para agua de bebida 1-3 días.
ESPECTINOMICINA (CATEGORÍA D)
La espectinomicina es un aminociclitol, ya que no contiene aminoazúcares, aunque comparte propiedades similares con los aminoglucósidos, pero con menos efectos tóxicos y con efecto bacteriostático.
Existen 13 formulaciones comercializadas de las cuales 11 están autorizadas para porcino: 8 en forma de espectinomicina sulfato con lincomicina hidrocloruro (2 para administración en agua/leche y 6 para IM), 1 en forma de lincomicina hidrocloruro junto con espectinomicina sulfato y bromhexina hidrocloruro para administración IM y 2 como monocomponente para administrar con agua/leche.
Es activo frente a bacterias Gram+ y Gram-, así como frente a Salmonella spp., Pasteurella multocida, Escherichia coli, Mycoplasma, estando indicada para el tratamiento de la disentería vibriónica, colibacilosis, neumonía enzoótica, salmonelosis y artritis infecciosa.
La combinación de espectinomicina y lincomicina tiene un efecto sinérgico, traduciéndose en una mayor eficacia frente a distintos procesos patológicos (disentería porcina) que la que tienen por separado. Los parámetros farmacocinéticos de la asociación prácticamente no se ven modificados, sobre todo la espectinomicina, coincidiendo con los que tienen cada uno por separado.
No se deben administrar conjuntamente con macrólidos ni aminoglucósidos ni tampoco en animales que padezcan infecciones preexistentes por Monilia spp
El tiempo de espera en carne es de 14 – 21 días.
La presentación como único componente de la espectinomicina se comercializa para agua de bebida y solo está indicada para tratamiento de las infecciones digestivas causadas por Escherichia coli sensible a la espectinomicina. El tiempo de espera en carne es de 6 días.
En el caso de la asociación de espectinomicina sulfato con lincomicina hidrocloruro junto con bromhexina hidrocloruro se indica también para pleuroneumonía causada por Actinobacillus pleuropneumoniae , siendo el tiempo de espera en este caso de 15 días en carne.
ONE HEALTH 53
TETRACICLINAS TETRACICLINAS
Las tetraciclinas constituyen una familia de productos naturales (clortetraciclina, oxitetraciclina, tetraciclina, demeclociclina) y semisintéticos (metaciclina, doxiciclina, minociclina, limeciclina, rolitetraciclina, tigeciclina, PTK 7906) derivados de diferentes especies de Streptomyces spp.
Cuentan con un núcleo hidronaftaceno, que contiene cuatro anillos fundidos al que se pueden unir distintos radicales que darán lugar a las diferentes tetraciclinas.
Actúan inhibiendo la síntesis de las proteínas bacterianas mediante la unión a la subunidad ribosomal 30S de las bacterias. Son bacteriostáticos, de uso habitual tanto en humana como veterinaria.
CLASIFICACIÓN DE LAS TETRACICLINAS
TETRACICLINAS DE PRIMERA GENERACIÓN

Son las más antiguas, las menos lipofílicas y las que peor se absorben.
En este grupo se incluyen:
Tetraciclina
Oxitetraciclina
Clortetraciclina
Demeclociclina
Limeciclina
Metaciclina
Rolitetraciclina
Todas, excepto rolitetraciclina, pueden administrarse por vía oral.
TETRACICLINAS DE SEGUNDA GENERACIÓN
Presentan una mejor absorción y son entre 3 y 5 veces más lipofílicas que las componentes del grupo anterior.
En este grupo se incluyen:
Doxiciclina
Minociclina Se pueden administrar por vía oral y también por vía intravenosa.
TETRACICLINAS DE TERCERA GENERACIÓN (GLICILCINAS)
Son análogos semisintéticos obtenidos tras modificar la posición 9 del anillo tetracíclico de los compuestos de las generaciones anteriores.
La tigeciclina es el 9-tertbutil-glicilamido derivado de la minociclina y constituye el principal representante de este nuevo grupo.
En esta tercera generación se incluyen nuevos compuestos en desarrollo, como las aminometilciclinas, de cuyo grupo ya ha pasado a experimentación humana la PTK 0796 para administración oral e intravenosa en una sola dosis diaria.
ejemplo de los llamados antibióticos de amplio espectro, con actividad frente a bacterias Gram+ y Gram-.
Su espectro de actividad comprende Rickettsias, Espiroquetas, Vibrio spp., Yersinia pestis, Francisella tularensis, Brucella spp., Bacillus anthracis, Plasmodium vivax, Plasmodium falciparum, Mycoplasma spp., Chlamydia y Chlamydophila spp., algunos Staphylococcus aureus resistentes a la meticilina, Coxiella burnetii y algunos protozoos.
Las tetraciclinas son el mejor
Nº 4 | Abril 2022 ANTIMICROBIANOS Uso racional de antimicrobianos en
de proteínas – Parte I 54
porcino: Antimicrobianos que actúan inhibiendo la síntesis
MECANISMO DE ACCIÓN CARACTERÍSTICAS FARMACOCINÉTICAS
El mecanismo de acción de las tetraciclinas se basa en inhibir la síntesis proteica de las bacterias. Se fijan a la subunidad 30S del ribosoma bacteriano (proteínas S7, S14, S19), impidiendo la unión del sitio aminoacil del ácido ribonucleico de transferencia a la subunidad 30S ribosomal (Figura 2), paralizando la incorporación de aminoácidos durante la síntesis proteica.
Atraviesan la membrana externa de las bacterias a través de porinas mediante difusión pasiva y llegan al citoplasma gracias a un mecanismo dependiente de energía.

Las glicilciclinas, entre las que se encuentra la tigeciclina, se fijan al mismo punto de unión del ribosoma bacteriano, pero la última lo hace con una fuerza 5 veces superior a la de la tetraciclina y la minociclina. Parece que esta fuerza de anclaje es la que permite a la tigeciclina vencer el mecanismo de resistencia ribosomal frente a las tetraciclinas clásicas.
LA FIJACIÓN DE TODAS
Las características farmacocinéticas de las tetraciclinas son variables.
Las tetraciclinas de primera y segunda generación se administran principalmente por vía oral, aunque tetraciclina, oxitetraciclina, doxiciclina y minociclina también pueden administrarse por vía intravenosa.
Las que se administran por vía oral se absorben de manera variable en el estómago y en el intestino delgado, dependiendo de cada tetraciclina.
Las de primera generación se absorben peor.
La doxiciclina y la minociclina son las que mejor se absorben (liposolubles), hasta casi un 90–100%, y en ellas no interfiere de forma significativa la alimentación. El resto se absorben peor y, por eso, es recomendable que se administren sin alimentos.
El hierro y otros medicamentos o compuestos que formen complejos quelantes o aumenten el pH del estómago (calcio, aluminio, bismuto, magnesio y omeprazol) interfieren en su absorción.
El volumen de distribución de estos agentes es variable, al igual que la unión con las proteínas plasmáticas, teniendo la doxiciclina y la minociclina mayor unión a las proteínas que la tetraciclina.

Difunden ampliamente en todos los tejidos y líquidos por su gran liposolubilidad, acumulándose en los huesos y los dientes, atravesando la barrera placentaria y excretándose en elevadas concentraciones en la leche.
Según su perfil farmacocinético pueden agruparse en 3 categorías:
Semivida corta (5–9h): clortetraciclina, oxitetraciclina y tetraciclina.
Semivida intermedia (10–14h): demeclociclina, limeciclina y metaciclina.
Semivida larga (16–18h): doxiciclina y minociclina (son las más liposolubles.
LAS TETRACICLINAS A LA SUBUNIDAD RIBOSOMAL ES REVERSIBLE, LO QUE EXPLICARÍA SU EFECTO BACTERIOSTÁTICO
ONE HEALTH 55
Todos, excepto la tetraciclina que presenta un metabolismo hepático, se eliminan sin metabolizar vía biliar y renal. La eliminación por orina varía según el compuesto, siendo muy escasa para la minociclina y la clortetraciclina, moderada-baja para la doxiciclina y aceptable para la tetraciclina, por lo que a excepción de las 2 primeras se alcanzan concentraciones terapéuticas en la orina para el tratamiento de infecciones urinarias por microorganismos sensibles. El resto, se elimina en las heces.
LA TIGECICLINA DE TERCERA GENERACIÓN
SOLO PUEDE ADMINISTRARSE EN INFUSIÓN INTRAVENOSA
Las tetraciclinas se comportan como antimicrobianos tiempodependiente, por tanto, la eficacia depende del tiempo en que la concentración del antibiótico esté por encima de la concentración mínima inhibitoria (CMI) T>CMI, teniendo un efecto postantibiótico prolongado.

MECANISMOS DE RESISTENCIA EFECTOS ADVERSOS
La resistencia a las tetraciclinas se produce al impedir la unión del antibiótico a la diana o mediante la expulsión del antibiótico al exterior de la célula por bombas de eflujo.
Los genes de resistencia se localizan en plásmidos, transposones conjugativos e integrones.
Junto al gen que confiere la resistencia a tetraciclinas se pueden encontrar otros genes (gene cassettes) que confieren resistencia a otros antibióticos, por lo que las tetraciclinas u otros antimicrobianos pueden seleccionar estas cepas multirresistentes. Los determinantes genéticos implicados en la resistencia a tetraciclinas son los genes tet y otr.
Los efectos secundarios más habituales son gastrointestinales. La intolerancia gastrointestinal (náuseas, vómitos, diarreas) es el efecto secundario más importante y es dependiente de la dosis. Todas las tetraciclinas pueden producir fotosensibilidad.
No deben administrarse tetraciclinas (excepto doxiciclina, minociclina y tigeciclina) a animales con insuficiencia renal previa, ya que pueden agravar esta insuficiencia.
También pueden provocar decoloración de los dientes.
Nº 4 | Abril 2022 ANTIMICROBIANOS Uso racional de antimicrobianos en porcino: Antimicrobianos que actúan inhibiendo la síntesis de proteínas – Parte I 56
INDICACIONES TERAPÉUTICAS
Las tetraciclinas son de primera elección en el tratamiento de la brucelosis y resultan útiles en el tratamiento de bronquitis crónica, carbunco, tularemia y en infecciones por espiroquetas, enfermedad de Lyme, en la fiebre recurrente (Borrelia spp.) y en el tratamiento y la profilaxis del paludismo causado por Plasmodium resistente a cloroquina.
Se recomiendan para una gran variedad de infecciones de transmisión sexual: uretritis no gonocócica, cervicitis, linfogranuloma venéreo (Chlamydia pecorum, suis) y granuloma inguinal (Calymmatobacterium granulomatis).
PRINCIPALES TETRACICLINAS DE USO EN PORCINO
CLORTETRACICLINA (CATEGORÍA D)
Existen 15 formulaciones comercializadas, 14 en porcino, en forma de clortetraciclina hidrocloruro: 7 en spray, 4 en suspensión para pulverización cutánea para uso tópico de heridas, infecciones podales y pedero, dermatitis digital e interdigital, infecciones de la pezuña, y 2 para premezcla medicamentosa para administración en el alimento.
La clortetracilina es activa frente a Actinobacillus pleuropneumoniae, Bordetella bronchiseptica, Erysipelothrix rhusiopathiae, Escherichia coli, Haemophilus parasuis, Leptospira spp., Lawsonia intracellularis, Mycoplasma spp., Pasteurella multocida y Streptococcus suis, estando indicada para el tratamiento de actinobacilosis, colibacibacilosis, complejo respiratorio porcino, estreptococosis, micoplasmosis y pasterelosis, disentería, neumonía enzoótica.
El uso de tetraciclinas durante el periodo de desarrollo de la dentición puede originar la decoloración de los dientes y, además, habrá que tener en cuenta que la absorción de la clortetraciclina puede quedar disminuida si se da conjuntamente con los alimentos ricos en cationes divalentes y trivalentes, sobre todo calcio, hierro, magnesio y cobre.
El efecto secundario más frecuente son los trastornos gastrointestinales, tales como diarrea.
Algunas presentaciones comerciales indican que en cerdos no se debe administrar 2 días antes y 10 después de vacunar frente al mal rojo, ya que suprime la inmunidad adquirida.
El tiempo de espera en carne es de 10 días.
DOXICICLINA (CATEGORÍA D)
Hay 62 formulaciones comercializadas, 44 en porcino: todas ellas en forma de doxiciclina hiclato excepto una que se formula combinada con bromhexina hidrocloruro, 34 se presentan para administrar con agua/leche, 7 en forma de premezcla y 3 inyectables IM.

Es eficaz contra Actinobacillus pleuropneumoniae, Mycoplasma hyopneumoniae, Pasteurella multocida,Mannheimiahaemolytica, Histophilus somni, Actinobacillus pleuropneumoniae y Streptococcus suis, estando indicada para el tratamiento de pleuroneumonía, neumonías, bronconeumonías o pasteurelosis.
En tratamientos muy prolongados, pueden aparecer alteraciones digestivas por disbiosis intestinal.
El tiempo de espera en carne para las presentaciones para premezcla es de 5 días, para las de administración con el agua de bebida 4 días y para las de administración IM 28 días.

ONE HEALTH 57
OXITETRACICLINA (CATEGORÍA D)
Existen 36 presentaciones comercializadas, 29 en porcino: 4 en forma de oxitetraciclina, 13 en forma de oxitetraciclina hidrocloruro y 12 oxitetraciclina dihidrato, de las cuales 6 se administran con el agua de bebida, 8 en premezcla, 1 en spray y 1 en solución para pulverización y 13 inyectables para administración intramuscular profunda.
Están indicadas frente a bacterias
Gram+ (Arcanobacterium pyogenes, Erysipelothrix rhusiopathiae, Staphylococcus spp. y Streptococcus spp. y bacterias
Gram-: Actinobacillus spp., Bordetella bronchiseptica, E. coli, Haemophilus parasuis, Histophilus somni, Mannheimia haemolytica, Pasteurella multocida, Klebsiella spp., Fusobacterium necrophorum y Prevotella melaninogenicus, Chlamydia spp. yMycoplasmaspp).
Se utilizan para el tratamiento de infecciones respiratorias, infecciones genitourinarias y síndrome MastitisMetritis-Agalactia o síndrome de disgalactia posparto, mal rojo (erisipela), así como en infecciones podales y tratamiento de apoyo de infecciones de heridas superficiales tras cirugía o lesiones físicas, como, por ejemplo, mordeduras de colas, rasguños y abrasiones.

BIBLIOGRAFÍA
AEMPS. Base de datos CIMAVET. Disponible en línea: https://cimavet.aemps.es/cimavet/publico/home.html
Calvo, J. & Martínez-Martínez, L. Mecanismos de acción de los antimicrobianos. Enferm Infecc Microbiol Clin. Vol. 27. Núm. 1. páginas 44-52 (enero 2009). DOI: 10.1016/j. eimc.2008.11.001
Dinos, G. P. The macrolide antibiotic renaissance. Br J Pharmacol. 2017 Sep; 174(18): 2967–2983. doi: 10.1111/ bph.13936
El uso de tetraciclinas en el periodo de desarrollo óseo y dental, incluyendo el último periodo de gestación, puede conducir a una decoloración de los dientes.
El tiempo de espera de las formulaciones inyectables es de 23 días en carne y en polvo 10 días.
TETRACICLINA (CATEGORÍA D)
Existen 5 presentaciones comercializadas, 2 para porcino en forma de tetraciclina hidrocloruro: una para premezcla y otra para agua de bebida.
Su espectro de acción comprende a bacterias Gram+ y Gram(Streptococcus spp. Haemophillus spp., Klebsiella spp., Clostridium spp., Ricketsias, Clamydias, Mycoplasmas, Protozoos, Theileria, Eperythozoom, Anaplasma), estando indicadas para el tratamiento de neumonía enzoótica porcina, listeriosis, leptospirosis y mal rojo (solo en su forma aguda).
Entre los efectos secundarios encontramos la inhibición del crecimiento de los huesos largos y alteraciones de la flora digestiva.
Kothari, U. & Krilov, L.R. Aminoglycosides. Pediatr Rev. 2012 Nov;33(11):531-2; discussion 533. doi: 10.1542/ pir.33-11-531.
Krause, K.M., Serio, A.W., Kane, T.R. & Connolly, L.E.A. Harb Perspect Med. 2016 jun 1;6(6): a027029. doi:10.1101/cshperspect. a027029.
Molina, J., Cordero, E., Palomino, J. & Pachón, J. Aminoglucósidos y polimixinas. Enfermedades Infecciosas y Microbiología Clínica Vol. 27. Núm. 3. Páginas 139-196 (marzo 2009)
Perez-Trallero, D.V. Tetraciclinas, sulfamidas y metronidazol. Enferm Infecc Microbiol Clin 2010; 28:122-30. 10.1016/j.eimc.2009.10.002
También pueden provocar inmunodepresión en lechones de 2-6 semanas y crecimiento de organismos no susceptibles, sobre todo Monilias.
El tiempo de espera en carne es de 5 días.
En la segunda parte de este artículo, abordaremos las clases de antibióticos que actúan sobre la subunidad ribosomal 50S.
Mella, S., Sepúlveda,
M., González, G., Bello, H., Domínguez, M-. Zemelman, R. & Ramírez C. Aminoglucósidos-aminociclitoles: Características estructurales y nuevos aspectos sobre su resistencia. Rev Chil Infect 2004; 21 (4): 330-338.
Serio, A.W., Keepers, T., Andrews, Logan, Krause & Kevin M. Aminoglycoside Revival: Review of a Historically Important Class of Antimicrobials Undergoing Rejuvenation. EcoSal Plus. 2018 nov;8(1). doi: 10.1128/ecosalplus. ESP-0002-2018.
Nº 4 | Abril 2022 Uso racional de antimicrobianos en porcino: Antimicrobianos que actúan inhibiendo la síntesis de proteínas – Parte I 58 ANTIMICROBIANOS
GENTAVET
Sulfato de gentamicina
200.000 UI/g
Letal frente a patógenos invasores de la mucosa intestinal


GENTAVET polvo para administración en agua de bebida Composición: Sulfato de gentamicina 200.000 UI. Indicaciones: Porcino (animales destetados). Tratamiento de infecciones digestivas causadas por Escherichia coli no invasiva y disenterías causadas por microorganismos sensibles a la gentamicina. Posología: Administrar 2.000 UI de sulfato de gentamicina/kg p.v. (equivalente a 100 mg de medicamento por cada 10 kg de p.v.) durante 3 días consecutivos. Tiempo de espera: 14 días. Reacciones adversas: Se puede presentar disbiosis intestinal. Interacciones: No administrar conjuntamente con otros aminoglucósidos ni antibióticos bacteriostáticos. Presentaciones: bolsas de 500 g y 1 kg. Nº reg: 3829 ESP. Para consultar Ficha técnica completa: www.cimavet.aemps.es

59 ONE HEALTH
Ibérica vet@fatroiberica.es www.fatroiberica.es Fatro SpA. Vía Emilia, 285 • 40064 Ozzano Emilia • Bolonia • ITALIA
La salud animal en manos del Veterinario Fatro
HAY OTRAS FORMAS DE VACUNAR, PERO NO SON IDAL

ÚNETE AL MOVIMIENTO IDAL


V EFECTO DE LA VACUNACIÓN INTRADÉRMICA SOBRE EL BIENESTAR DE LOS LECHONES
M MMejorar el Bienestar Animal en las granjas porcinas es una prioridad para un sector cada vez más concienciado con la necesidad de minimizar el estrés y el dolor asociado a determinadas operaciones que se llevan a cabo rutinariamente en las granjas como, por ejemplo, la vacunación.
En este artículo, se presentan los resultados de dos estudios en los que se evaluaron las respuestas conductuales de los lechones a la administración de vacunas, comparando las vías intramuscular con aguja (IM) e intradérmica sin aguja (ID) a través del uso de dispositivos IDAL®.
RESPUESTAS CONDUCTUA-
LES DE LECHONES DE 26
DÍAS A LA VACUNACIÓN:
COMPARACIÓN DE LA VÍA IM
Y LA ID
A. Nalovic1, L.Daluzeau2, L. Eon2, T. Pinier2, S. Chouet2 y D. Duivon2.
1Selas Epidalis.
2MSD Santé Animale. Artículo publicado en ESPHM 2021 Berna, Suiza.


OBJETIVOS OBJETIVOS
Las cuestiones relativas al Bienestar Animal son fundamentales para la sociedad actual. Por ello, la reducción del dolor en los procedimientos habituales en las granjas ha sido motivo de mayor atención en los últimos años.
El objetivo de este estudio fue evaluar la respuesta conductual de los lechones durante la administración de vacunas, comparando la inyección intramuscular con aguja (IM) frente a la inyección intradérmica sin aguja (ID).

BIENESTAR ANIMAL 61
Descarga el PDF
MATERIAL Y MÉTODOS MATERIAL Y MÉTODOS
En una granja comercial, 490 lechones de tres semanas de edad se dividieron en dos grupos comparables, administrándose todas las vacunas a la misma temperatura. A los 26 días de edad:
Un grupo recibió la vacuna intramuscular frente a Mycoplasma hyopneumoniae (grupo IM, n=247)
Un grupo recibió la vacuna intradérmica frente a Mycoplasma hyopneumoniae (grupo ID, n=243).
IMAGEN 1
Grabación por vídeo de las expresiones faciales de un lechón vacunado por vía IM. En primer plano se puede observar la cámara FarmCam IP2 (Luda.Farm, Krokslätts fabriker 30, SE43137 Mölndal, Suecia).


SUBESTUDIO DE “COMPORTAMIENTO
FRENTE AL DOLOR”
Se observaron cuatro comportamientos que sugieren estrés doloroso (VOCALIZACIÓN, PELEA, RIGIDEZ Y DEFECACIÓN) mediante la grabación durante la vacunación de cada uno de los lechones.
Un lechón que exprese 0, 1, 2, 3 o 4 de estos comportamientos recibe una puntuación de 0, 5, 15, 30 o 50, respectivamente.
Una puntuación de 0 o 5 indica ausencia de dolor o dolor leve, mientras que 15, 30 y 50 se consideran puntuaciones indicativas de dolor moderado a fuerte
IMAGEN 2
Identificación con grabación de video de las expresiones faciales de un lechón vacunado por vía ID. Obsérvese el inyector IDAL 3G a la izquierda y la FarmCam IP2 a la derecha.
SUBESTUDIO DE “MUECAS DE DOLOR”
En cada grupo se seleccionan aleatoriamente dos subgrupos de 100 lechones antes del destete. Estos grupos son comparables en peso, proporción de sexos y origen materno.
En estos 200 animales, el momento de la vacunación se grabó para registrar las expresiones faciales de los lechones en el momento de la inyección (Imágenes 1 y 2).
Los vídeos fueron revisados por una persona capacitada y las “muecas de dolordolor” se puntuaron según Viscardi (2017). A cada lechón se le asignó una puntuación de 0 a 5.
El 0 y el 1 evocan ausencia de dolor o dolor leve, mientras que 3, 4 y 5 evocan un dolor de moderado a fuerte.
En ambos subestudios, se calcularon y comparan los siguientes parámetros para cada grupo:
Media de puntuación por subgrupo (prueba de Kruskall-Wallis).
Distribución de niveles de dolor (Chi cuadrado de Pearson).
Nº 4 | Abril 2022 VACUNACIÓN Efecto de la vacunación intradérmica sobre el bienestar de los lechones 62
Las puntuaciones medias para los comportamientos indicativos de dolor fueron de 5,6 y 1,5 para los grupos IM e ID, respectivamente (p<0,0001) (Figura 1).
El porcentaje de cerdos que expresaron signos de dolor moderado a fuerte fue de 23,1% para el grupo IM y de y 2,9% para el grupo ID. Las puntuaciones medias para las muecas de dolor fueron de 1,3 para el subgrupo IM y de 0,45 para el grupo ID (p=0,023).
El porcentaje de animales que expresaron signos de dolor moderado a fuerte fue del 25% y 2,3%, respectivamente (p=0,0059) (Figura 2)

DISCUSIÓN Y CONCLUSIONES
RESULTADOS DISCUSIÓN Y CONCLUSIONES
La inyección por vía ID parece ser menos dolorosa que la vía IM con ambos métodos de valoración. Ahora bien, esto no tiene en cuenta otros factores como los adyuvantes de la vacuna y la cantidad de antígeno, algo que debería considerarse en la investigación futura.
DE LAS MUECAS FACIALES, ARROJARON RESULTADOS MUY PARECIDOS
Sin embargo, ambos métodos se complementan entre ellos, ya que cuando un lechón está vocalizando e intentando escapar, puede que no haga muecas, y viceversa.
Los dos métodos de evaluación del dolor parecen ser bastante fáciles de poner en práctica en condiciones de campo.
76,9% Sin dolor o dolor leve (puntuaciones 0 + 5)
Dolor de moderado a fuerte (puntuaciones 15 + 30 )
Subestudio de comportamientos frente al dolor: distribución gráfica de los niveles de dolor para las vías IM e ID (Prueba de Chi cuadrado de Pearson; p<0,0001).
Sin dolor o dolor leve (puntuaciones 0 + 1)
Dolor de moderado a fuerte (puntuaciones 3 + 4 + 5 )
Subestudio de muecas de dolor: distribución gráfica de los niveles de dolor para las vías IM e ID. (Prueba de Chi cuadrado de Pearson; p= 0,059).
RESULTADOS
1
TANTO LA VALORACIÓN DE LOS COMPORTAMIENTOS DE DOLOR, COMO LA VALORACIÓN
FIGURA
FIGURA 2
Grupo ID (N=243) 97,1% 2,9% 23,1% 0 10 20 30 40 50 60 70 80 90 100
Grupo IM (N=247)
Porcentaje de lechones (%) Grupo ID (N=98) 97,7% 2,3% 25% 0 10 20 30 40 50 60 70 80 90 100
75,0%
Grupo IM (N=99)
Porcentaje de lechones (%) BIENESTAR ANIMAL 63
EVALUACIÓN CONDUCTUAL E INDICADORES DE ESTRÉS EN LECHONES DE TRES SEMANAS DE EDAD
TRAS LA VACUNACIÓN
INTRADÉRMICA O INTRAMUSCULAR
OBJETIVOS OBJETIVOS
La reducción del dolor durante los cuidados habituales en la granja es de crucial importancia en los animales productores de alimentos.
El objetivo de este estudio es evaluar las respuestas conductuales y fisiológicas de los lechones durante la administración de vacunas comparando la inyección intramuscular con aguja (IM) y la inyección intradérmica sin aguja (ID).
Existen pruebas fiables de la eficacia de la vacunación ID y se han publicado varios estudios sobre la respuesta sistémica y la respuesta local (Martelli et al., 2007 y 2014; Sno et al., 2016), si bien el efecto de la vía de administración de la vacuna y sus repercusiones en el Bienestar Animal son aspectos menos conocidos.
MATERIAL Y MÉTODOS MATERIAL Y MÉTODOS
Se seleccionaron lechones de 2 semanas en una granja comercial, asignándose aleatoriamente a dos grupos de estudio. A las 3 semanas de edad los lechones fueron vacunados simultáneamente frente a PCV2 y Mycoplasma hyopneumoniae, bien utilizando una jeringa con aguja (IM, n=53) o un dispositivo sin aguja (ID, n=53) de acuerdo con las instrucciones del fabricante.
Se evaluó la conducta de 34 lechones por grupo mediante grabación de vídeo con objeto de evaluar sus reacciones (intentos de huida) y vocalizaciones (cantidad e intensidad)
Se analizó el nivel de cortisol en muestras de sangre extraídas de 18 lechones en cada grupo, chequeando 30 minutos y 2 horas después de la vacunación (estos animales no se incluyeron en la evaluación de conducta).
Minervini S.1, Scollo A.2,3, Bortoletto G.1, Romano G.2, Galli M.C.3, Gottardo F.3.
1MSD Animal Health.
2Swivet Research snc.
3Department of Animal Medicine, Production and Health, University of Padova.
Artículo publicado en ESPHM 2021 Berna, Suiza.
RESULTADOS RESULTADOS
No se observan reacciones de huida en el 90% de los lechones del grupo ID en el momento de la vacunación, mientras que en el grupo IM solo el 55% de los animales no reaccionó (p<0,001) (Figura 3). Además, el 18% de los cerdos IM siguió expresando signos de nerviosismo tras la vacunación, mientras que no se observaron estos signos en los lechones ID (p<0,01).
Tras la administración de la vacuna, el 55% de los lechones ID no vocalizaron y solo el 13% lo hizo de forma repetida, frente al 25 y 50% respectivamente de los lechones IM, (p< 0,001) (Figura 4)
Un análisis detallado de las vocalizaciones muestra además una duración más prolongada (IM = 558 ms; ID = 352 ms, p=0,010) y un pico máximo más intenso (IM = 99,8 dB; ID = 90,7 dB, p<0,001) para las vocalizaciones del grupo IM en comparación con el grupo ID.
No se observaron diferencias en las concentraciones de cortisol de las muestras extraídas a los 30 minutos. Los datos de las muestras extraídas a las 2 horas siguen pendientes.
Nº 4 | Abril 2022 VACUNACIÓN Efecto de la vacunación intradérmica sobre el bienestar de los lechones 64
BIBLIOGRAFÍA
Viscardi, A.V.; et al. Development of a Piglet Grimace Scale to Evaluate Piglet Pain Using Facial Expressions Following Castration and Tail Docking: A Pilot Study.
Front. Vet. Sci. 2017, 4, 51.
Martelli, P. et al, 2007. Protection and immune response in pigs intradermally vaccinated against Porcine Reproductive and Respiratory Syndrome (PRRS) and subsequently exposed to a heterologous European (Italian cluster) field strain. Vaccine 25, 3400–3408. https:// org/10.1016/j.vaccine.2006.12.050.

DISCUSIÓN Y CONCLUSIONESDISCUSIÓN Y CONCLUSIONES
La medición de vocalizaciones y de respuestas de huida-evitación se consideran métodos fiables para evaluar la respuesta del cerdo ante el dolor y diversos factores de estrés (Gigliuto et al., 2014; Schön et al., 2004).
El mayor número de vocalizaciones con un pico de intensidad más largo y potente en los lechones vacunados por vía IM puede sugerir estados de ansiedad y dolor.
Los resultados confirman las conclusiones de la investigación de Goller y colaboradores (2016):
LOS LECHONES VACUNADOS POR
VÍA ID SE MUESTRAN MÁS ACTIVOS Y MAMAN MÁS QUE LOS LECHONES VACUNADOS POR VÍA IM
Este estudio muestra una reducción de las respuestas de estrés estadísticamente significativa. La vacunación por vía intradérmica reduce los indicadores conductuales negativos del bienestar animal durante la administración de la vacuna e inmediatamente después de ella.
Gigliuto, C., et al. Pain assessment in animal models: do we need further studies? J. Pain Res. 7, 227–236.
Göller, M., et al, 2016. Intradermal vaccine application: effects on suckling behaviour. In: Proceedings of the 24th International Pig Veterinary Society Congress. Dublin. pp. 625 7-10 June 2016.
Schön, P.C., et al, 2004. Automated recording of stress vocalisations as a tool to document impaired welfare in pigs. Anim. Welf. 13, 105–110.
Sno, M., et al, 2016. Efficacy and safety of a new intradermal PCV2 vaccine in pigs. Trials Vaccinol. 5, 24–31. https://org/10.1016/j.trivac.2016.01.002.
Martelli, P., et al. Systemic and local immune response in pigs intradermally and intramuscularly injected with inactivated Mycoplasma hyopneumoniae vaccines (2014) Veterinary Microbiology, 168 (2-4), pp. 357-364.
Reacciones
FIGURA 4 Vocalizaciones en lechones vacunados por
Reacción de huida Porcentaje de lechones (%) 0 10 20 30 Se queda quieto Se mueve durante la vacunación y luego se queda quieto Sigue inquieto 40 50 60 70 80 90 100 55 90 P<0,001 P<0,07 P<0,01 27 10 18 0 IM ID Vocalizaciones Porcentaje de lechones (%) 0 10 20 30 Sin vocalizaciones No más de un chillido Más de un chillido 40 50 60 25 55 P<0,008 P<0,62 25 33 50 13 IM ID
FIGURA 3
de huida en lechones vacunados por vía IM o ID.
vía IM o ID.
65 BIENESTAR ANIMAL
NUEVAS HERRAMIENTAS DE DIAGNÓSTICO LABORATORIAL
D E
EEl diagnóstico de laboratorio de enfermedades infecciosas tiene como objetivo identificar el agente o los agentes etiológicos causantes de un proceso clínico. Esta información permite instaurar un tratamiento que sea eficaz, así como aplicar medidas de prevención para evitar nuevos brotes.
La presencia de un agente infeccioso puede determinarse de forma directa detectando el agente en la muestra clínica tomada del animal, por ejemplo, mediante aislamiento microbiológico o detección de su genoma mediante técnicas como la reacción en cadena de la polimerasa (PCR). Sin embargo, también es posible hacerlo de una forma indirecta, utilizando las técnicas serológicas que detectan los anticuerpos generados por el animal frente al patógeno.
Desde que en siglo XVII el holandés Anton van Leeuwenhoek observara microorganismos a través de un microscopio, han sido varias las técnicas empleadas para conocer los agentes causantes de enfermedades infecciosas. Si bien todavía se siguen utilizando para el diagnóstico de muchas enfermedades, son varias las técnicas que se podrían categorizar como “clásicas”: las tinciones al microscopio, el cultivo microbiológico y posterior identificación por pruebas bioquímicas, la histopatología, la serología o las técnicas moleculares, como la PCR convencional.

En este artículo se repasan las novedades recientes a nivel de diagnóstico de laboratorio. Estas nuevas tecnologías han aportado grandes ventajas tanto en rapidez como en sensibilidad frente a las clásicas.

 Sofía Lázaro Gaspar y Gema Chacón Pérez EXOPOL SL
Sofía Lázaro Gaspar y Gema Chacón Pérez EXOPOL SL
DIAGNÓSTICO Nº 4 | Abril 2022 Nuevas herramientas de diagnóstico laboratorial 66
Descarga el PDF
NUEVAS TÉCNICAS Y TECNOLOGÍAS
Y SUSCEPTIBILIDAD A ANTIMICROBIANOS
MICROBIOLÓGICO Y SUSCEPTIBILIDAD A ANTIMICROBIANOS
TÉCNICA MALDI-TOF
En el laboratorio de microbiología, el uso de la tecnología de espectrometría de masas
MALDI-TOF (de sus siglas en inglés Matrix-Assisted Laser Desorption/Ionization Timeof-Flight) ha ido reemplazando rápidamente a las técnicas de identificación bioquímicas. Esta tecnología es capaz de identificar microorganismos a través de su conjunto de proteínas (poseen una huella molecular específica de especie).


La colonia aislada se introduce en el equipo donde se rompe por acción de un láser y todas sus proteínas se detectan generando un espectro característico. Comparando este espectro con una base de datos con miles de patógenos y sus respectivos espectros somos capaces de conocer qué microorganismo es en cuestión de minutos (Figura 1)
LA TÉCNICA MALDI-TOF APORTA RAPIDEZ, OBJETIVIDAD Y
Por ejemplo, en el caso del género Brachyspira, aquellas especies de hemólisis débil ahora se identifican fácilmente. Otro ejemplo lo encontramos en los Enterococcus digestivos o los Staphylococcus coagulasa negativos, que actualmente se están identificando a nivel de especie, lo que permite acumular datos y detectar patógenos emergentes.
Esquema de la identificación bacteriana por tecnología MALDI-TOF.
D
CULTIVO
CULTIVO
MICROBIOLÓGICO
IDENTIFICACIÓN
PATÓGENOS Intens. [arb] 1.500 2.000 4.000 Base de datos con microorganismos y sus espectros IDENTIFICACIÓN 6.000 8.000 10.000 12.000 m/z 14.000 16.000 18.000 20.000m/z 1.000 500 0
PRECISIÓN EN LA
DE
FIGURA 1
INVESTIGACIÓN 67
Cuando un agente bacteriano es identificado y considerado implicado en el proceso clínico, el siguiente paso es realizar pruebas de sensibilidad antibiótica para instaurar un tratamiento.
La aparición de resistencias es un problema actual en la salud pública. En España está en marcha el plan nacional frente a la resistencia a antibióticos para controlar su uso y evitar la expansión de dichas resistencias tanto en el ámbito veterinario como humano.
La técnica más extendida para este propósito es el método disco-placa o Kirby-Bauer, donde una única concentración de antibiótico se enfrenta a la bacteria para observar la posible inhibición de su crecimiento.
PCR A TIEMPO REAL
En cuanto a las técnicas moleculares de diagnóstico, cabe destacar la PCR a tiempo real o PCR cuantitativa que, si bien puede no considerarse novedad, ya que se emplea hace más de una década, actualmente sigue siendo la técnica de referencia y más extendida para el diagnóstico de muchas enfermedades infecciosas.
Las diferentes especies patógenas, así como serotipos, toxinas o factores de virulencia con papeles clave en un proceso clínico están codificados por secuencias genómicas únicas.
Sin embargo, la determinación de la concentración mínima inhibitoria (concentración mínima que inhibe el crecimiento bacteriano) proporciona mayor exactitud al enfrentar a la bacteria a diferentes concentraciones de antibiótico, permitiendo seleccionar aquel antibiótico con mayor probabilidad de éxito terapéutico (Figura 2).
FIGURA 2
DIAGNÓSTICO Nº 4 | Abril 2022 Nuevas herramientas de diagnóstico laboratorial 68
Conocer la concentración de cada patógeno es importante en enfermedades multifactoriales, como el complejo respiratorio porcino o las diarreas neonatales, ya que nos permite evaluar la implicación de cada agente en el cuadro clínico.
MUESTRA 1. Positiva*** valor Cq: 25
Ciclos 40
MUESTRA 2. Positiva* valor Cq: 31 Negativa Cq Cq
Umbral
de detección
Señal
PRUEBAS DE SENSIBILIDAD ANTIBIÓTICA
Esquema de placa de CMI en medio líquido.
FIGURA 3
32 μg/ml 16 8 4 2 1 0,5 0,25 Distintas concentraciones
Esquema del resultado de una PCR a tiempo real de diferentes muestras.
Distintos antibióticos
A diferencia de la PCR convencional, la PCR a tiempo real es una técnica con mayor sensibilidad y especificidad en la que el fragmento de genoma amplificado se detecta tras cada ciclo de amplificación, lo que posibilita una cuantificación del agente en la muestra inicial (Figura 3).
TÉCNICAS DE BIOLOGÍA MOLECULAR TÉCNICAS DE BIOLOGÍA MOLECULAR
SECUENCIACIÓN
SECUENCIACIÓN DE SANGER TÉCNICA MLST
En muchos casos, saber qué microorganismo está presente no es suficiente para tomar las medidas adecuadas de prevención. En este sentido, la secuenciación de ADN , que consiste en la determinación de los nucleótidos de un gen o región genómica, puede ser de gran utilidad.

La técnica empleada en estos casos es la secuenciación de Sanger y, una vez obtenida la secuencia, su análisis y comparación con otras secuencias nos permite obtener información diversa.
Por ejemplo, en el caso del
Si volvemos a encontrar una cepa con una alta similitud a las cepas previamente detectadas, la solución implicará mejoras a nivel de bioseguridad interna.
Por otro lado, se puede determinar si se está detectando la cepa vacunal en los casos en los que la vacunación se realiza con cepas vivas atenuadas, lo que descartaría fallos de bioseguridad y la implicación de ese agente en la clínica de los animales.
La secuenciación también puede aplicarse para diferenciar entre cepas de bacterias. La metodología MLST (de las siglas en inglés, Multiple Locus Sequence Typing) consiste en secuenciar 7 genes de la bacteria.

La secuencia de cada uno de ellos es asignada a un número de alelo en función de los nucleótidos que contiene cada gen. A su vez, la combinación de los números de alelos de los 7 genes da una secuencia tipo o ST (de sus siglas en inglés, Sequence Type) (Figura 4) . Por lo tanto, dos cepas se considerarán diferentes si pertenecen a dos ST distintos. En porcino, cabe destacar su uso en el brotes de disentería porcina para esclarecer el origen epidemiológico tras una erradicación previa.
Conocer la secuencia de la cepa circulante o su genotipo puede dar información acerca del origen de un brote:
Podremos establecer si ha existido un problema de bioseguridad externa, dónde se ha podido producir una entrada lateral y la secuencia obtenida para esa cepa que no habíamos encontrado antes en esa explotación.
Caracterización MLST
La secuencia de cada gen se compara en la base de datos ST (secuencia-tipo)
Base de datos con todos los tipos de secuencias de alelos y sus ST 2
est
gdh
glp
pgm
adh 11
5
20
9
12
alp
3 thi ST 70
Gen Alelo Bhyadh 2
11 Bhyest 5
20
9 Bhypgm 12 Bhythi 3 ST 70 INVESTIGACIÓN 69
Bhyalp
Bhygdh
Bhyglp
ANÁLISIS MLVA
Otra técnica, que en porcino se ha descrito para hyopneumoniae
Locus VNTR Analysis (MLVA), donde VNTR viene de Number Tandem Repeats. Las bacterias tienen en su genoma diferentes puntos (locus) que contienen grupos de nucleótidos repetidos un número determinado de veces (repeticiones variables en tándem).


Cepas aisladas en distintos brotes con el mismo número de repeticiones en tándem en cada uno de estos locus pueden considerarse una misma cepa, y al contrario, si se encuentran variaciones, se puede establecer que son diferentes.
Al secuenciar estos loci (plural de locus) de varias cepas podemos saber cuántas repeticiones hay de cada grupo de nucleótidos y determinar si son la misma o diferentes (Figura 5).
FIGURA 5
Esquema de un locusde un genoma bacteriano de dos cepas diferentes (A). Resultado de una caracterización de M.hyopneumoniaepor MLVA basada en 4 loci(B), los números representan el número de repeticiones en cada uno de ellos para las 2 cepas.
Cepa A 7 repeticiones
G T C A C A A G A A G A A G A A G A A G A A G A A G C A T T G A A G T C A C A A G A A G A A G A A G C A T T A B Locus Cepa A Cepa B Mhyh1 10 8 Mhyp97 9 9 Mhyp146 25 20 Mhyh5 14 12 DIFERENTE CEPA DIAGNÓSTICO Nº 4 | Abril 2022 Nuevas herramientas de diagnóstico laboratorial 70
Cepa B 3 repeticiones
PERSPECTIVAS DE FUTURO
Las técnicas moleculares en las que se analizan ácidos nucleicos presentan un futuro prometedor en el diagnóstico de enfermedades infecciosas en veterinaria.

En la última década se han puesto a punto nuevas formas de secuenciar el ADN (diferentes a la técnica de Sanger), denominadas técnicas de secuenciación de nueva generación y de tercera generación. También se conocen como técnicas de secuenciación masiva, ya que se generan una gran cantidad de secuencias.
LAS NUEVAS
DE SECUENCIACIÓN
Aunque presenta ventajas frente a Sanger y proporciona gran cantidad de información, el coste de realizarla es todavía muy elevado y el análisis e interpretación es de gran complejidad.
Por el momento, toda esta cantidad de nuevas secuencias aportadas a las bases de datos es clave, pues sirve como referencia para poder desarrollar y mejorar las técnicas mencionadas anteriormente (PCR a tiempo real y secuenciación Sanger) ya que para su aplicación se requiere el conocimiento previo del genoma de los agentes a estudiar.
Por otro lado, hay técnicas en proceso de desarrollo que permitirían un diagnóstico in situ , a pie de campo. Una de ellas es la PCR isoterma, una variante de la PCR que no requiere de equipamiento para su realización al realizarse a una temperatura constante.
GENOMAS COMPLETOS DE VIRUS Y
BACTERIAS, ENTRE OTROS
Se han descrito diferentes metodologías donde se acopla esta reacción de PCR a un sistema de detección a la vista como una tira reactiva o la observación de un cambio de color en el tubo cuando la reacción tiene un resultado positivo.
Otra metodología que se puede aplicar en el diagnóstico in situ es la de CRISPR . Se trata de un complejo de proteínas capaces de reconocer y editar regiones específicas de un genoma. Sin embargo, existe una versión de CRISPR que identifica las regiones genómicas de interés y, cuando esto ocurre, el complejo se activa, provocando una rotura de una molécula fluorescente, revelando un positivo y la presencia del patógeno de estudio en la muestra (Figura 6)
CON
TÉCNICAS
SE PUEDE SECUENCIAR TODO EL MATERIAL GENÉTICO DE UN ECOSISTEMA (POR EJEMPLO, EL MICROBIOMA INTESTINAL) O
INVESTIGACIÓN 71
Resultado positivo
Sistema CRISPR
Ambas tecnologías han sido descritas para la detección de PRRSV en el campo y presentan una buena sensibilidad y especificidad, con facilidad de uso y sin necesidad de equipamiento.
Si bien son muy prometedoras en cuanto a costes y uso in situ, todavía queda espacio para mejoras como el empleo de muestra clínica directa (sin un proceso de extracción de ácidos nucleicos previo) o la adaptación de reactivos para que sean estables y funcionales a temperatura ambiente.
Molécula señal no activa
Molécula señal activa
Genoma del patógeno
Existe una gran variedad de técnicas para realizar el diagnóstico de una enfermedad infecciosa y cada vez se desarrollan nuevas tecnologías. Sin embargo, es importante conocerlas y elegir la adecuada para responder a las preguntas que se plantea el veterinario.
La toma y la correcta elección de la muestra clínica son puntos cruciales a la hora de obtener un resultado concluyente. Asimismo, la combinación de varias metodologías ayudará a aumentar la sensibilidad diagnóstica y establecer el agente etiológico de forma precisa.
BIBLIOGRAFÍA
Chang Y, Deng Y, Li T, Wang J, Wang T, Tan F, Li X, Tian K. Visual detection of porcine reproductive and respiratory syndrome virus using CRISPR-Cas13a. Transbound Emerg Dis. 2020 Mar;67(2):564-571. doi: 10.1111/tbed.13368. Epub 2019 Sep 30. PMID: 31541593. Finlay BJ, Esteban GF. Exploring Leeuwenhoek's legacy: the abundance and diversity of protozoa. Int Microbiol. 2001 Sep;4(3):125-33. doi: 10.1007/s10123001-0027-y. PMID: 11820430.
La T, Phillips ND, Harland BL, Wanchanthuek P, Bellgard MI, Hampson DJ. Multilocus sequence typing as a tool for studying the molecular epidemiology and population structure of Brachyspira hyodysenteriae. Vet Microbiol. 2009 Sep 18;138(3-4):330-8. doi: 10.1016/j.vetmic.2009.03.025. Epub 2009 Mar 25. PMID:
19369014.
Park JY, Park S, Park YR, Kang DY, Kim EM, Jeon HS, Kim JJ, Kim WI, Lee KT, Kim SH, Lee KK, Park CK. Reverse-transcription loop-mediated isothermal amplification (RT-LAMP) assay for the visual detection of European and North American porcine reproductive and respiratory syndrome viruses. J Virol Methods. 2016 Nov;237:10-13. doi: 10.1016/j. jviromet.2016.08.008. Epub 2016 Aug 16. PMID:
27542532.
Prohaska S, Pflüger V, Ziegler D, Scherrer S, Frei D, Lehmann A, Wittenbrink MM, Huber H. MALDI-TOF MS for identification of porcine Brachyspira species. Lett Appl Microbiol. 2014 Mar;58(3):2928. doi: 10.1111/lam.12189. Epub 2013 Nov 18. PMID: 24236892.
Van Borm S, Belák S, Freimanis G, Fusaro A, Granberg F, Höper D, King DP, Monne I, Orton
R, Rosseel T. Next-generation sequencing in veterinary medicine: how can the massive amount of information arising from high-throughput technologies improve diagnosis, control, and management of infectious diseases? Methods Mol Biol. 2015;1247:415-36. doi: 10.1007/9781-4939-2004-4_30. PMID: 25399113; PMCID: PMC7123048. Vranckx K, Maes D, Calus D, Villarreal I, Pasmans F, Haesebrouck F. Multiple-locus variable-number tandem-repeat analysis is
a suitable tool for differentiation of Mycoplasma hyopneumoniae strains without cultivation. J Clin Microbiol. 2011 May;49(5):2020-3. doi: 10.1128/JCM.00125-11. Epub 2011 Mar 9. PMID: 21389157; PMCID: PMC3122671.
FIGURA 6 Esquema de funcionamiento del sistema CRISPR para diagnóstico.
DIAGNÓSTICO Nº 4 | Abril 2022 72 Nuevas herramientas de diagnóstico laboratorial
VACUNA INYECTABLE

COLIDEX-C ®
LA INMUNIDAD ES EL MEJOR SUPERPODER
¿Estás preparado para la retirada del óxido de zinc?
Protege a tus lechones frente a la colibacilosis posdestete hasta el inicio del cebo con la vacuna inyectable COLIDEX-C®

COLIDEX-C ® emulsión inyectable
Composición por dosis (2 ml): E. coli (adhesina F4ac), cepa P6 ≥ 1 PR; E. coli (adhesina F5), cepa P1 ≥ 1 PR; E. coli (adhesina F6) cepa P2 y P4 ≥ 1 PR; E. coli (adhesina F5 + F41), cepa P10 ≥ 1 PR; E. coli (adhesina F18ab), cepa P5 ≥ 1 PR; E. coli (adhesina F18ac), cepa P9 ≥ 1 PR; Toxoide β de C. perfringens tipo C ≥ 10 UI. Indicaciones y especies de destino: Porcino: cerdas y lechones. Para la inmunización activa de cerdas primíparas y multíparas y pasiva de los lechones para prevenir la colibacilosis causada por las cepas de E. coli enterotoxigénicas y enteropatogénicas que expresan las adhesinas F4ac, F5, F6, F18ac y F41, frente a la enfermedad de los edemas causada por la cepa de E. coli que expresa la adhesina F18ab y frente a la enteritis necrótica causada por C. perfringens tipo C. Para la inmunización activa de los lechones frente a la diarrea post-destete. Posología y via de administración: Vía intramuscular profunda en los músculos del cuello. Dosis: Cerdas primíparas y multíparas: 2 ml. Lechones: Primera dosis: 0,5 ml. Segunda dosis: 1 ml. Pauta de vacunación: Cerdas gestantes: Administrar una primera dosis 6 a 7 semanas antes del parto, y una segunda dosis 4 semanas antes del mismo. Revacunar en las gestaciones siguientes con una dosis única, 4 semanas antes del parto. Lechones: Administrar, a los diez días de edad, una primera dosis de 0,5 ml. En el momento del destete inyectar una segunda dosis de 1 ml. Contraindicaciones: No usar en caso de hipersensibilidad a las sustancias activas, a los adyuvantes o a algún exicipiente. Tiempo de espera: Cero días Titular: CZ Veterinaria, S.A. Reg. Nº: 3450 ESP
info@vetia.es (+34) 910 901 526 www.vetia.es A COMPANY OF ZENDAL GROUP VETIA ANIMAL HEALTH, SAU. C/ Teide, nº 4. 28703 San Sebastián de los Reyes - Madrid
P
Z
AUTASENCILLAYEFICA
MÉTODO DE MUESTREO SENCILLO Y SEGURO PARA MONITORIZAR
EL VIRUS DE LA PESTE

PORCINA AFRICANA
P L
Aleksandra Kosowska, Jose A. Barasona, Sandra
Barroso‑Arévalo, Belén Rivera, Lucas Domínguez & Jose M.
Sánchez‑Vizcaíno
Centro de Vigilancia Sanitaria
VISAVET y Departamento de Sanidad Animal de la Facultad de Veterinaria, Universidad Complutense de Madrid.
LLa Peste Porcina Africana (PPA) representa actualmente el mayor desafío sanitario para el sector porcino a nivel global. Solo la detección temprana del virus de la PPA (VPPA) y las medidas de bioseguridad adecuadas son eficaces para frenar su expansión. Uno de los riesgos más reconocidos en cuanto a la introducción y difusión del VPPA en un país son los alimentos contaminados, animales infectados (domésticos o silvestres) y los vehículos de transporte de ganado contaminados.
Para mejorar la vigilancia de la PPA, hemos evaluado un nuevo método de muestreo para la detección e inactivación del VPPA mediante el uso de las esponjas (3 M Esponja seca; 3 M, Madrid, España) hidratadas con un nuevo líquido inactivador del virus compuesto por una mezcla de alcoholes (patente n° P2115ES00).
DIAGNÓSTICO Nº 4 | Abril 2022 Método de muestreo sencillo y seguro para monitorizar el virus de la Peste Porcina Africana 74
Descarga el PDF
LA LUCHA GLOBAL CONTRA LA PPA
La PPA es una de las enfermedades porcinas más relevantes por su importancia sanitaria y sus consecuencias socioeconómicas para un número considerable de países1
En las últimas décadas, la PPA ha demostrado tener una notable capacidad de propagación transfronteriza y transcontinental, con un número creciente de brotes. Actualmente, la enfermedad está presente en cinco continentes y más de 50 países2
Los países afectados luchan por controlar y minimizar las pérdidas, mientras que los países que aún están libres de PPA se enfrentan a un mayor riesgo de introducción del patógeno³.
La PPA está provocada por la infección con un complejo virus de ADN de doble cadena con envoltura, único miembro de la familia Asfaviridae 4. A falta de una vacuna comercial o de un tratamiento eficaz, la principal herramienta de control de la enfermedad se basa en la implementación de las medidas preventivas de bioseguridad1
Con el actual proceso de globalización, la introducción del virus en un país se ve facilitada principalmente por los animales infectados y sus productos, que pueden ser transportados a grandes distancias desde países infectados5,6
Otras fuentes de infección están relacionadas con fómites, como los vehículos de transporte de ganado, los piensos o la ropa y el calzado de los trabajadores de la granja7
Los vehículos que transportan cerdos a las granjas, mercados o mataderos, así como los que entregan piensos o que recogen cadáveres representan un gran riesgo de transmisión de la enfermedad8.
El papel de los vehículos contaminados se ha evaluado en varios estudios en los que se ha concluido que los camiones que regresan al país de origen, representan el mayor riesgo de introducción de la PPA en la Unión Europea en comparación con otras rutas asociadas al transporte8,9
Dado que el nivel de desinfección de los vehículos es un parámetro importante para la evaluación del riesgo de introducción de la PPA, sería aconsejable incluir el muestreo ambiental en los puntos de desinfección para prevenir la posible transmisión del virus entre explotaciones porcinas⁶.
P
INVESTIGACIÓN 75
En la actualidad, la prevención y control de la PPA se basan, principalmente, en el diagnóstico precoz de la enfermedad mediante la detección temprana en el campo y el diagnóstico eficiente en el laboratorio10,11
En este sentido, un buen programa de vigilancia, la disponibilidad de instalaciones, recursos y la preparación de los servicios veterinarios son factores determinantes para controlar la enfermedad. Las muestras potencialmente contaminadas con el VPPA deben manipularse en los laboratorios de un alto nivel de biocontención (BSL-3). Sin embargo, un virus inactivado podría analizarse en laboratorios básicos (BSL-2).
Nuevos casos de la PPA en República Dominicana revelaron el problema de seguridad de envío de las muestras potencialmente contaminadas con el VPPA.
APOSTANDO POR LA DETECCIÓN PRECOZ MUESTREO BASADO EN ESPONJAS HIDRATADAS CON LÍQUIDO INACTIVADOR
En este estudio se evaluó la eficacia de un nuevo método de muestreo basado en esponjas hidratadas* con un nuevo líquido inactivador de virus para la detección de ácidos nucleicos de patógenos mediante PCR cuantitativa (qPCR).
Este método de muestreo seguro y sencillo podría ser útil para el control de los vehículos de transporte de ganado y la vigilancia eficaz de la PPA en muestras de animales o ambiente.
Con el fin de adoptar medidas eficaces para la rápida identificación y posterior control de la PPA, los objetivos específicos de este trabajo fueron:
Evaluar la capacidad de la detección del VPPA en las muestras ambientales, incluyendo la piel de los animales, por las esponjas hidratadas con el líquido inactivador.
Validar las propiedades inactivadoras del virus del líquido tensioactivo en un experimento invivo.
Sin embargo, enviar una muestra inactivada que permite poder ser efectiva para el diagnóstico virológico por PCR es una solución segura.
Por lo tanto, contar con un nuevo método que garantice la inactivación completa del virus, pero que también permita la conservación del material genético viral, sería de gran interés para facilitar y acelerar el diagnóstico, permitiendo el envío seguro de las muestras potencialmente contaminadas con el VPPA y realización de los controles en los puntos críticos, por ejemplo, en la desinfección de vehículos y el transporte de animales.
Se realizaron dos tipos de muestreos independientes para evaluar la capacidad de detección y preservación del material genético del VPPA. Los resultados de las esponjas hidratadas con el líquido inactivador han sido comparados con los resultados de muestreo realizado con un hisopo de algodón convencional.
DIAGNÓSTICO Nº 4 | Abril 2022 Método de muestreo sencillo y seguro para monitorizar el virus de la Peste Porcina Africana 76
* 3 M Esponja seca; 3 M, Madrid, España
1 2
ENSAYO 1
ENSAYO 1
DETERMINACIÓN DE LA EFICACIA PARA LA DETECCIÓN DEL GENOMA DEL VPPA
DETERMINACIÓN DE LA EFICACIA PARA LA DETECCIÓN DEL GENOMA DEL VPPA
Para evaluar la eficacia de las esponjas a la hora de preservar el genoma del VPPA y permitir la detección viral , se realizó un muestreo ambiental en un entorno contaminado por el virus y de piel de los animales.
Para realizar el estudio, se infectaron cinco hembras de jabalí (Sus scrofa) con el aislado del VPPA Armenia07 (Arm07) mediante inoculación intramuscular con 10 dosis de hemadsorción al 50% (HAD50).
Durante el periodo experimental, las instalaciones fueron desinfectadas tres veces por semana con un desinfectante de amplio espectro y se tomaron muestras de varias superficies utilizando las esponjas hidratadas con el líquido inactivador e hisopos convencionales para comparar la sensibilidad de ambos métodos.
DISEÑO EXPERIMENTAL
MATERIAL DE MUESTREO
Las esponjas de celulosa libres de biocidas fueron hidratadas con un líquido surfactante isotónico compuesto por solución alcohólica registrada con la patente española n° P2115ES00.
Los alcoholes se utilizan habitualmente con fines de desinfección debido a su amplia actividad contra bacterias, virus y hongos12. Son compuestos con capacidad para disolver las membranas lipídicas y desnaturalizar las proteínas, de modo que el VPPA, al tener envoltura, es vulnerable a ellos13.

INVESTIGACIÓN 77
MUESTREO AMBIENTAL
Se seleccionaron seis lugares en contacto directo con los animales (bebederos, comederos y suelo) y dos lugares sin contacto (instalaciones: paredes, puertas y barras metálicas). Además, se incluyeron muestras de la piel de cuatro animales recogidas al final del estudio.

Se emplearon dos esponjas para cada punto de muestreo y una esponja por animal frotando suavemente sobre las regiones de la escápula y el flanco izquierdos.
Los mismos puntos, a excepción de las pieles de los animales, fueron muestreados previamente con hisopos de algodón hidratados con 1 ml de solución salina tamponada con fosfato (PBS) 1X.
Todas las muestras se procesaron inmediatamente después de su recogida y se almacenaron a - 80°C hasta su posterior utilización.
En el laboratorio, se extrajeron 1,5 ml de líquido de cada esponja, mientras que los hisopos se sumergieron directamente en 800 μl de PBS 1X. Seguidamente, se procedió a la extracción y cuantificación del ADN viral mediante qPCR, confirmándose la presencia del genoma del VPPA en las muestras ambientales positivas mediante ambientales14
RESULTADOS
HALLAZGOS CLÍNICOS EN EL ENTORNO CONTAMINADO POR EL
Todos los jabalíes inoculados por vía intramuscular se infectaron con el aislado virulento del VPPA y desarrollaron signos clínicos compatibles con la enfermedad. El virus provocó rápida progresión de la enfermedad. Los animales presentaron fiebre, depresión y anorexia. Uno de ellos tenía disnea y diarrea hemorrágica.


En el momento de la muerte, todos los animales presentaron una importante viremia.
FIGURA 1
Esquema del diseño del muestreo ambiental con esponjas hidratadas con líquido inactivador e hisopos hidratados con PBS.
La necropsia reveló hallazgos patológicos compatibles con la PPA y la presencia del virus en los tejidos ha sido confirmada por la prueba de la qPCR.
ESTOS RESULTADOS CONFIRMAN QUE EL ENTORNO ESTABA CONTAMINADO CON EL VIRUS
Instalaciones (paredes, puertas y barras metálicas)
Bebederos Suelo 5 jabalíes
x2 x2 x2 x1 x2 x2 x2
Hisopos
(4 muestras de piel)
Comederos x2 x2 Esponjas hidratadas con líquido inactivador
de algodón (1 ml PBS)
Nº 4 | Abril 2022 Método de muestreo sencillo y seguro para monitorizar el virus de la Peste Porcina Africana 78
VPPA
DIAGNÓSTICO
CAPACIDAD DE DETECCIÓN DEL VIRUS EN MUESTRAS AMBIENTALES

Todas las muestras recogidas de superficies confirmaron la presencia de ADN del VPPA en el ambiente y se obtuvieron resultados similares utilizando ambos métodos de muestreo ambiental (Tabla 1)
No hubo diferencias significativas en la detección del ADN del VPPA cuando se tomaron muestras con esponjas o con hisopos de algodón.
Las muestras recogidas de superficies en contacto directo con los animales presentaban, en general, un mayor número de copias del genoma del VPPA que las recogidas de superficies a las que los animales no podían acceder directamente a las instalaciones.
Las muestras recogidas de las pieles de los animales utilizando esponjas contenían una carga menor de ADN del VPPA (1,08 × 103 ± 0,63 × 103 copias/μl) que las superficies ambientales (2,92 × 10 5 ± 1,5 × 10 5 copias/μl).
TABLA 1 Presencia del virus de la Peste Porcina Africana (VPPA) en muestras ambientales.
de muestreo
Comedero A 1,55 × 10⁵ 2,40 × 10⁶ Comedero B 1,21 × 10⁶ 3,27 × 10⁶ Bebedero A 9,99 × 10⁴ 6,10 × 10² Bebedero B 2,13 × 10⁵ 2,25 × 10⁶ Suelo A 6,47 × 10⁵ 6,43 × 10⁵ Suelo B 1,87 × 10³ 1,73 × 10³ Instalaciones A 2,17 × 10³ 1,48 × 10⁵ Instalaciones B 4,86 × 10³ 3,31 × 10⁶ INVESTIGACIÓN 79
Resultados de la qPCR (copias del genoma/μl) Punto
Esponja Hisopo de algodón
ENSAYO 2
ENSAYO 2
VALIDACIÓN DE LAS PROPIEDADES INACTIVADORAS DEL LÍQUIDO TENSIOACTIVO (EXPERIMENTO IN VIVO)
VALIDACIÓN DE LAS PROPIEDADES INACTIVADORAS DEL LÍQUIDO TENSIOACTIVO (EXPERIMENTO IN VIVO)
DISEÑO EXPERIMENTAL
INOCULACIÓN DE LOS LECHONES
Diez lechones de 3 meses de vida y 20-25 kg fueron divididos aleatoriamente en cuatro grupos experimentales, tres de ellos inoculados con 1 ml de inóculo, quedando un grupo sin inocular (grupo centinela) (Tabla 2).
El primer grupo de cerdos (Ambiente; n = 2) se inoculó con el pool de muestras ambientales recogidas con esponjas hidratadas con el líquido inactivador de un entorno contaminado por el VPPA.
El inóculo se preparó como un pool de muestras ambientales recogidas con las esponjas hidratadas con el líquido inactivador. Se seleccionaron cuatro muestras ambientales: dos muestras con una baja carga viral (Instalaciones A, Instalaciones B) y otras dos con una alta carga viral (Comedero B, Suelo A).
Se tomaron 500 μl de cada muestra, preparándose un total de 2 ml de inóculo (1 ml/animal).
El segundo grupo (Armenia07; n = 2) se inoculó con un aislado del genotipo II del VPPA altamente virulento y hemadsorbente, Armenia07, previamente inactivado con el líquido tensioactivo. Para el inóculo se seleccionó una carga viral alta de 105 HAD50
El efecto letal del modelo de infección por exposición directa con el aislado virulento procedente de animales o ambientes contaminados ha sido ampliamente descrito en cerdo y jabalí.
El tercer grupo (Control; n = 2) se inoculó con el líquido estéril utilizado para hidratar la esponja.
Cuatro cerdos centinela se mantuvieron en contacto y se alojaron en el mismo box que los animales inoculados (Centinela; n = 4).
EXAMEN CLÍNICO Y EUTANASIA
Los signos clínicos se registraron diariamente y se representaron con una puntuación clínica cuantitativa obtenida mediante la suma de los valores de ocho signos clínicos, según lo descrito por Gallardo et al.15,16 :
Fiebre (temperatura rectal > 40 °C)
Anorexia
Letargia
Hemorragia cutánea o cianosis
Inflamación articular
Hallazgos respiratorios
Secreción ocular
Hallazgos digestivos
La temperatura corporal se midió antes de cada muestreo y también, a los 3, 6, 10 y 14 días postinoculación (dpi).
Grupo Inóculo Dosis (copias del genoma/μl) Ambiente (n = 2) Pool de muestras ambientales 1,12 × 10⁵ Armenia07 (n = 2) Aislado de VPPA Armenia07 5,77 × 10⁵ Control (n = 2) Líquido inactivadorCentinela (n = 4) - -
TABLA 2
DIAGNÓSTICO Nº 4 | Abril 2022 Método de muestreo sencillo y seguro para monitorizar el virus de la Peste Porcina Africana 80
Protocolo de inoculación para cada grupo de animales.
Se tomaron muestras de sangre con EDTA y sangre coagulada para la preparación del suero de cada animal el día 0 (antes de la inoculación) y a los 4, 7, 12, 17, 19, 24 y 28 dpi. Posteriormente, las muestras fueron analizadas mediante técnicas de biología molecular como la qPCR.
Asimismo, durante la necropsia de los animales, se recogieron muestras de tejido (ganglios linfáticos, bazo, hígado, pulmón, corazón, riñón y médula ósea) para la detección del VPPA
RESULTADOS
Todos los animales sobrevivieron hasta el final del experimento (28 dpi).
Los lechones inoculados (n = 6) y los centinela (n = 4) no desarrollaron signos clínicos compatibles con la infección por VPPA y no se detectó la presencia del genoma viral en las muestras de sangre obtenidas de estos animales a lo largo del periodo experimental de 28 días.

La temperatura corporal de los animales inoculados y de los animales centinela estaba dentro del rango normal.
La necropsia no reveló lesiones macroscópicas compatibles con la infección por el VPPA y no se detectó ADN del virus en los tejidos analizados.

MUESTREO Y DETECCIÓN DEL ADN DEL VPPA
INVESTIGACIÓN
DISCUSIÓN
Los resultados obtenidos en dos estudios independientes confirmaron que el método permite la detección del genoma viral a partir de diferentes superficies con una sensibilidad similar a la de otros métodos comúnmente utilizados. Al mismo tiempo, el líquido tensioactivo utilizado para la hidratación de las esponjas permite realizar una inactivación completa del virus.
Las implicaciones prácticas derivadas de estos resultados son numerosas, ya que el nuevo método de muestreo puede agilizar el diagnóstico precoz de la PPA
El muestreo ambiental mediante las esponjas hidratadas con el líquido inactivador reveló una carga de VPPA similar a la obtenida con muestras recogidas con un método tradicional, utilizando un hisopo de algodón con PBS.
Dado que la sensibilidad de la prueba se mantiene con el nuevo método de muestreo, esto podría ser indicativo de que:
El ADN del VPPA se conserva bien a pesar de la inactivación viral.
Es posible realizar ensayos de biología molecular para detectar el ADN del VPPA obtenido de muestras recogidas con estas esponjas.
Las esponjas también permitirían tomar muestras en superficies mucho más amplias que las que se pueden cubrir con los hisopos, lo que aumentaría la posibilidad de detectar partículas virales en animales y entornos contaminados. Esto es particularmente interesante en el caso de vehículos de transporte de ganado y de los animales transportados, considerados un importante riesgo de la introducción del VPPA⁹.
Otra propiedad interesante de las esponjas es su capacidad para detectar el ADN del VPPA en pieles de animales.
No solo se ha demostrado que el presente método de muestreo tiene una sensibilidad suficiente para detectar el ADN viral, sino que también se ha confirmado su capacidad de inactivación del virus
En el experimento in vivo, los animales inoculados con el virus en solución con el líquido tensioactivo no se infectaron, a pesar de haber sido inoculados con un aislado altamente virulento.
En este estudio, la piel de los animales contenía una cantidad menor de ADN viral que las demás superficies muestreadas.
Esto podría explicarse por el hecho de que la piel/pelo de los animales es una superficie dinámica en la que las partículas víricas no permanecen mucho tiempo en comparación con otras superficies estáticas.
En cambio, las instalaciones, el suelo, los comederos o los bebederos pueden acumular grandes cantidades del genoma vírico durante largos periodos, debido a la estabilidad del virus. No obstante, es necesario conocer mejor la supervivencia del virus en la piel de los animales y en otras superficies ambientales.
No se observaron signos clínicos compatibles con la PPA ni viremia, y todos los lechones se mantuvieron en buen estado de salud hasta el final del experimento.
ESTOS RESULTADOS CONFIRMAN QUE EL MÉTODO DE MUESTREO DESCRITO INACTIVA EFICAZMENTE EL VIRUS, PROPORCIONANDO
DIAGNÓSTICO Nº 4 | Abril 2022 Método de muestreo sencillo y seguro para monitorizar el virus de la Peste Porcina Africana 82
UNA VALIOSA HERRAMIENTA PARA LA FUTURA VIGILANCIA DE LA PPA
Uno de los factores de riesgo más reconocidos de la introducción del VPPA son los vehículos de transporte de ganado contaminados.
Los análisis epidemiológicos previos de los brotes en Estonia (2015-2017) han demostrado que lo más probable es que el virus se haya introducido por una vía de transmisión indirecta. En la mayoría de las explotaciones comerciales, el virus se introdujo principalmente por fómites contaminados (vehículos, personas, herramientas)17

La posible contaminación de los vehículos de ganado puede proceder de las excreciones (heces, orina, secreción oral/nasal) de los animales infectados18. La limpieza y desinfección adecuada es una acción preventiva crucial para evitar la reinfección a partir de fuentes ambientales (SANTE/7113/2015: Enfoque estratégico de la gestión de la peste porcina africana para la UE).
La reciente introducción de la PPA en países previamente libres de la enfermedad ha confirmado que es necesario mejorar las técnicas de muestreo no invasivas y las pruebas de diagnóstico de las muestras ambientales para optimizar el control de la enfermedad19. Dado que la ausencia del ADN residual del virus de la PPA es una garantía para la seguridad de los animales vivos, la capacidad de las esponjas para la detección del virus en las pieles de los animales podría ser especialmente interesante en el caso de los cerdos transportados.
Esta metodología podría emplearse como una herramienta adicional en el diagnóstico de la PPA, permitiendo la detección temprana de la posible infección por VPPA en los animales transportados y mejorando en gran medida el bienestar animal. Sin embargo, estas propiedades necesitarían más estudios de validación.
Es la primera vez que se confirman las propiedades inactivadoras del líquido tensioactivo frente al VPPA, a pesar de mantenerse el genoma vírico. Si el virus es inactivado en la muestra original, el procesamiento puede acelerarse significativamente, facilitando el envío de las muestras potencialmente contaminadas con el VPPA en los países con niveles de bioseguridad más bajos.
La aplicación de esta nueva metodología de muestreo puede ayudar a aumentar la capacidad de diagnóstico en los principales puntos de riesgo, contribuyendo así a la prevención y el control de la enfermedad.
Es una herramienta muy valiosa para monitorizar la presencia del virus en las granjas de traspatio donde los animales viven en semi-libertad.
LA
DE
METODOLOGÍA
AYUDAR
LA CONTAMINACIÓN
A LA
IMPLEMENTACIÓN
ESTA NUEVA
DE MUESTREO PODRÍA
A EVALUAR
EN PUNTOS CRÍTICOS, CONTRIBUYENDO
PREVENCIÓN Y CONTROL DE LA ENFERMEDAD COMO EL PROCESAMIENTO DE LA MUESTRA PODRÍA REALIZARSE EN CONDICIONES DE LABORATORIO DE NIVEL BÁSICO (BSL-2), MUCHOS LABORATORIOS TENDRÍAN LA CAPACIDAD DE DIAGNOSTICAR RÁPIDAMENTE LA ENFERMEDAD
INVESTIGACIÓN 83
En conclusión, se trata de un método eficaz para recuperar sistemáticamente muestras genómicas VPPA en diferentes superficies, lo que tiene una gran importancia práctica para evaluar la eficacia de la desinfección de vehículos que transportan animales vivos o productos con riesgo de contaminación.
Este método proporciona una base importante para la validación y las pruebas de detección temprana del VPPA que pueden evaluarse sin los requisitos de bioseguridad de un laboratorio de nivel 3 (BSL-3), al menos en los países afectados por la PPA.
Artículo traducido y adaptado de: Kosowska, A., Barasona, J., Barroso-Arévalo, S., Rivera, B., Domínguez, L., & Sánchez-Vizcaíno, J. (2021). A new method for sampling African swine fever virus genome and its inactivation in environmental samples. Scientific Reports, 11(1). doi: 10.1038/s41598-021-00552-8. (CC BY 4.0).
BIBLIOGRAFÍA
1. Arias, M., Jurado, C., Gallardo, C., Fernández-Pinero, J. & Sánchez-Vizcaíno, J. M. Gaps in African swine fever: Analysis and priorities. Transbound. Emerg. Dis. 65, 235–247 (2018).
2. OIE. 2020 WAHID Database. https:// www. oie. int/ wahis_2/ public/ wahid. php/ Diseaseinf ormation/Diseasedistributionmap. Accessed 18/01/2020.
3. OIE. 2020. https:// oiebu lletin. com/? page_ id= 150. Accessed 09/10/2020.
4. Dixon, L. K., Escribano, J. M., Martins, C., Rock, D. L., Salas, M. L., & Wilkinson, P. J. (2005). Asfarviridae. Virus Taxonomy, Eighth Report of the ICTV, 135–143.
5. Bosch, J. et al. Update on the risk of introduction of African swine fever by wild boar into disease-free european union countries. Transbound. Emerg. Dis. 64, 1424–1432 (2017).
6. Beltrán-Alcrudo, D., Arias, M., Gallardo, C., Kramer, S. & Penrith, M. L. African swine fever: detection and diagnosis—A manual for veterinarians. FAO Animal Production and Health Manual. (2017).
7. Sánchez-Vizcaíno, J. M., Mur, L., Gomez-Villamandos, J. C. & Carrasco, L. An update on the epidemiology and pathology of African swine fever. J. Comp. Pathol. 152, 9–21 (2015).
8. Bellini, S., Rutili, D. & Guberti, V. Preventive measures aimed at minimizing the risk of African swine fever virus spread in pig farming systems. Acta Vet. Scand. 58, 1–10 (2016).
9. Mur, L., Martínez-López, B. & Manuel Sánchez-Vizcaíno, J. Risk of African swine fever introduction into the European Union through transport-associated routes: returning trucks and waste from international ships and planes. (2012).
10. Gallardo, M. C. et al. African swine fever: A global view of the current challenge. Porc. Heal. Manag. 1, 1–14 (2015).
11. Costard, S. et al. African swine fever: How can global spread be prevented?. Philos. Trans. R. Soc. B Biol. Sci. 364, 2683–2696 (2009).
12. Singh, D., Joshi, K., Samuel, A., Patra, J. & Mahindroo, N. Alcohol-based hand sanitizers as first line of defense against SARS CoV-2: A review of biology, chemistry and formulations. Epidemiol. Infect. (2020).
13. Juszkiewicz, M., Walczak, M., Mazur-Panasiuk, N. & Woźniakowski, G. Effectiveness of chemical compounds used against African swine fever virus in commercial available disinfectants. Pathogens 9, 1–10 (2020).
14. Quembo, C. J., Jori, F., Vosloo, W. & Heath, L. Genetic characterization of African swine fever virus isolates from soft ticks at the wildlife/domestic interface in Mozambique and identification of a novel genotype. Transbound. Emerg. Dis. 65, 420–431 (2018).
15. Gallardo, C. et al. Assessment of African swine fever diagnostic techniques as a response to the epidemic outbreaks in eastern european union countries: How to improve surveillance and control programs. J. Clin. Microbiol. 53, 2555–2565 (2015).
16. Gallardo, C. et al. Experimental transmission of African swine fever (ASF) low virulent isolate NH/P68 by surviving pigs. Transbound. Emerg. Dis. 62, 612–622 (2015).
17. Nurmoja, I. et al. Epidemiological analysis of the 2015–2017 African swine fever outbreaks in Estonia. (2018).
18. Davies, K. et al. Survival of African swine fever virus in excretions from pigs experimentally infected with the Georgia 2007/1 Isolate. Transbound. Emerg. Dis. 64, 425–431 (2017).

ESTE MÉTODO DE MUESTREO SENCILLO, RÁPIDO Y ECONÓMICO REDUCIRÁ EL RIESGO DE TRANSMISIÓN DEL VPPA ENTRE EXPLOTACIONES, MEJORARÁ EL BIENESTAR DE LOS ANIMALES Y EVITARÁ IMPORTANTES PÉRDIDAS ECONÓMICAS
DIAGNÓSTICO Nº 4 | Abril 2022 84 Método de muestreo sencillo y seguro para monitorizar el virus de la Peste Porcina Africana
PCV-2 UN PEQUEÑO VIRUSUNA GRAN AMENAZA


EEl circovirus porcino tipo 2 (PCV-2) es un virus icosaédrico no envuelto de genoma circular del género Circovirus (familia Circoviridae), dentro del cual se han encontrado otras tres especies, PCV-1, PCV-3 y, más recientemente, PCV-4. Este virus, que codifica para tan solo 3 proteínas mayoritarias (Rep, Rep’ y Cap), es el más pequeño que existe capaz de infectar a mamíferos. Sin embargo, con su diminuto genoma de simple cadena de ADN de aproximadamente 1,7 kb, es capaz de convertirse en una gran amenaza para una granja.

C
E
Florencia Correa Fiz Investigadora del Programa de Sanidad Animal del IRTA-CReSA
EPIDEMIOLOGÍA 85
Descarga el PDF
LA AMENAZA DEL PCV-2
El PCV-2 es el virus causante de la enfermedad sistémica asociada a PCVs (PCVD), específicamente el Síndrome Multisistémico de Desmedro Postdestete (PMWS), ocasionando enormes pérdidas económicas al sector, especialmente debido a la gran pérdida de peso y alta mortalidad que experimentan los animales enfermos (López-Soria et al. 2011)
Entre los factores que convierten a este pequeño virus en una gran amenaza, se encuentran:
1 2
El hecho de que se encuentre distribuido mundialmente en la cabaña porcina, posiblemente asociado a su alta capacidad de resistencia ambiental
La alta capacidad de mutación y generación de nuevos genotipos.
Existen diversos genotipos que se han definido utilizando la región de la proteína de la cápside (gen cap) , considerada el marcador filogenético y epidemiológico más relevante (Franzo et al. 2018)
Se han definido hasta 9 genotipos distintos de PCV-2 (PCV-2aPCV-2i), aunque PCV-2a, PCV-2b y PCV-2d son los más prevalentes en la industria porcina actual. Estos genotipos muestran un elevado porcentaje (93%) de similitud y no se han encontrado diferencias en la patogenicidad o virulencia entre ellos.
La alta tasa de mutación que presenta PCV-2 se debe al hecho de que, como todo virus de ADN de cadena simple, utiliza la maquinaria celular en un primer paso en la infección, pero luego es capaz de sintetizar (transcribir y traducir) sus propias proteínas replicasas para poder continuar infectando nuevas células.
LAS ENZIMAS
REPLICASAS DEL VIRUS (ORF1, REP; ORF3, REP’) NO TIENEN ACTIVIDAD CORRECTORA DE ERRORES (‘PROOFREADING ACTIVITY’)
HACIENDO QUE LA GENERACIÓN DE ERRORES O APARICIÓN DE MUTACIONES TRAS
LA REPLICACIÓN
SEA MUCHO MÁS FRECUENTE
VARIABILIDAD GENÉTICA EL ARMA SECRETA DEL PCV2
El ciclo de vida de un virus está dominado por un complejo equilibrio entre interacción y competición con el hospedador. Para eludir las defensas, los virus han conseguido desarrollar distintas estrategias para inhibir o evadir la respuesta inmunitaria del hospedador.

Mientras que los virus complejos poseen una variedad de proteínas que son capaces de interaccionar con las vías inmunitarias específicas del hospedador, los virus pequeños, como PCV-2, centran sus oportunidades en la generación de nuevas variantes (cuasiespecies) capaces de evadir la respuesta inmunitaria y expandir así su población. VIROLOGÍA Nº 4 | Abril 2022 PCV-2 Un pequeño virus - Una gran amenaza 86
VARIABILIDAD INTRA-HOSPEDADOR VARIABILIDAD INTRA-HOSPEDADOR
Con el objeto de entender la variabilidad genética que ocurre dentro de los animales una vez infectados, se suelen analizar las variantes generadas naturalmente en animales de granja. Para ello, se estudiaron lechones desde la primera vez que eran infectados con PCV-2 y se evaluó la variabilidad del genoma de PCV-2 intra-hospedador durante 4 semanas consecutivas (Correa-Fiz F. et al. 2018)
Analizando los datos obtenidos longitudinalmente por secuenciación masiva, se comprobó la dinámica de aparición de mutaciones intra-hospedador
En general, se observó una dinámica fluctuante con la aparición y desaparición de mutaciones de manera transitoria. El patrón observado dependía de la granja analizada, pero, al evaluar las mutaciones que conducían a un cambio a nivel de aminoácidos (cambios no sinónimos) en la proteína de la cápside, se pudieron detectar ciertas similitudes entre granjas.
Los aminoácidos sujetos a modificaciones se encontraron en posiciones que se predicen expuestas en la estructura de la partícula vírica cuando ésta es modelada in silico, señalando así al papel central que tiene la inmunidad en la diversidad de PCV-2 dentro del hospedador
En una de las granjas analizadas, los animales fueron trasladados durante el estudio y se mezclaron con lechones de otros orígenes. El escenario en este caso, cambió drásticamente.
En la mayoría de los animales, se observó coinfección con diferentes genotipos después del traslado, incrementándose de esta manera la posibilidad de recombinación entre diferentes genotipos o cepas, lo que puede asociarse con un mayor riesgo de padecer PCVD en la granja. Curiosamente, en todos los eventos de coinfección se identificó particularmente PCV-2d, sugiriendo que este genotipo podría estar asociado con una mayor persistencia

EPIDEMIOLOGÍA 87
VARIABILIDAD GENÉTICA VS SEVERIDAD CLÍNICA
VARIABILIDAD GENÉTICA VS SEVERIDAD CLÍNICA
En otro estudio realizado bajo condiciones controladas en el laboratorio, se estudiaron los animales después de la infección experimental con una cepa de PCV-2b (Correa-Fiz F. et al. 2020). El análisis de la variabilidad del genoma de PCV-2 se realizó longitudinalmente durante 3 semanas consecutivas post-infección.
Tras la infección, se analizó la cantidad de PCV-2 en suero (viremia) en la tercera semana, se estableció la ganancia de peso de los lechones y se realizaron las necropsias para evaluar los diferentes criterios histopatológicos establecidos para el diagnóstico de PCVD (Segalés J. 2012) :
Depleción linfocitaria
Inflamación granulomatosa de los tejidos linfoides
Cantidad elevada de ADN de PCV-2 por hibridación in situ en estos tejidos
En base a estos resultados, se dividieron los animales en tres grupos para su análisis.
El grupo de animales diagnosticados con PCVD mostró la menor variabilidad genética, posiblemente debido a la inmunosupresión característica de esta enfermedad que podría inducir una menor presión inmunológica sobre el virus.
La mayor variabilidad observada fue en el grupo de animales que había permanecido con una infección subclínica y alta viremia (≥ 7 log10 PCV-2 copias de genoma/mL).
El grupo con infección subclínica y baja viremia (< 7 log10 PCV-2 copias de genoma/mL), desarrolló un patrón intermedio.
VARIABILIDAD GENÉTICA DEL PCV-2 VS SEVERIDAD DE LA ENFERMEDAD
Lechón con infección clínica (PCVD)
Lechón con infección subclínica + ↓ viremia
Lechón con infección subclínica + ↑ viremia
QUE EXISTE ENTRE VARIABILIDAD GENÉTICA Y LA SEVERIDAD DE LA ENFERMEDAD (PCVD)
LAS DIFERENCIAS OBSERVADAS DEMUESTRAN LA CONEXIÓN
Resulta interesante que en ambos grupos con infección subclínica (alta o baja viremia) se detectaron animales capaces de albergar virus con una variabilidad sorprendentemente alta (animales “hipermutantes”), especialmente en la región que codifica para la proteína Cap
Variabilidad baja Variabilidad intermedia Variabilidad alta
VIROLOGÍA Nº 4 | Abril 2022 PCV-2 Un pequeño virus - Una gran amenaza 88
La proteína de la cápside tiene propiedades inmunogénicas, siendo capaz de inducir una respuesta humoral y celular efectiva , por lo que no es sorprendente que sea la diana de las altas tasas de mutación encontradas y, por otro lado, el elemento común en la mayor parte de las vacunas comerciales diseñadas frente a PCV-2.
En cualquier caso, la alta variabilidad observada dentro del hospedador puede representar una estrategia efectiva para la persistencia del virus dentro del animal, al mismo tiempo que confiere la posibilidad de generar variantes capaces de expandirse en una escala más grande.

La presencia de animales “hipermutantes” podría tener un papel epidemiológico relevante, comportándose como incubadores y amplificadores de nuevas variantes que podrían ser transmitidas y seleccionadas en la población representando un alto riesgo para la granja en cualquier momento.
En conjunto, estos resultados ponen de manifiesto la importancia de reducir la circulación y persistencia de PCV-2 en granja como medio para reducir el riesgo de PCVD. Ciertamente, la aparición de nuevos genotipos en el futuro es bastante probable considerando la alta tasa de mutación de este virus de ADN de cadena simple que da lugar a la posibilidad de acumular mutaciones en su genoma.
Sin embargo, existen diversas estrategias que permiten abordar esta problemática:
Implementación de medidas más estrictas de bioseguridad en la granja que minimicen la mezcla de animales de distintos orígenes.
Implementación de programas de vacunación efectivas
Establecer nuevas prácticas que permitan fortalecer la inmunidad intrínseca de los animales.
Reforzar la vigilancia activa dirigida a detectar la aparición de nuevas variantes con distintas características inmunológicas a tiempo.
BIBLIOGRAFÍA
A., Valero O., Ramírez-Mendoza H., Mínguez A., Serrano J.M., Marín O., Callén A., Segalés J. Post-weaning multisystemic wasting syndrome (PMWS) clinical expression under field conditions is modulated by the pig genetic background. Vet Microbiol. 5, 352 (2011).
Franzo, G. & Segalés, J. Porcine circovirus 2 (PCV-2) genotype update and proposal of a new genotyping methodology PLoS One. 13(12): e0208585 (2018).
López-Soria S., Nofrarías M., Calsamiglia M., Espinal
Correa-Fiz, F., Franzo, G., Llorens, A., Segalés, J. & Kekarainen, T. Porcine circovirus 2 (PCV-2) genetic variability under natural infection scenario reveals a complex network of viral quasispecies. Sci. Rep. 8, 15469 (2018).
Correa-Fiz, F., Franzo, G., Llorens, A., Huerta, E., Sibila M., Kekarainen, T. & Segalés, J. Porcine circovirus 2 (PCV-2) genetic variability under natural infection scenario reveals a complex network of viral quasispecies. Sci. Rep. 10, 17747 (2020).
Segalés, J. Porcine circovirus type 2 (PCV2) infections: Clinical signs, pathology and laboratory diagnosis. Virus Res. 164, 10–19 (2012).
CASTRACIÓN 89
CON TODO ESTO, ES POSIBLE CONSIDERAR UN ESCENARIO EN EL QUE SE CONSIGA CONTROLAR MÁS RÁPIDA Y EFICAZMENTE A ESTE PEQUEÑO VIRUS, FRENANDO ASÍ SU
EVOLUCIÓN Y DISMINUYENDO LA GRAN AMENAZA QUE ÉSTA IMPLICA
DETECCIÓN Y DIVERSIDAD GENÉTICA DE CORONAVIRUS PORCINOS IMPLICADOS EN BROTES DE DIARREA EN ESPAÑA

C L
LLos coronavirus entéricos porcinos incluyen algunos de los patógenos virales más relevantes para el sector porcino, como el virus de la diarrea epidémica porcina (VDEP) o el virus de la gastroenteritis transmisible porcina (VGET), así como algunos otros virus recientemente identificados como el coronavirus entérico porcino (SeCoV), el deltacoronavirus porcino (PDCoV) o el alfacoronavirus entérico porcino (SeACoV).
El objetivo de este estudio fue la identificación y caracterización de los coronavirus que causan brotes entéricos en las explotaciones porcinas españolas y los resultados demostraron que el VDEP es patógeno relevante en España, confirmando también que ninguno de los nuevos coronavirus emergentes está circulando de forma significativa en nuestro país.




Dado que las características clínicas y lesionales de los brotes causados por diferentes virus entéricos son indistinguibles, la puesta a punto de herramientas diagnósticas y la vigilancia activa es fundamental para conocer la incidencia y evolución temporal de estos virus y para poder frenar su propagación en caso de aparición.

Héctor Puente, Héctor Argüello, Óscar Mencía Ares, Manuel Gómez García, Lucía Pérez‑Pérez, Clara Vega, Pedro Rubio y Ana Carvajal Departamento de Sanidad Animal, Universidad de León, España.


EPIDEMIOLOGÍA Nº 4 | Abril 2022 Detección y diversidad genética de coronavirus porcinos implicados en brotes de diarrea en España 90
Descarga el PDF
INTRODUCCIÓN A LOS CORONAVIRUS PORCINOS
Los coronavirus (CoV) infectan a una gran variedad de animales, tanto mamíferos como aves, ocasionando procesos respiratorios, entéricos e incluso hepáticos y neurológicos1. Pertenecen a la familia Coronaviridae, en la que se reconocen cuatro géneros basados en su agrupación filogenética: Alphacoronavirus, Betacoronavirus, Gammacoronavirus y Deltacoronavirus.
Los CoVs son virus con envoltura y su genoma está compuesto por un ARN no segmentado , monocatenario y de polaridad positiva con un tamaño de ∼30 kb, el más grande entre todos los virus ARN.
Desde el extremo 5' hasta el extremo 3', su genoma incluye, al menos, seis marcos de lectura abiertos (ORF):
ORF1a
ORF1b
ORF1a y ORF1b, codifican poliproteínas no estructurales con un rol fundamental en la replicación viral.
Espícula (S)
Envoltura (E)
Membrana (M)
Nucleocápside (N)
Los genes S, E, M y N codifican las correspondientes proteínas estructurales2
El primer coronavirus identificado en el ganado porcino fue el virus de la gastroenteritis transmisible (VGET). Sin embargo, actualmente, la relevancia de este virus es limitada debido a la amplia distribución de un mutante respiratorio del VGET, el coronavirus respiratorio porcino (CVRP), que protege parcialmente a los animales frente a la enfermedad entérica.
El virus de la diarrea epidémica porcina (VDEP) fue descrito por primera vez en Europa y Asia durante los años setenta y ochenta, respectivamente3
En Europa su incidencia disminuyó notablemente a partir de los años noventa, mientras que en Asia se ha mantenido como una de las principales causas de brotes de diarrea desde su aparición y hasta la actualidad.
En 2010 se describieron en China nuevas variantes altamente patógenas del VDEP, que se extendieron rápidamente a otros países de la región.
En América, el VDEP emergió en abril de 2013, extendiéndose de forma rápida por EE.UU. y otros países como Canadá, México o Colombia y causando importantes pérdidas económicas4
El VDEP también reapareció en Europa poco después de su primera descripción en los EE.UU., habiéndose notificado brotes de VDEP en varios países europeos desde 20145-7
Se han descrito dos genogrupos principales del VDEP, denominados INDEL o G1 y no INDEL o G2 , que se diferencian por inserciones-deleciones en la subunidad S1 del gen S8,9
LOS AISLADOS NO INDEL DE VDEP SE HAN ASOCIADO CON UNA MAYOR
VIRULENCIA Y UNA MEJOR TRANSMISIÓN HORIZONTAL10
Ambos genogrupos han sido identificados en granjas infectadas de Asia y América, mientras que en Europa no hay pruebas de la presencia del genogrupo G2 o no-INDEL , con la única excepción de un aislado detectado en una explotación porcina de Ucrania en 201411
Algunos CoVs codifican alguna otra proteína no estructural de función no claramente establecida.
C
INVESTIGACIÓN 91
EPIDEMIOLOGÍA
CORONAVIRUS PORCINOS EMERGENTES
En los últimos años se han descubierto nuevos coronavirus que afectan a los cerdos causando un cuadro clínico entérico indiferenciable del causado por el VGET y el VDEP.
Se ha identificado un virus quimérico producido por la recombinación del VGET o su mutante respiratorio CVRP (secuencia principal) con el VDEP (que aporta el gen S) (Figura 1), denominado coronavirus entérico porcino (SeCoV), en varios países europeos, entre ellos España12-15
Además, en 2012, se describió un deltacoronavirus porcino (PDCoV) en Hong Kong16, detectándose posteriormente en explotaciones porcinas de EEUU, Canadá y de varios países asiáticos17.
Finalmente, se ha descrito un nuevo alfacoronavirus porcino, denominado alfacoronavirus entérico porcino (SeACoV) o también coronavirus del síndrome de diarrea aguda porcina (SADS-CoV) como agente etiológico de brotes de diarrea grave en lechones neonatos en China18-22
Representación esquemática de la organización del genoma del VGET, VDEP y SeCoV.
La aparición de estos nuevos CoVs y la reaparición del VDEP en Europa hace necesario realizar estudios que permitan determinar el impacto de estos virus en las explotaciones porcinas de nuestro ámbito.
Nuestro trabajo pretende conocer la prevalencia de los diferentes CoVs entéricos en España a través del estudio de brotes de diarrea en granjas porcinas españolas entre 2017 y 2019.
FIGURA 1
0 5’ 5’ 5’ 3’ 3’ 3’ VGET VDET SeCov 10 20 28kb ORF1a ORF1b S E N M 3 ORF1a ORF1b S E N M 3 ORF1a ORF1b S E N M 3
CORONAVIRUS PORCINOS EMERGENTES Nº 4 | Abril 2022 Detección y diversidad genética de coronavirus porcinos implicados en brotes de diarrea en España 92
PREVALENCIA DE CORONAVIRUS ENTÉRICOS PORCINOS EN ESPAÑA

MATERIAL Y MÉTODOS MATERIAL Y MÉTODOS
RECOGIDA Y PREPARACIÓN DE LAS MUESTRAS
El estudio se realizó entre enero de 2017 y marzo de 2019 en 106 explotaciones porcinas con brotes de diarrea en los que se sospechaba una etiología viral distribuida por 22 provincias de la mitad norte de España (Figura 2)
Los brotes afectaron a lechones lactantes (<21 días) (28 explotaciones), cerdos de transición o precebo (21-70 días) (17 explotaciones) o cerdos de engorde (>70 días) (61 explotaciones) y, en todos los casos, se remitieron muestras de heces para su diagnóstico a la Unidad de Enfermedades Infecciosas del Departamento de Sanidad Animal de la Universidad de León. De cada granja se enviaron entre dos y seis muestras individuales que se unieron para preparar una única muestra o mezcla por granja.
DIAGNÓSTICO MOLECULAR DE LOS CORONAVIRUS ENTÉRICOS PORCINOS

Se llevaron a cabo dos RT-PCR dúplex para la detección de SeACoV (ORF1ab), VGET/SeCoV (gen N), VDEP/SeCoV (gen S) y PDCoV (gen N) (Tabla 1). También se realizaron dos RT-PCR convencionales para confirmar el SeCoV, excluyendo una posible coinfección VDEP-VGET, mediante la detección del gen M del VDEP y del gen S del VGET.
TABLA 1
Genes diana utilizados para la detección de coronavirus entéricos porcinos mediante RT-PCR.
Tipo de
Tamaño
Referencia RT-PCR múltiplex 1 SeACoV ARN polimerasa dependiente 754 (20) VGET/SeCoV Nucleoproteína 612 (32) RT-PCR múltiplex 2 VDEP/SeCoV Espícula 651 (33) PDCoV Nucleoproteína 497 (34) RT-PCR convencional 1 VGET Espícula 858 (33) RT-PCR convencional 2 VDEP Membrana 412 (32) INVESTIGACIÓN 93
PCR Agente Gen diana
del producto (pb)
SECUENCIACIÓN DEL GEN S DEL VDEP
En todas las muestras positivas a VDEP se secuenció el gen S amplificando cuatro fragmentos superpuestos (Verso 1-Step RT-PCR ReddyMix, Thermo Scientific). Las secuencias completas del gen S obtenidas pueden consultarse en la plataforma GenBank con los números de acceso MW251343 a MW251378 (Tabla 2).
Adicionalmente, en cinco aislados obtuvimos la secuencia completa del genoma viral utilizando un protocolo de secuenciación de nueva generación específico para virus ARN desarrollado por investigadores de la Universidad Autónoma de Barcelona15.
TABLA 2
Lista de aislados del virus de la diarrea epidémica porcina (VDEP) recuperados en este estudio. Se obtuvo la secuencia completa del gen S para todos los aislados del VDEP.
*Aislados de VDEP secuenciados previamente de Nova et al.15
Aislado Fecha de muestreo País Provincia Nº de acceso SP-VC2* 12/01/2017 España Valladolid MN692784 SP-VC3 17/01/2017 España Valladolid MW251343 SP-VC4 17/01/2017 España Burgos MW251344 SP-VC16 01/03/2017 España Zaragoza MW251345 SP-VC18 07/03/2017 España Segovia MW251346 SP-VC19 07/03/2017 España Segovia MW251347 SP-VC27 06/06/2017 España Ourense MW251348 SP-VC29 06/06/2017 España Ourense MW251349 SP-VC46 11/01/2018 España Valladolid MW251350 SP-VC51* 02/02/2018 España Ourense MN692788 SP-VC52 02/02/2018 España Ourense MW251351 SP-VC53 05/02/2018 España Teruel MW251352 SP-VT13 14/02/2018 España Valladolid MW251353 SP-VC54 14/02/2018 España Castellón MW251354 SP-VC55 15/02/2018 España Girona MW251355 SP-VC57* 02/03/2018 España Castellón MN692789 SP-VC61 18/04/2018 España Castellón MW251356 SP-VC62* 03/05/2018 España Castellón MN692790 SP-VC63 03/05/2018 España Zaragoza MW251357 SP-VC66 30/05/2018 España Ourense MW251358 SP-VC68 20/06/2018 España Zaragoza MW251359 SP-VC75 05/09/2018 España Castellón MW251360 SP-VC77 05/09/2018 España Ourense MW251361 SP-VC81 06/10/2018 España Ourense MW251362 SP-VC87 07/10/2018 España Lérida MW251363 SP-VT86 07/11/2018 España Barcelona MW251364 SP-VT87 29/11/2018 España Valladolid MW251365 SP-VT108 10/01/2019 España Barcelona MW251366 SP-VC89 18/01/2019 España Ourense MW251367 SP-VC90 22/01/2019 España Ourense MW251368 SP-VC92 24/01/2019 España Ourense MW251369 SP-VC93 25/01/2019 España Ourense MW251370 SP-VC94 08/02/2019 España Ourense MW251371 SP-VC95 12/02/2019 España Ourense MW251372 SP-VC96 12/02/2019 España Ourense MW251373 SP-VC97 14/02/2019 España Ourense MW251374 SP-VC98 19/02/2019 España Ourense MW251375 SP-VC99 19/02/2019 España Ourense MW251376 SP-VC100* 28/02/2019 España Ourense MN692791 SP-VC101 28/02/2019 España Ourense MW251377 POR-VC102 14/03/2019 Portugal Coimbra MW251378
Nº 4 | Abril 2022 Detección y diversidad genética de coronavirus porcinos implicados en brotes de diarrea en España 94
EPIDEMIOLOGÍA
RESULTADOS RESULTADOS PREVALENCIA DE CORONAVIRUS ENTÉRICOS EN LOS BROTES DE
No se detectó el VGET, el SeCoV, el PDCoV ni el SeACoV en ninguna de las muestras, siendo el VDEP el único coronavirus detectado en 41 de los 106 brotes investigados (38,7 %).
A pesar de que no se observaron diferencias significativas en el número de brotes confirmados en función de la edad de los animales afectados, podemos destacar que la mayoría de los brotes se produjeron en cerdos en crecimiento o transición (9 explotaciones positivas de 17, 52,9 %) seguidos por los cerdos de engorde (24 explotaciones positivas de 61, 39,3 %).
Mapa que muestra la distribución de los brotes de diarrea con sospecha viral investigados en este estudio (área sombreada). Se indica el número de explotaciones muestreadas (círculo turquesa) y el de explotaciones positivas al VDEP por provincia (círculo turquesa claro).
El VDEP estuvo implicado en menor medida en los brotes de diarrea que afectaron a los lechones lactantes (8 granjas positivas de 28, 28,6 %).
Se detectaron explotaciones positivas al VDEP en todo el área muestreada, con al menos un brote positivo en 10 de las 22 provincias incluidas en el estudio (Figura 2). No se observaron diferencias significativas en el número de brotes confirmados de VDEP entre provincias (p=0,286).
En lo que respecta a la distribución temporal , la mayoría de los brotes ocurrieron durante el primer trimestre del año (p=0,041) (Figura 3), en los meses más fríos. La detección del VDEP también fue más frecuente durante los tres primeros meses del año, aunque sin alcanzar diferencias significativas (p=0,097).
Distribución de los brotes de sospecha de diarrea viral y de los brotes positivos a VDEP desde enero de 2017 hasta marzo de 2019. El número de explotaciones muestreadas y de explotaciones positivas al VDEP se muestra encima de las columnas. Se muestra el porcentaje de brotes positivos al VDEP y el porcentaje de brotes positivos a VDEP en cada trimestre estudiado.
FIGURA 2
FIGURA 3
DIARREA PORCINA Nº de granjas investigadas 1 0 1 0 1 0 1 0 3 2 2 0 12 5 4 1 2 0 1 0 5 3 5 1 10 5 3 1 2 2 1 1 2 0 1 0 2 0 2 0 3 0 41 19 Nº de granjas positivas en
VDEP
Nº de granjas investigadas Ene-Mar 2017 9 21 25 20 15 10 5 0 9 0 0 6 16 9 9 14 15 6 (28,6%) 2 (22,2%) 8 (50%) 5 (55,5%) 2 (22,2%) 4 (33,3%) 14 (93,3%) Abr-Jun 2017 Jul-Sep 2017 Oct-Dic 2017 Ene-Mar 2018 Abr-Jun 2018 Jul-Sep 2018 Oct-Dic 2018 Ene-Mar 2019 Nº de granjas positivas a VDEP INVESTIGACIÓN 95
ANÁLISIS FILOGENÉTICO BASADO EN LAS SECUENCIAS DE NUCLEÓTIDOS DEL GEN
S DEL VDEP
Las secuencias completas del gen S de todas las muestras positivas del VDEP41 se compararon con las secuencias disponibles del VDEP y del SeCoV (Figura 4)
El árbol filogenético mostró que todos los aislados del VDEP recuperados en España entre 2017-2019 corresponden al genogrupo INDEL 2 o G1b, agrupándose con aislados europeos recientes de este coronavirus y con algunos aislados recientes de EE.UU. y Asia, claramente separados de los aislados del genogrupo G2 o no INDEL o G2, así como de los aislados originales de VDEP europeos o asiáticos incluidos en el genogrupo INDEL 1 o G1a.
Se identificaron tres subgrupos o clústers a partir de los aislados españoles de VDEP que hemos identificado como INDEL 2.1, 2.2 y 2.3 (Figuras 4 y 5)

El primero de estos subgrupos incluyó dos aislados españoles recuperados en 2018 y 2019 junto con otros aislados del VDEP españoles y europeos recuperados entre 2014 a 2016.
El clúster INDEL 2.2 incluyó aislados españoles de 2014 a 2019, todos ellos próximos geográficamente (misma región) y recuperados de explotaciones pertenecientes a una única empresa productora, junto con cepas asiáticas y americanas del VDEP del mismo periodo de tiempo.
3
El subgrupo INDEL 2.3 incluyó aislados españoles recientes, de 2017 a 2019, distribuidos por toda la zona de muestreo y que se agruparon con cepas del VDEP coetáneas de diferentes países europeos (Hungría, Eslovenia, Holanda, Alemania o Francia).
Este subgrupo corresponde a una variante recombinante del VDEP que incluye un fragmento del gen S del SeCoV y que ha sido descrita previamente en Hungría y Eslovenia (24,25), así como en España15
FIGURA 4
coronavirus porcinos
Árbol filogenético basado en las secuencias completas del gen S de los coronavirus porcinos entéricos disponibles en GenBank. Los números a lo largo del árbol representan el valor de confianza para una determinada rama interna basado en 500 réplicas Bootstrap (sólo se muestran los valores superiores a 70). Los símbolos sobre las cepas destacan los aislados españoles de VDEP de este estudio. Los círculos rellenos identifican los aislados secuenciados en esta investigación mientras que los triángulos rellenos identifican los aislados previamente secuenciados por de Nova et al.15 El número de acceso al GenBank, el país y el año del brote también se muestran tras el nombre del aislado. Los genogrupos y subgrupos referidos en el texto se incluyen a la derecha del árbol. Las barras de escala indican las sustituciones de nucleótidos por sitio. PEDV, TGEV y PRCV son las siglas inglesas de VDEP, VGET y CVRP, respectivamente. EPIDEMIOLOGÍA Nº 4 | Abril 2022 Detección y diversidad genética de
1 2 implicados en brotes de diarrea en España 96
FIGURA 5
Árbol filogenético basado en las secuencias completas del gen S que incluye todos los coronavirus porcinos entéricos españoles disponibles en GenBank. Los números a lo largo del árbol representan el valor de confianza para una determinada rama interna basado en 500 réplicas Bootstrap (sólo se muestran los valores superiores a 70).
Los símbolos sobre las cepas destacan los aislados españoles de VDEP de este estudio. Los círculos rellenos identifican los aislados secuenciados en esta investigación y los triángulos rellenos identifican los aislados previamente secuenciados por de Nova et al.15. El número de acceso al GenBank, la provincia y el año del brote también se muestran tras el nombre del aislado.
Los genogrupos y subgrupos referidos en el texto se incluyen a la derecha del árbol. Las barras de escala indican las sustituciones de nucleótidos por sitio. Negro: aislados anteriores a 2000; Rojo: aislados de 2014; Gris: aislados de 2015; Morado: aislados de 2016; Amarillo: aislados de 2017; Verde: aislados de 2018; Azul: aislados de 2019. PEDV es la sigla inglesa de VDEP.

INVESTIGACIÓN 97
RESULTADOS DISCUSIÓN
La identificación reciente de nuevos coronavirus porcinos, como el PDCoV o el SeACoV, junto con la emergencia y reemergencia del VDEP han renovado el interés por estos virus entéricos que se asocian a diarreas agudas y de alta morbilidad en cerdos de todas las edades, así como a elevada mortalidad en neonatos en las explotaciones sin inmunidad.

LAS ENFERMEDADES
En el presente estudio se investigaron 106 brotes de diarrea con sospecha viral, ocurridos entre 2017 y 2019, siendo el VDEP el único CoV entérico detectado en las granjas porcinas españolas. Se identificó en cerca del 40% de los brotes investigados, confirmando su reemergencia de forma similar a lo descrito en varios países europeos26
La distribución temporal de la enfermedad fue estacional y la mayoría de los brotes entéricos asociados al VDEP se produjeron en los meses de invierno, cuando las bajas temperaturas favorecen la supervivencia del virus en el ambiente y facilitan su transmisión indirecta3,27
La mayoría de los brotes se observaron en la fase de transición o en el engorde.
La menor prevalencia del VDEP en los brotes entéricos que afectan a lechones podría ser explicada por la presencia de inmunidad maternal que protegería a los lechones en las primeras semanas de vida, o por un nivel más elevado de bioseguridad en las instalaciones de partos.
La pérdida de los anticuerpos maternales, unida a la mezcla de lechones tras el destete, podría explicar el mayor porcentaje de brotes positivos en los cerdos posdestete1.
Nuestro estudio es el primero en investigar activamente sobre los nuevos coronavirus entéricos como el PDCoV o el SeACoV en explotaciones porcinas de Europa.
Mientras que el SeACoV tiene una distribución geográfica limitada y solo se ha detectado en explotaciones porcinas de China18,19, el PDCoV se ha notificado en Estados Unidos, Corea del Sur, Tailandia y China28. Los estudios filogenéticos sugieren que el PDCoV identificado en Corea del Sur fue introducido desde EE.UU. 28, hecho que probaría su capacidad para propagarse internacionalmente.
ENTÉRICAS CAUSADAS POR ESTOS CoVs SON CLÍNICAMENTE INDISTINGUIBLES, POR LO QUE EL DIAGNÓSTICO DIFERENCIAL EN EL LABORATORIO ES UNA HERRAMIENTA ESENCIAL
EPIDEMIOLOGÍA Nº 4 | Abril 2022 Detección y diversidad genética de coronavirus porcinos implicados en brotes de diarrea en España 98
Nuestros resultados indican que, con gran probabilidad, ninguno de estos dos CoVs emergentes están presentes en la población porcina.
Dada la capacidad demostrada por estos virus para propagarse y emerger, junto a la probable falta de inmunidad previa de la población porcina europea, es fundamental implementar programas de monitorización que permitan una rápida detección y alerta que limiten su propagación entre países o continentes.
Finalmente, el análisis filogenético de las secuencias completas del gen S de todos los aislados del VDEP identificados demostró que, al igual que en otros países europeos5-7,27, todos los aislados del VDEP recuperados entre 2017 y 2019 correspondieron al genogrupo G1b o INDEL 2.
Se ha demostrado que este genogrupo causa una enfermedad menos grave y menos transmisible que el genogrupo G2 o INDEL3,8, hecho que podría explicar el limitado impacto económico de la reemergencia del VDEP en Europa en comparación con sus dramáticas consecuencias en Estados Unidos o en Asia29
CONCLUSIONES
Este trabajo confirma que el VDEP es una causa relevante de procesos entéricos en España, detectándose en casi el 40 % de los brotes de diarrea con sospecha de etiología viral entre 2017 y 2019. Sin embargo, dado que la mayoría de los brotes se producen en cerdos de transición o de engorde, el impacto clínico y económico de esta infección es limitado.
Tan solo se detecta circulación de aislados del VDEP del genogrupo G1b o INDEL 2. Además, la variante que incluye un fragmento recombinante en el gen S correspondiente al SeCoV es la más ampliamente distribuida.
No hemos detectado otros coronavirus entéricos como el VGET, SeCoV, PDCoV o SeACoV en los brotes de diarrea investigados. Sin embargo, la elevada capacidad de propagación de estos virus, unida a la posibilidad de eventos de mutación o recombinación, hace necesario mantener una vigilancia que permita detectar la posible aparición de alguno de estos CoVs o de nuevas variantes del VDEP.
Además, este análisis permitió identificar tres subgrupos de aislados, con ciertas relaciones geográficas siendo destacable que el subgrupo más frecuente y de distribución más amplia fue el identificado como clúster 2.3, descrito recientemente en diferentes países europeos14,15,24 y señalado como el más común en algunos estudios recientes30
Estos aislados se caracterizan por presentar un fragmento recombinante de aproximadamente 400 nucleótidos en el extremo 5' del gen S, siendo el VDEP y el SeCoV los progenitores mayor y menor, respectivamente. Dado que la proteína S del VDEP es una diana clave para los anticuerpos neutralizantes se ha propuesto que este evento de recombinación podría proporcionar algunas ventajas30,31 y explicar la amplia distribución de esta variante viral.
DESCARGAR BIBLIOGRAFÍA
Artículo traducido y adaptado de: Puente H, Argüello H, Mencía-Ares Ó, Gómez-García M, Rubio P and Carvajal A (2021) Detection and Genetic Diversity of Porcine Coronavirus Involved in Diarrhea Outbreaks in Spain. Front. Vet. Sci. 8:651999. doi: 10.3389/fvets.2021.651999.
INVESTIGACIÓN 99
BENEFICIOS PRODUCTIVOS
Y RENTABILIDAD DE LA VACUNACIÓN

ORAL DE LECHONES


PARA HACER FRENTE A LA DPD CAUSADA POR E. COLI
Frédéric Vangroenweghe
Elanco Benelux, Bélgica
VV-08949
V L
Descarga el PDF
LLa diarrea postdestete (DPD) en lechones tiene un enorme impacto económico a nivel mundial. Se caracteriza por un aumento de la mortalidad, pérdidas de peso significativas y retraso en el crecimiento, en combinación con un aumento de los costes de tratamiento, un mayor uso de antimicrobianos y una heterogeneidad de lotes más pronunciada2-8.
VACUNACIÓN Nº 4 | Abril 2022 Beneficios productivos y rentabilidad de la vacunación oral de lechones para hacer frente a la DPD causada por E. coli 100
Se ha demostrado que Escherichia coli (E. coli) enterotoxigénico (ETEC) es la causa más importante de la DPD9,10. El patotipo ETEC se caracteriza por tener dos tipos de factores de virulencia: Fimbrias o adhesinas: permiten la adhesión a los enterocitos porcinos.



Las fimbrias que aparecen con más frecuencia en E. coli ETEC aislado de lechones con DPD son la F4 (K88) y la F189-11. Las fimbrias F5 (K99), F6 (987P) y F41 rara vez aparecen en los aislados de E. coli procedentes de la DPD9-14







Enterotoxinas: alteran la homeostasis de los fluidos en el intestino delgado. Esto da lugar a diarrea en los días posteriores al destete, lo que se traduce en deshidratación, pérdida de condición corporal y mortalidad1
Las principales enterotoxinas asociadas a ETEC en los cerdos son la toxina termolábil (LT), la toxina termoestable a (STa) y la toxina termoestable b (STb). En algunos casos excepcionales, las cepas patógenas producen ambas enterotoxinas y la toxina Shiga (Stx2e)9-11
Si bien, la DPD se suele controlar mediante el uso de antimicrobianos, el desarrollo de resistencias de las cepas de E. coli y las nuevas regulaciones de la UE hacen necesario adoptar medidas de control alternativas, como la adaptación de las estrategias de alimentación o la inmunización.
Se ha estudiado la eficacia de diferentes estrategias nutricionales, como la adición de fibra dietética, la reducción de los niveles de proteína bruta, los cambios en la consistencia y el tamaño de las partículas del pienso, la suplementación de prebióticos, probióticos y ácidos Grasos de Cadena Media (AGCM) para minimizar la incidencia y la gravedad de la DPD y para mejorar la salud intestinal.
Además de las estrategias nutricionales, se están explorando otras estrategias preventivas1,15, entre ellas, la vacunación oral frente a E. coli.
Para la vacunación frente a E. coli F4-ETEC y F18-ETEC, es esencial que se desarrolle una respuesta inmunitaria activa en la mucosa frente a F4 y F18. Esto implica la producción local de anticuerpos sIgA específicos de F4 y/o F18 que impidan que las F4-ETEC y F18-ETEC patógenas se adhieran a los receptores intestinales de F4 y F18, reduciendo así los signos clínicos de la DPD15
Recientemente, la vacunación con una vacuna viva no patógena de E. coli F4, o de E. coli F4 y F18, ha demostrado su eficacia frente a la DPD asociada a E. coli F4-ETEC, y a F4-ETEC + F18-ETEC16,17
V
E.coli ETEC Enterotoxinas LT STa STb Fimbrias F4 F18
Anticuerpos sIgA específicos de F4 y/o F18
Inmunidad de mucosa frente a E. coli ETEC
PATOLOGÍA 101
DISEÑO EXPERIMENTAL
Se llevó a cabo la vacunación oral de lechones utilizando una vacuna viva no patógena de E. coli F4/F18 (Coliprotec® F4/F8; Elanco Animal Health) en 10 granjas de ciclo cerrado con un número variable de cerdas (160-1.200 cerdas/ granja) en Bélgica y Países Bajos (abril 2018 – diciembre 2020) para prevenir la DPD asociada a E. coli enterotoxigénica F4 (ETEC) o F18-ETEC.
El análisis de los patotipos de E. coli presentes en las granjas reveló que 6 granjas eran positivas para E. coli F18-ETEC y 4 granjas eran positivas para E. coli F4-ETEC.
A lo largo del estudio, se distribuyeron 49.936 y 46.929 lechones en los grupos Control y Vacunado, respectivamente.
La vacuna viva no patógena frente a E. coli F4/F18 induce un rápido inicio de la inmunidad (7 días postvacunación) con una duración de 21 días postvacunación, lo que permite cubrir el período más crítico de la DPD1
Un estudio de eficacia en el que se realizó un desafío experimental con E. coli F4, o con E. coli F4 y/o F18 a los 3 días del destete, mostró una reducción de la gravedad y la duración de la DPD y una reducción de la excreción fecal de F4-ETEC y F18- ETEC patógenos16,17
Por ello, se vacunó a los lechones a partir de los 18 días de vida, durante la fase de lactación, para generar una inmunidad local protectora suficiente en el intestino en el momento de la aparición de los signos clínicos de la DPD.
RESULTADOS
En la Tabla 1 se resumen los resultados productivos del estudio.
La estrategia de vacunación se comparó con el enfoque terapéutico estándar en cada granja, recopilando al mismo tiempo datos sobre la ganancia media diaria (GMD), el índice de conversión (IC), la tasa de mortalidad y la incidencia del tratamiento con medicamentos antimicrobianos (TI100 = número de inyecciones individuales/ tratamiento para un total de 100 lechones durante 100 días) durante el periodo postdestete.
Las estrategias de alimentación específicas de la granja se mantuvieron, tanto en el grupo Control como en el tratado con la vacuna, con la única excepción de que la inclusión de ZnO se suspendió en ambos grupos de tratamiento. Dependiendo de la granja, se utilizaron programas de alimentación de una, dos o tres fases durante el periodo postdestete.
Granja Grupo GMD (g/día) IC (kg pienso/kg ganancia peso) Tasa de mortalidad (%) TI100 (días) 1 Control N/A N/A 6 54,7 Vacunado N/A N/A 3 15,6 2 Control 384 1,91 3,5 N/A Vacunado 390 1,81 2,6 N/A 3 Control 351 1,61 3,15 10,1 Vacunado 373 1,55 1,65 1 4 Control 358 1,88 3,31 6,3 Vacunado 420 1,83 2,3 0 5 Control 329 N/A 2,13 16,7 Vacunado 328 N/A 1,4 0 6 Control 320 N/A 4,3 22 Vacunado 318 N/A 1,9 4,4 7 Control 304 N/A 0,9 14,3 Vacunado 307 N/A 0,9 0,7 8 Control 362 1,47 3,56 10 Vacunado 378 1,49 1,67 0 9 Control N/A N/A 11,21 18,6 Vacunado N/A N/A 4,51 2,4 10 Control N/A N/A 2,05 7 Vacunado N/A N/A 1,96 0
VACUNACIÓN Nº 4 | Abril 2022 Beneficios productivos y rentabilidad de la vacunación oral de lechones para hacer frente a la DPD causada por E. coli 102
TABLA 1
Resultados productivos de diferentes estudios de campo utilizando una vacuna viva oral de E. coli F4/F18 viva no patógena, en lechones para prevenir el desarrollo clínico de la diarrea postdestete asociada a E. coli. Los datos incluidos están relacionados con el tratamiento (control vs. vacunación), la ganancia media diaria de peso (GMD, g/día), el índice de conversión (IC, kg de alimento/kg de ganancia de peso), la tasa de mortalidad (%) y la incidencia del tratamiento por 100 días en producción (TI100 , días). N/A: No aplicable cuando no se dispone de datos para ese parámetro específico.
Los lechones de los grupos tratados con la vacuna presentaron una mejora significativa en IC, la tasa de mortalidad y la TI100 en comparación con el grupo de control. La GMD mejoró ligeramente y de forma no significativa en el grupo tratado con la vacuna.
GANANCIA MEDIA DIARIA
GANANCIA MEDIA DIARIA
La GMD no fue significativamente mayor (359,29 ± 15,83 g/d; P=0,1641) en el grupo Vacunado en comparación con el grupo Control (348,14 ± 10,25 g/d) (Gráfica 1)
GRÁFICA 1
Ganancia Media Diaria (GMD; g/día) en animales Control y Vacunados de diferentes ensayos de campo utilizando una vacuna viva oral no patógena de E. coli F4/F18. Los datos no fueron estadísticamente significativos (P=0,1641).
ÍNDICE DE CONVERSIÓN
ÍNDICE DE CONVERSIÓN
El IC fue significativamente menor (1,66 ± 0,09 kg de alimento/kg de ganancia; P=0,0164) en el grupo Vacunado en comparación con el grupo Control (1,72 ± 0,10 kg de alimento/kg de ganancia) (Gráfica 2)
Esta mejora de 0,06 en el rendimiento de los lechones supuso una ventaja económica aproximada de unos 3,7 céntimos de €/kg de ganancia o 1,05 kg menos de pienso/lechón para la misma ganancia de peso tras el destete.
MORTALIDAD MORTALIDAD
La tasa de mortalidad fue significativamente menor (2,33 ± 0,42 %; P=0,0083) en el grupo Vacunado en comparación con el grupo de control (5,43 ± 1,39 %) (Gráfica 3).
GRÁFICA 2
Índice de conversión (IC; kg de alimento/kg de ganancia de peso) en animales Control y Vacunados de diferentes ensayos de campo utilizando una vacuna viva oral no patógena de E. coli F4/F18. Los datos fueron estadísticamente significativos (P=0,0164).
Teniendo en cuenta que el coste de la alimentación es uno de los aspectos más importantes en la producción, esto puede tener un impacto significativo en los ingresos netos de la granja durante la fase postdestete.
GRÁFICA 3
Tasa de mortalidad (%) en animales Control y Vacunados de diferentes ensayos de campo utilizando una vacuna viva oral no patógena contra E. coli F4/F18. Los datos fueron estadísticamente significativos (P = 0,0083).
8 7 6 5 4 3 2 1 0 Control Vacuna Grupo de tratamiento Tasa de mortalidad (%) 5,43 2,33 1.9 1.8 1.7 1.6 1.5 1.4 370 360 350 340 330 320 310 300 Control Control Vacuna Vacuna Grupo de tratamiento Grupo de tratamiento IC (kg de alimento/kg ganancia de peso) GMD (g/día) 1,73 348,14 359,29 1,66 PATOLOGÍA 103
CONCLUSIÓN INCIDENCIA DE TRATAMIENTO INCIDENCIA DE TRATAMIENTO GRÁFICA 4
La T100 fue significativamente menor (2,68 ± 1,69 días; P=0,0009) en el grupo Vacunado en comparación con el grupo Control (17,74 ± 4,95) (Gráfica 4).
Incidencia del tratamiento 100 (TI100; número de días de tratamiento por cada 100 días de producción) en animales Control y Vacunados de diferentes ensayos de campo utilizando una vacuna viva oral no patógena de E. coli F4/ F18. Los datos fueron estadísticamente significativos (P=0,0009).
El presente estudio demuestra la eficacia de una vacuna viva oral no patógena de E. coli F4/F18 (Coliprotec® F4/F8; Elanco Animal Health) para la inmunización activa de lechones frente a la DPD asociada a E. coli F4-ETEC y/o F18-ETEC en condiciones de campo.
Para varios parámetros productivos económicamente importantes, como el IC, la tasa de mortalidad y la TI100, la vacunación frente a E. coli resultó significativamente mejor en comparación con el enfoque terapéutico estándar.
Esta reducción en el uso de antimicrobianos, unido al hecho de que no hubiera un descenso en la GMD, es un logro importante porque en la práctica muchos productores y veterinarios temen que se reduzca el rendimiento de los lechones cuando se reducen o suprimen los tratamientos con antimicrobianos y se sustituyen por tratamientos individuales.
Teniendo en cuenta las recientes decisiones del Parlamento Europeo y del Consejo (Reglamento 2019/6 de 11 de diciembre de 201818), la reducción del uso de antimicrobianos es un tema candente en la Unión Europea.
El presente estudio demostró claramente que la reducción del uso de antimicrobianos, combinada con medidas preventivas adecuadas como la vacunación frente a patógenos específicos, permite mantener el mismo rendimiento de los lechones.
BIBLIOGRAFÍA
1. Fairbrother JM, Nadeau É, Gyles CL. Escherichia coli in postweaning diarrhoea in pigs: an update on bacterial types, pathogenesis, and prevention strategies. Anim Heal Res Rev. 2005; 6: 17-39.
2. Hoa NX, Kalhoro DH, Lu C. Distribution of serogroups and virulence genes of E. coli strains isolated from porcine post weaning diarrhoea in Thua Thien Hue province Vietnam. Tạp chí Công ngh Sinh h ọc. 2013; 11: 665-672.
3.Lyutskanov M. Epidemiological characteristics of post-weaning diarrhoea associated with toxin-producing Escherichia coli in large intensive pig farms. Trakia J Sci. 2011; 9: 68-73.
4. Svensmark B, Jorsal SE, Nielsen K, Willeberg P. Epidemiological studies of piglet diarrhoea in intensively managed Danish sow herds. I. Pre-weaning diarrhoea. Acta Vet Scand. 1989; 30: 43-53.
5. Svensmark B, Nielsen K, Willeberg P, Jorsal SE. Epidemiological studies of piglet diarrhoea in intensively managed Danish sow herds. II. Post-weaning diarrhoea. Acta Vet Scand. 1989; 30: 55-62.
6.Tubbs RC, Hurd HS, Dargatz D, Hill G. Preweaning morbidity and mortality in the United States swine herd. Swine Heal Prod. 1993; 1: 21-28.
La vacunación frente a la DPD asociada a E. coli F4-ETEC o F18-ETEC utilizando una vacuna viva oral no patógena de E. coli F4/F18 puede considerarse una buena alternativa para mejorar los resultados de rendimiento de los lechones tras el destete, al tiempo que se cumplen los nuevos requisitos europeos relativos al uso prudente de antimicrobianos en la producción porcina intensiva.
Artículotraducidoyadaptadode:VangroenwegheF.ImprovedPiglet PerformanceandReducedMortalityandAntimicrobialuseFollowingOral VaccinationwithaLiveNon-PathogenicEscherichiacoliF4/F18VaccineAgainst Post-WeaningDiarrhoea.AustinJInfectDis.2021;8(2):1048.(SDR00453)
7.USDA. Part II. Reference of Swine Health and Health Management in the United States, 2000. USDA:APHIS:VS, CEAH, National Animal Health Monitoring System, Fort Collins, CO. 2002.
8.Zhang W, Zhao M, Ruesch L, Omot A, Francis D. Prevalence of virulence genes in Escherichia coli strains recently isolated from young pigs with diarrhoea in the US. Vet Microbiol. 2007; 123: 145-152.
9.Luppi A, Gibellini M, Gin T, Vangroenweghe F, Vandenbroucke V, Bauerfeind R, et al. Prevalence of virulence factors in enterotoxigenic Escherichia coli isolated from pigs with post-weaning diarrhoea in Europe. Porcine Health Manag. 2016; 2: 20-25.
10. Vangroenweghe F, Luppi A, Thas O. Prevalence of enterotoxigenic Escherichia coli pathotypes and virotypes isolated from piglets suffering from post-weaning diarrhea in Belgium and the Netherlands. Arch Vet Anim Sci. 2020; 2: 1-8.
11. Fairbrother JM, Gyles CL. Chapter 53: Colibacillosis.
In: Diseases of Swine. 10th Edition. Eds. Zimmerman JJ, Karriker LA, Ramirez A, Schwartz KJ, Stevenson GW. Wiley-Blackwell. 2012; 723-749.
12.Chen X, Gao S, Jiao X, Liu XF. Prevalence of serogroups and virulence factors of Escherichia coli strains isolated from pigs with postweaning diarrhoea in eastern China. Vet Microbiol. 2004; 103: 13-20.
13.Frydendahl K. Prevalence of serogroups and virulence genes in Escherichia coli associated with postweaning diarrhoea and edema disease in pigs and a comparison of diagnostic approaches. Vet Microbiol. 2002; 85: 169-182.
14. Vu-Khac H, Holoda E, Pilipcinec E, Blanco M, Blanco JE, Mora A, et al. Serotypes, virulence genes, and PFGE profiles of Escherichia coli isolated from pigs with postweaning diarrhoea in Slovakia. BMC Vet Res. 2006; 2:13-20.
15. Melkebeek V, Goddeeris BM, Cox E. ETEC vaccination in pigs. Vet Immunol Immunopathol. 2013; 152: 37-42.
16.Fairbrother JM, Nadeau E, Bélanger L, Tremblay C-L, Tremblay D, Brunelle M, et al. Immunogenicity and protective efficacy of a single-dose live nonpathogenic Escherichia coli oral vaccine against F4-positive enterotoxigenic Escherichia coli challenge in pigs. Vaccine. 2017; 35: 353-360.
17.Nadeau E, Fairbrother JM, Zentek J, Bélanger L, Tremblay D, Tremblay C-L, et al. Efficacy of a single oral dose of a live bivalent E. coli vaccine against post-weaning diarrhoea due to F4 and F18-positive enterotoxigenic E. coli. Vet J. 2017; 226: 32-39.
18. Regulation (EU) 2019/6 of the European Parliament and of the Council of 11 December 2018 on veterinary medicinal products and repealing Directive 2001/82/EC. Official Journal of the European Union L. 4/43.
24 22 20 18 16 14 12 10 8 6 4 2 0 Control Vacuna Grupo de tratamiento TI 100 (días) 17,74 2,68 VACUNACIÓN 104 Nº 4 | Abril 2022 Vacunación oral frente a E.coli ETEC


Trabajamos por la seguridad de los animales

Yo uso antibióticos
Yo soy responsable
Uso Betaline

La gama de antibióticos betalactámicos de Laboratorios Syva que ofrece soluciones a las principales enfermedades bacterianas en animales de producción a través de tratamientos individualizados.

Sofía Lázaro Gaspar y Gema Chacón Pérez EXOPOL SL
Sofía Lázaro Gaspar y Gema Chacón Pérez EXOPOL SL


















































